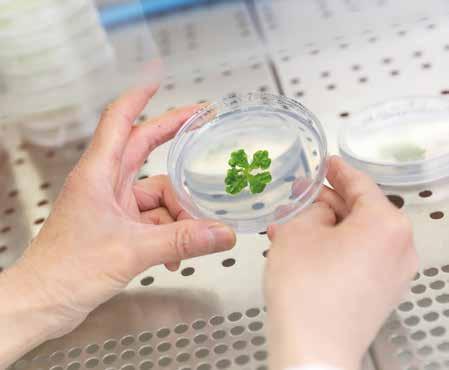

RESEARCH AND INNOVATION CENTRE
2019/2022
AGROSYSTEMS AND BIOECONOMY FOOD AND NUTRITION
BIODIVERSITY, ECOLOGY AND ENVIRONMENT COMPUTATIONAL BIOLOGY

AGROSYSTEMS AND BIOECONOMY FOOD AND NUTRITION BIODIVERSITY, ECOLOGY AND ENVIRONMENT COMPUTATIONAL BIOLOGY 2019/2022 RESEARCH AND INNOVATION
CENTRE
EDITORIAL BOARD
Claudio Donati, Cristina Castellani, Emanuele Eccel, Floriana Marin, Fulvio Mattivi, Heidi C. Hauffe, Luana Bontempo, Mario Pezzotti, Michela Troggio
EDITORS
Cristina Castellani, Emanuele Eccel, Floriana Marin
EDITORIAL PROJECT AND DESIGN
IDESIA - www.idesia.it
ISSN 2282 - 1341
© 2023, Fondazione Edmund Mach
Via Edmund Mach 1, 38098 San Michele all’Adige (Trento) www.fmach.it
3 TABLE OF CONTENTS TABLE OF CONTENTS The Research and Innovation Centre 6 Experimentation at the Research and Innovation Centre 8 PhD Programme 12 The FEM COVID Laboratory 13 AGROSYSTEMS AND BIOECONOMY 15 How I defend myself: searching for grapevine defence genes against its main fungal diseases 16 The most advanced technologies for tomorrow’s agriculture 17 VESPUCCI's transcriptomics to reconstruct gene regulation networks in grapevine 19 Employing CRISPR/Cas9-FLP/FRT technology to make apple cultivars less susceptible to bacterial fire blight 20 New Genomic Techniques (NGT) to boost resilience of grapevine to climate change 21 Project ScaldCold: a multidisciplinary approach to shed light on the apple superficial scald regulation 23 The first European chestnut (C. sativa) genome and development of an Axiom array 24 From the genome to the finding of a new local variety of walnut 25 Cloning and functional characterization of a major apple-scab- resistant gene 27 Genetic diversity and olive production in the Garda Trentino groves 28 Grapevine somatic variants provide new insights into the success of a cultivar 29 Extensive investigation of grapevine susceptibility genes to obtain resistance to pathogens 30 Black rot resistance of leaves and bunches is based on different mechanisms 31 Resistant varieties registered in the National Register of Italian Wine Grape Varieties 33 Micropropagation of Vaccinium for breeding and germplasm conservation purposes at FEM 34 Improving blueberry quality and shelf life by precise postharvest management 35 Blueberry and raspberry breeding: new varieties at FEM 37 Apple and the sleeping beauty fairytale: identified the gene controlling bud dormancy 38 SIRNACIDE project: a novel RNAi-based pesticide against grapevine downy mildew 40 Applied biotremology: eco-friendly solutions for agricultural pest control 41 Invasive alien species and biocontrol 42 Sustainable crop protection strategies 43 Plant-microbe interactions and plant bio-stimulation 45 Smart vineyard and lab 46 A mini-phenological station 47 DigiAgriApp, a digital solution for field monitoring 48 A new approach for calculating thermal indices of water stress 49 Interaction between organic matter and fertilizers to improve soil fertility 51 Hydrochar and Co-Compost from biomass exploitation: new strategies for enhancing agronomic properties 52 From waste to resources: quantification of Trentino agri-food residues to produce renewable energy 54 FOOD AND NUTRITION 57 Elucidation of biosynthesis and physiological function of dihydrochalcones using apple chemodiversity 58 The Trentingrana as a case of winning biodiversity 59 Metabolomic and sensorial biodiversity of Italian red and white wines 60 Association between the indole pathway of tryptophan metabolism and subclinical depressive symptoms in obesity: a preliminary study 62
4 Quantification of urinary phenyl-γ-valerolactones and related valeric acids in human urine on consumption of apples 63 The wine is naked: flint glass bottle causes wine aroma identity degradation 65 Direct Injection Mass Spectrometry as a Green and High-Throughput Tool for the Monitoring of Fermentation and Bio-processes 66 Systematic Innovations for a SusTainable reduction of the EuRopean food waStage 67 Linking food preferences of Italians to physiological and psychological factors: evidence from population-based studies 69 Dynamic methods to study the evolution of sensory perception during the tasting of extra virgin olive oil in combination with other food 70 Multidimensional natal isotope niche reflects migratory patterns in birds 71 Cheese and superfoods: enrichment of caciotta-like cheeses with cornelian cherries and black currants to obtain cheeses enriched in polyphenols 72 Extra virgin olive oil isotopic fingerprint 73 PROMEDLIFE: Novel food products for the PROmotion of MEDiterranean LIFEstyle and healthy diet 74 BIODIVERSITY, ECOLOGY AND ENVIRONMENT 77 Ice is not just ice - quality changes due to climate evolution 78 White-clawed crayfish management in Trentino: an integrated ecological approach 79 A new alien species in the waters of Lake Garda: first report of Dreissena bugensis (quagga mussel) in Italy 80 Potentials and challenges of permafrost dependent Alpine water resources 82 The aerobiological monitoring for the survey of invasive species: the case study of mugwort 83 High-elevation pollen 84 Foresta 4.0 86 The HIGHLANDER project 87 Ancient carbon and greenhouse gas emissions from the permafrost of the Siberian tundra 88 G-BiKE and COP-15 89 An eDNA-based protocol for monitoring amphibian species and genetic diversity 91 MarmoGen: a scientific collaborative project supporting conservation and management of marble trout 92 The MICROVALU project: evaluating microbiodiversity in alpine pastures 94 Wolbachia evolution: exploring the bacterial infection most widespread across the insect world 96 High throughput phenotyping highlights inter- and intra- specific variation in Arundo for water stress tolerance 97 A possible mechanism for reducing heavy metal accumulation in crops discovered thanks a remote wild relative 98 New elements towards understanding the role of isoprene emission in plant tolerance to environmental stresses 100 Bryophytes as emerging models of heavy metal accumulation, tolerance and detoxification mechanisms in plants 101 Memory drives the foraging behaviour of large wild mammals 103 Ecological connectivity in the Alpine anthropic matrix. Natural reserves and corridors for the conservation of brown bear in the Alps 104 UNGULALPS project - An analysis of trophic relationships in an Alpine Ecosystem 105 The tiger mosquito in Trentino: climate is no longer an obstacle! 107
5 TABLE OF CONTENTS The gut microbiota of invasive species may indicate invasion capabilities and identify new biological control methods 108 Small mammals in a changing world 109 Climate changes and emerging diseases: the case of tick-borne encephalitis (TBE) in Europe 110 COMPUTATIONAL BIOLOGY 113 Metagenomics identifies previously unknown ancient bacterial lineages 114 VESPUCCI: an ever-expanding transcriptomic resource for grapevine 116 Bacterial and fungal communities in the soil are regulated by distinct ecological processes that are stable through time 117 Nanopores at the DNA sequencing facility 118
The Research and Innovation Centre
For two years now, I have been the Scientific Director of the Research and Innovation Center (CRI) of the Edmund Mach Foundation (FEM). After a long academic career, I felt that managerial experience in a large research center could be an appealing commitment, of which I felt was within my comfort zone. I never thought the task would be simple, but I was never even fully aware of the significant focus and dedication needed to manage the structural complexity of FEM, the sheer skill present in CRI, or the multitude of scientific issues addressed. It is therefore not only a great personal challenge, but above all an institutional one. In 2024, FEM will be 150 years old. Over time it has acquired renowned scientific relevance that goes beyond not only provincial or national borders but also intercontinental ones. Maintaining this high profile is certainly a difficult task, and is only possible when strategically pursuing the excellence and efficiency of skills and organization within the Centre.
CRI studies and promotes ecological transition, to identify more balanced and harmonious models of natural and agricultural ecosystem development. It favors biodiversity conser-

vation and protection, in order to reduce environmental impact, improve energy efficiency and sustainable use of resources.
The research, carried out with cutting-edge instruments and technologies, generates “big data” which is processed using mathematical methods, statistical and IT techniques, with the aim of a holistic understanding of biological systems.
CRI develops, designs, uses and incorporates technology and digital tools to monitor and deepen the knowledge of natural and agricultural ecosystems, guiding the evolution of agricultural systems for the purpose of sustainability.

The research focused on the study of agriculture, biodiversity and natural resources, aims to promote sustainable use of resources, improve food quality and contribute to food security. We are also committed to raising awareness in key issues such as climate change impact and flora/fauna conservation.
The main objective is to develop an interdisciplinary approach to manage a “mankind-animal-agricultural/natural environment” system as an integrated and interconnected unicum in order to improve global health.
6
PROF. MARIO PEZZOTTI
Although CRI’s commitment is more directed to scientific research and innovation development, let us not forget the social role of knowledge dissemination and the much needed awareness-raising of current important challenges. These are of environmental, forestry and agricultural in nature, commencing from those within the Trentino area.
CRI is in constant collaboration with public bodies, private companies and non-profit organizations, in order to develop innovative solutions to respond to global environmental challenges while also providing technical and training support. Thanks to skills and experience acquired over the years, we are able to provide

solutions suitable to all our partners’ needs, ranging from individual farmers to large companies.
In summary, CRI represents a local, national and international point of reference for all concerned. It is developing the knowledge aimed to create and promote sustainable agricultural and food practices, based on the enrichment of territories, as well as the protection of environment and biodiversity.
This report was drawn up 4 years after the last printing with the aim of representing, in a contained editorial format, only some of the many activities developed from 2018 to 2022 within the twenty-one Research Units that make up the CRI.
7
Experimentation at the Research and Innovation Centre

Dozens of researchers have worked at San Michele all’Adige over the course of 150 years, proving themselves capable of responding to the needs of their time and promoting the development of Trentino, often anticipating future developments at national and international level. Approaches today considered to be well-established are the product
The environment
Alvise Vittori (1932-2018) was a great ichthyologist, limnologist and ecologist, characterised by his practical attitude, optimism, intuition and vision. His interests were clear from his student days, and he graduated in Forestry Science in Florence with a thesis on ichthyology. From 1972 he worked at the Agrarian and Forestry Experimentation Station in San Michele all’Adige, first as head of the Hydrobiology Section and then as Director, overseeing the transition to the Edmund Mach Foundation, where he was Coordinator of the new Department of Natural and Environmental Resources from 1994 to 1997. His professional interests ranged from fisheries and the monitoring of lakes


of innovative and cutting edge research, conceived and implemented by visionary people, leading to concrete and lasting results, and laying the cultural and scientific foundations for our society. We would like to mention a few of these people, focusing on one in each of our traditional sectors: the environment, food and agriculture.
and streams to the restoration of natural habitats.
His projects, which were very innovative at the time, were fundamental for practices today common in Italy. Starting in 1973, he initiated limnological monitoring of the main Trentino lakes, issuing pioneering publications. He was responsible for projects to restore lakes in Trentino, in particular Lakes Caldonazzo and Lases. In the early 1980s, Vittori initiated the ecological mapping of watercourses using macro-invertebrates as monitoring tools, and promoted the systematic use of biological indicators to assess the ecological status of water bodies, something which he managed to promote and teach
8
PROF. FULVIO MATTIVI
effectively at national level. He was also behind the pioneering adoption of the first Fisheries Management Plan (Carta Ittica) in Italy, in 1983. He founded the Experimental Fish Farm at the Edmund Mach Foundation. He had the foresight to implement one of the first examples of solving water pollution caused by civil and industrial discharge and hydroelectric withdrawal in Italy at the ‘Alla Rupe’ biotope in 1997, restoring the quality of aquatic ecosystems through phytodepuration in natural wetlands. His legacy is still alive, carried on by his school, in many ways helping to shape applied limnology in Italy. “The effectiveness of purification, which is at its maximum during the vegetative

Food
Franco Defrancesco (1926-2008). A graduate in Chemistry from Bologna in 1950, he arrived at San Michele in 1958 to reorganise the Chemistry Laboratory, commissioned by the newly appointed President Bruno Kessler. Defrancesco was a straightforward, determined and rigorous individual. He was a great teacher and the first person to provide a scientific basis for the production of Grappa Trentina. His insight led him to understand the need to collect the ‘heart’ of the distillate, eliminating the head, rich in ethyl acetate, and the tail,
period, decreases in winter, but remains significant and can amply justify the preference given - in this context - to this purification system over any other known system, especially if one considers the construction and above all maintenance costs, which are really low. Over and beyond the analytical reports, the fact that anyone can directly perceive with their senses the improvement in water quality from the decrease in turbidity, the disappearance of the sewer smell, and the increase in plants and amphibian and fish settlements when heading downstream to inspect the lagoon is not to be underestimated.” (From the conclusions of research on the effects of phytodepuration at the Alla Rupe biotope, 1999).
which contaminates the distillate with acetic acid and other high-boiling compounds. He was the first to carry out experiments to acidify grape marc before ensilage, to preserve it from bacterial alteration and prevent excessive methanol formation. These studies were then continued and perfected by Dr. Giuseppe Versini, who supported the collective growth of Grappa Trentina, promoting a vocation for finesse that has remained and continues to this day. Defrancesco, together with winemaker Riccardo Zanetti, developed the
9
Castel San Michele red wine, presented on the occasion of the 90th anniversary of the Institute’s foundation, paving the way for the production of the full-bodied red wine blends in Trentino that are still renowned today.
Above all, Defrancesco carried out major expansion of the testing laboratory, equipping it with the best scientific instruments of the time, also receiving funding from important Italian Ministers of Agriculture, such as Mario Ferrari Aggradi. This gave rise to a generation of chemists and technicians capable of dealing with the full range of agrifood products. The laboratory could handle all the main bromatological analyses of foodstuffs, from inorganic fraction, sugars, vitamins, polyphenols, lipids, higher alcohols and so on, to radiocarbon analysis. This was the era of nuclear testing and 14C measurement was invaluable in detecting fraud. The lab quickly became a reference point for analysis of exports and was also the regional headquarters of the Fraud Repression Service. The Association of Italian Oenologists awarded him the prestigious ‘Grappolo d’oro’ (Golden Bunch) prize. He later directed the Hygiene Labo-
Agricolture
Rebo Rigotti (1891-1971) Rebo Rigotti’s work played a decisive role in Trentino in the period between and after the two World Wars. In addition to managing the “Navicello” vine and apple nurseries from the early 1930s, from 1936 he took up a position at the Experimental Station as assistant to the director Enrico Avanzi. The latter was a great agronomist who later became Dean of Agronomy and then Rector of the University of Pisa. Avanzi selected him as “a technician of uncommon value, who the Experimental Station can use to the certain advantage of the complex genetic experimentation taking place at the Institute”. He is remembered by one of his close coworkers, Ferdinando Tonon, as a pragmatic researcher who pursued his objectives in a matter-of-fact
ratory in Trento, inspiring the fundamentally important Law 47 of 1978 on protecting the environment from pollution, also lecturing at the University of Trento. He had a theatrical ability to disseminate knowledge through scientific reasoning, combining critical spirit with great irony. He could edit a scientific column in the monthly magazine of Confindustria (the Italian industrialists’ association), while holding courses at many universities, including Cuba, called upon by Fidel Castro. He always maintained close relations with San Michele, also contributing to its development as a board member (1991-1996).
“What do we eat? Whatever the billboards advise us to eat, whatever TV ads suggest, whatever the extraordinary diets in magazines dedicated to the fairer sex tell us.... diets which the less fair sex are obliged willy-nilly to adapt to” .....
“Personally, I hate and combat any form of food propaganda unless it is aimed at raising awareness of the essence of the food , its properties and ... also its costs.”.... “If apples are healthy, and they are, let’s encourage everyone to eat them” (F. Defrancesco, La mela nell’alimentazione, Economia Trentina, 1976).
manner. He was serious, demanding, taciturn, at times even surly. This was the era of autocratic government, war and deep crisis that placed the very existence of the Institute at risk. Yet it was also a fertile period in terms of experimentation and teaching, which Rigotti himself described as a time when “abandoned to ourselves, the manpower shortage forced us to personally turn our hands to the plough, hoe, and scythe, in order to save precious and very interesting material”. It was also a time of solitude. In the immediate postwar period, the Experimental Station had only two employees, Rigotti and Franceschi.
Until 1959, Rigotti dealt with fruit and cereal farming, the production of forage, the genetics of the po-
10
tato, horticulture and even animal husbandry. Generations of farmers were trained using his Agricultural Handbook (Manuale di Agraria per la cultura popolare), which summarised the experience gained in twelve years of lectures. Besides being a great communicator, he was also a very talented artist and his works were accompanied by effective drawings and valuable paintings. Today, he is remembered above all as a geneticist, especially in the field of viticulture, having generated great wine grape varieties, particularly Rebo (a red Trentino DOC wine, along with the Reboro straw wine version) and the Gold Traminer white wine variety. We owe 30 years of vine growing knowledge to Rigotti. His publication "Statistical Surveys and Considerations on Viticulture in Trentino" (Rilievi statistici e considerazioni sulla Viticoltura Trentina), released in 1932, is a detailed analysis of viticulture in Trentino in the two-year period 1929-1930, in which he reports on the main events and problems, the distribution of viticulture and vine varieties throughout the area, the costs of post-Phylloxera recovery and for the wine production chain, all with great methodological, rational and Cartesian rigour. One of the most challenging projects carried out by Rigotti was the Viticultural Map of Trentino, published on the basis of studies conducted in 1950-52 on the initiative of the provincial Wine-growing Committee.
A detailed picture of vine-growing and wine-production in Trentino, it was the forerunner of the vineyard register. The Viticultural Map is an extensive collection of documents (qualitative-quantitative statistical information sheets, thematic maps, descriptive texts and summaries), which has been preserved, digitized and is now freely available online (https:// cartaviticola.fmach.it). According to Rigotti, it responded to the need ‘to reduce the number of grape varieties by choosing those most suitable for improving production in the light of international and national trade trends, and to standardise the planting of entire areas and terroirs, in order to obtain typical, characteristic, constant wines’. It was the first sign of a systematic search for quality for post-WW2 regional viticulture.

Focusing on his work and family, Rigotti shunned recognition. It is reported by his biographers that he even refused an honorary degree for his scientific merits. His memory is still alive, as many of his valuable works are preserved and available for consultation in the Mach Foundation Library, and detailed treatises have been dedicated to his work.

“Agriculture progresses above all by virtue of knowledge. Wherever you find real improvement, alongside you will always find the man, namely the mind that determined it.” (R. Rigotti, quotation from Mancini, in the opening of his Agricultural Handbook, 2nd edition, 1942, p. 7).

11
PhD Programme
Fondazione Edmund Mach promotes a training programme offering young researchers the opportunity to develop and deepen their scientific skills in the fields of interest of Fondazione Edmund Mach: Agrosystems and bioeconomy, Biodiversity, ecology and environment, Food and nutrition, Computational Biology. PhD students are encouraged to carry out research activities in laboratories equipped with cutting-edge machines and instruments, supervised by highly qualified scientists.
The tutoring programme helps to develop an educational relationship with the tutor, benefitting from his experience and the collaboration with the international network of centres and universities in the world. The PhD programme allows students to customize their training, including a variety of educational activities, seminars, workshops and summer schools on various topics such as molecular biology, genomics, nutrition, management of natural resources, sustainable agriculture and the integrated management of agrifood system.
To activate new networks, FEM stipulates agreements with national and international research Institutions aimed at funding joint PhD projects. Since 2010 the Centre of Innova-

tion and Research has activated 240 scholarships, creating a solid network of international collaboration with prestigious Institutes in the academic world and with Italian and foreign private companies. The participation of companies in the funding of scholarships and the willingness to host the PhD students favor the exchange between the public and private sectors in the field of research and international mobility.
The training experience at partner Institutions in Italy and abroad contributes to the enrichment of the portfolio of skills and competences and provides the PhD student with a competitive business card to access job opportunities in Italy and in the world. The success of the PhD program is confirmed by the employment rate of PhD students: 80% of scholarship holders have found employment in prestigious institutions both in the academic field and in the private sector. New PhDs have access to important job opportunities upon graduation or, for some of them, even before completing their studies. The PhD programme is a challenging and enriching training opportunity, preparing PhD students to become future leaders of scientific and technological research in the agri-food and environmental field.
12
ELISABETTA PERINI
Photo of Umberto Salvagnin
The FEM COVID Laboratory
In the days following the discovery of the new SARS-CoV-2 coronavirus, the most prestigious international laboratories identified a reliable method for detecting the virus in humans (immediately made available online), using extraction of the RNA virus from a nasopharyngeal swab and the amplification of a specific viral gene. The Microbiology and Virology Laboratory of the S. Chiara Hospital immediately tested and validated the diagnostic method, which was then automated (with our expertise) for testing thousands of swabs per day. Soon after, as in many European research laboratories, at the beginning of April 2020, the FEM technicians, technologists and researchers rolled up their sleeves to set up a new laboratory. Using the most sophisticated equipment borrowed from the various CRI laboratories, we carried out the molecular analyses of swabs using exactly the same method, certified by the S. Chiara Hospital.
The FEM COVID Laboratory was placed in a container away from other laboratories and offices, and organized following all the precautions and advice of European diagnostic laboratories, in compliance with high safety standards. After an initial phase of optimization of the workflow, completed by some of our youngest technicians who proved to be particularly willing and determined, led to the completion of the laboratory in just a few days. Then followed the race to find PPE and large volumes of kits and consumables required by the protocol, requiring the FEM administration to address the dramatic shortage of products on the market.
The enthusiasm of FEM colleagues was phenomenal: more than 40 researchers, technologists and technicians made themselves available to be trained and involved in the operational phases. With eight-hour daily shifts, starting from the arrival


of inactivated (therefore non-contagious) swabs by courier every morning, we had 24 hours to provide the results to the local Health Agency. In the first phase (from approximately 7.00 to 15.00), viral RNA was extracted from the biological material contained in each swab using two automatic extractors. The elutions (i.e. the extracted RNA) were then delivered to the Sequencing and Genotyping Platform for the second phase of the protocol, i.e. the delicate operation of identifying the S gene (spike) of the SARS-CoV-2 virus (a phase which ended around 22.00). The results were then sent to the S. Chiara Hospital (around midnight) where they were validated by the medical director and sent to the Ministry of Health in Rome by 9 am the following morning.
In total, FEM analyzed 214,632 swabs for Trentino, with most coming from the provincial retirement homes. Despite initial organizational and logistical difficulties of this complex collaboration, the experience highlighted the scientific and social potential of CRI, as well as the capacity of staff to adapt skills and knowledge in the face of a global pandemic, giving a rapid and concrete contribution during this extraordinary event.
13
HEIDI C. HAUFFE MASSIMO PINDO IN COLLABORATION WITH MORE THAN 40 CRI COLLEAGUES
Molecular analysis of swabs (from left): RNA extraction, genotyping

AGROSYSTEMS AND BIOECONOMY

MIKIAS
JENNA JOLIFFE
JORGE LAGREZE
GIULIA MALACARNE
SUSANNA MICHELI
CLAUDIO MOSER
STEFANIA PILATI
CARLOTTA PIRRELLO
BARBARA ROJAS
How I defend myself: searching for grapevine defence genes against its main fungal diseases

Plants have evolved defence mechanisms and barriers to protect themselves against pathogens and environmental stresses. The outermost structures such as the cuticle, the cell wall and the plasma membrane act both as a mechanical barrier and as pathogen sensors, triggering a molecular response to fight the infection. For years we have been studying the defence mechanisms of the vine against pathogens in order to identify the genes involved, as they represent a key knowledge to assist both conventional breeding, and the New Genomic Techniques, such as gene editing. The outermost layer of the aerial plant organs, the cuticle, is composed by waxes and a dense mesh of cutin that helps protecting against excessive dehydration and solar ra-
diation, and hinders the penetration of fungi, especially in soft fruits after harvesting. Given the importance of the cuticle, we are studying regulatory genes of cutin and wax syntheses, so far characterized only in model plants. To find novel defence strategies against Botrytis cinerea, the agent of bunch rot, we focus on genes encoding Pectin Methylesterases (PMEs) and Pectate Lyases (PLs). These enzymes are involved in berry softening during ripening. This process, combined with the accumulation of sugars, renders berries particularly susceptible to rot. PME and PL genes are molecular targets whose specific inactivation by gene editing may protect from the fungal infection. Once invading pathogens overcome the cell wall, they are perceived by
16
LISA GIACOMELLI
D. GUCHE
the plasma membrane, by receptors and through chemical modifications of its lipids, which induce local and systemic defence responses followed by a cascade of events. Among these is the peroxidation of membrane lipids catalysed by a lipoxygenase (LOX), which generates oxylipins, including jasmonate–a hormone involved in the defence response. Recently, we identified LOX isoforms in grapevines, studied their activity in vitro, and obtained plants in which LOX genes were either inactivated or overexpressed. These plants are being evaluated for their degree of
tolerance to powdery mildew. The hormone salicylic acid (SA) is also involved in the plant defence response. Its concentration in the cell is finely tuned by the action of enzymes like those encoded by Downy Mildew resistance 6 (DMR6) genes. Inactivation of DMR6 genes causes SA accumulation in various species, rendering the plants more resistant to various pathogens. We have been studying the grapevine DMR6 genes for some years and we obtained DMR6 edited plants. Preliminary tests indicate that these plants are less susceptible to downy mildew.
More info on Biomolecules (2022), 12 (2): 182. https://doi.org/10.3390/biom12020182
KEYWORDS: defence genes, fungal diseases
SPECIES: Vitis vinifera
The most advanced technologies for tomorrow’s agriculture

Science and technology have always been deeply linked: the development of Technology allows Science to answer new questions, while Science itself is the foundation for new technological developments. Among the newest techniques that we are devel-

oping at Edmund Mach Foundation, and that will have a strong impact on our research, there are gene editing and microfluidics.
Gene editing allows the introduction of small mutations at specific points in the genome of the species of inter-
17 AGROSYSTEMS AND BIOECONOMY
UMBERTO SALVAGNIN LISA GIACOMELLI TOBIAS WEIL CLAUDIO MOSER
est – grapevine in our case - without altering the rest of the plant’s genetic material, thus maintaining its original genotype.
We apply gene editing to introduce mutations that switch off genes that, if active in the plant, allow or facilitate infection by pathogenic fungi. These genes are called susceptibility genes, and their inactivation can lead to tolerance or resistance to the pathogen. In other words, it’s like altering the lock of a door so that the key can no longer open it. To introduce the mutations, it is necessary to provide the cells with the CRISPR/Cas complex, composed of the Cas9 protein and the guide RNA. Usually, this is done by inserting the genes encoding the complex into the plant.
In our laboratory we developed an alternative method that does not require the use of exogenous DNA: instead, it involves the insertion of the protein-RNA complex directly into the plant. This complex is quickly degraded after making the desired mutations, but its delivery requires working with plant cells from which the cell wall has been removed (protoplasts) and then regenerating an entire plant from these single cells.
The first edited grapevine plants obtained with this technique are now in the greenhouse and they will be tested in the coming months to see if they have lost their “susceptibility”. Microfluidics is the science of manipulating and controlling ultra-small volumes of liquids in chambers and channels with dimensions on the microscale, better known as “lab-ona-chip” because multiple laboratory techniques are integrated into a miniaturised device of a few centimetres. This field of research has seen very rapid developments in recent years, particularly in the biomedical sector, as it allows the reconstruction of tissues and organs for physiological analysis or drug testing. Moreover, the enormous flexibility of microfluidics platforms allows the various applications to be extended to other disciplines outside of medicine, such as plant cell biology, molecular biology, the study of plant-microorganism interactions, nutrition, microbial ecology, biotechnology, and agricultural chemistry, all disciplines of strong interest for the FEM. For this reason, a microfluidics and microscopy platform has recently been activated at FEM, paving the way for new research opportunities.

More info on Frontiers in Plant Science (2022) 13: 1078931.

https://doi.org/10.3389/fpls.2022.1078931
KEYWORDS: gene editing, microfluidics
18
VESPUCCI's transcriptomics to reconstruct gene regulation networks in grapevine
In the last two decades, gene expression profiling during plant response to different environmental conditions, such as extreme temperature, drought stress, pathogen attack, and during plant development from the vegetative to the mature phase has produced a plethora of genome-wide experiments (characterising the expression of all genes in the genome), generating a huge amount of data. This has prompted the need for the development of bioinformatic tools to re-elaborate the data and make them more useful to the researchers in the field.

Thanks to the collaboration between the Computational Biology and the Plant Biology and Physiology units of Edmund Mach Foundation, a data compendium named VESPUCCI has been developed, which allows a real ‘surfing’ among the transcriptional data recovered from public databases. Depending on the query type,
one can understand how grapevine as a whole reacts to different conditions, if gene groups behave differently in similar conditions or they work in concert in seemingly different conditions. Moreover, the availability of a grapevine gene expression data compendium has paved the way to the discovery of the interactions among the genes. In particular, within a collaboration with researchers of the Information Engineering and Computer Science Dept. of the University of Trento and IMEM-CNR, a new method for the identification of causal relationships and gene network reconstruction has been developed and applied to the dataset extracted from VESPUCCI. The method has been called ‘OneGeNE’, which stands for ‘one gene network expansion’. This approach tries to identify not the single gene but rather the gene network responsible for the plant response to external or in -
19 AGROSYSTEMS AND BIOECONOMY
STEFANIA PILATI MARCO MORETTO PAOLO SONEGO LAURA COSTANTINI GIULIA MALACARNE
Example of a gene network obtained with the OneGenE method by analysing the VESPUCCI transcriptomic compendium, which highlights the interactions between the genes modulated in the grape berry to counteract the attack of the fungal pathogen
ternal stimuli. This allows the study of plant physiological traits at a higher level (system biology approach), which better catches and describes the complexity of the system. After
passing an experimental validation, the identified genes and their relationships, i.e. the gene network, can propel the grapevine breeding programmes.
More info on Biomolecules (2021) 11(12), 1744. https://doi.org/10.3390/biom11121744

KEYWORDS: regulatory gene network, transcriptomics, system biology

Employing CRISPR/Cas9-FLP/FRT technology to make apple cultivars less susceptible to bacterial fire blight


VALERIO POMPILI
VALENTINO GIAROLA
LORENZA DALLA COSTA
STEFANO PIAZZA
MICKAEL MALNOY
The main apple cultivars on the market are susceptible to fire blight caused by the bacterium Erwinia amylovora. In order to combat this pathogen, towards which phytosanitary treatments have limited efficacy, resistant cultivars have been produced by traditional breeding (e.g. ‘Rewena’), whose fruits, however, do not
qualitatively meet consumer expectations. Conventional breeding has also been exploited to insert resistance genes derived from wild genotypes into valuable varieties. However, the resistance induced by these genes has already been overcome by the bacterium undergoing a rapid evolutionary process.
20
Bunch rot visible on a Pinot noir cluster OneGeNE
A further strategy, which based on evidence in other species seems likely to be more durable than that based on resistance genes, consists in silencing plant susceptibility genes used by the pathogen to trigger infection. The DIPM and HIPM gene family appears to be exploited by E. amylovora to deactivate the plant’s defence response, effectively rendering it susceptible. Therefore, inactivation of members of this gene family appeared to us to be a promising line of research to focus on to reduce susceptibility of apple trees to this pathogen. We used Agrobacterium tumefaciens-mediated gene editing technology to implement this project. The currently most advanced tool for genetic editing is CRISPR/Cas9, a very highly efficient system deriving from bacteria and firstly applied in apple in 2016. This formidable technology has seen a remarkable diffusion in the field of plant biotechnology in recent years because it allows to easily obtain INDEL mutations in target gene sequences resulting in loss or alteration of the function of the
encoded protein. ‘Gala’ and ‘Golden Delicious’ plants edited in the DIPM4 gene with mutations proved to be significantly less susceptible to the pathogen than wild-type plants, with no pleiotropic effects on phenotype or off-target effects at the genetic level. Turning off the other members of the HIPM and DIPM and of MLO gene (oidium resistance) is currently being tested.
In parallel, we have also investigated ways to bring an innovation to the process of gene transfer via Agrobacterium, currently still the most widespread, in order to minimise as much as possible the presence of exogenous DNA in the genome of the edited plants.
The binary construct developed allows an effective removal of a T-DNA cassette of more than 10 kb. A small fragment of exogenous DNA just over a hundred bases long remained in the genome of the edited plants. This result goes in the direction of making these technologies increasingly accurate and clean as desired by citizens/consumers
More info on Plant Biotechnology Journal (2020) 18(3): 845-858. https://doi.org/10.1111/pbi.13253

KEYWORDS: fire blight, TEA, apple
SPECIES: Erwinia amylovora, Agrobacterium tumefaciens, Malus domestica
New Genomic Techniques (NGT) to boost resilience of grapevine to climate change
According to the Intergovernmental Panel on Climate Change (IPCC), an increasing number of cultivated areas will be affected in the near future by frequent drought events and heat waves that could compromise crop quality and yield. Grapevine, a perennial fruit crop of high economic value, can suffer very negative consequences if exposed to unfavourable
climatic conditions for long periods. It is therefore of primary importance to implement innovative strategies to mitigate the effects of climate change on viticulture. Here at the FEM two PhD projects are underway aimed at identifying potential genes whose modulation could favour the adaptation of the grapevine to a changing climatic scenario.
21 AGROSYSTEMS AND BIOECONOMY
LORENZA DALLA COSTA UMAR SHAHBAZ ALVARO VIDAL MICHELE FARALLI VALENTINO POLETTI MICKAEL MALNOY
A first project, “STOMALTER”, concerns the study of the VvEPFL9 or STOMAGEN gene which, according to the knowledge acquired in model plants and cereals, is considered a key positive regulator of stomatal formation. Different grapevine genotypes will be genetically modified to obtain both loss-of-function mutants (knock-out, KO) using CRISPR/Cas9 technology or overexpressing lines. The expected effects are a stomatal density reduction in KO mutants and, conversely, an increase in overexpressing lines. The morphological characterization of the stomata in the modified lines, together with the physiological measurements of gas exchanges, will allow the selection of a group of interesting lines on which to apply a series of abiotic stresses such as water stress and heat stress, also in combination with each other. In these experiments, high CO2 concentrations will also be tested in order to vary the most important environmental parameters by simulating extreme conditions.
The second project, “Grapesystres”, has the objective of systematically studying the role of ABA (abscisic acid) in regulating the grapevine defence mechanisms against the main threats caused by climate change. Furthermore, public transcriptomics data will be used to visualise tissue-specific gene co-expression networks induced by different stresses including drought and heat. These data will be used to identify those genes playing a key role in the plant response to abiotic stress. Such genes will be modified in different grapevine genotypes through the approach of knockout mediated by CRISPR/Cas9. Finally, the modified plants will be characterised for the level of resistance to abiotic stresses in field trials carried out in Chile. Furthermore, thanks to an indepth comparative analysis of the genomes of various genotypes of the Vitis genus, this study also aims to develop susceptibility or resistance markers associated with water stress.

More info on Frontiers in Plant Science (2022) 13: 878001. https://doi.org/10.3389/fpls.2022.878001
KEYWORDS: grapevine, abiotic stress, TEA SPECIES: Vitis spp.

22
Project ScaldCold: a multidisciplinary approach to shed light on the apple superficial scald regulation
Apple is subjected to long-term cold storage to preserve its quality and to ensure a year-round availability on the market. However, low temperature can trigger the development of a series of chilling injury disorders, such as superficial scald, which is manifested with the development of brown-discoloured areas on the fruit skin.
To address this issue, the Euregio project “ScaldCold” aimed to comprehensively dissect the superficial scald physiology in apple, employing several technologies, such as metabolomics, transcriptomics and NIR spectroscopy, towards the elucidation of the genetic and physiological regulation. A Systems Genetics approach targeted a core set of QTLs (Expression quantitative trait loci) related to the metabolic modification occurring during the development of this disorder and identified a sub-set of both cis and trans eQTL, that are involved in the genetic control of the gene expression pattern related to superficial scald.
These findings were consistent with the results obtained in the comparison of two apple varieties susceptible to scald disorder, ‘Granny Smith’ and ‘Ladina’, stored using different postharvest strategies, such as treatment with 1-MCP and low O2. Although these approaches effectively prevent-
ed superficial scald in ‘Granny Smith’, ‘Ladina’ displayed a reduced sensibility to the treatments, being prone to developing severe scald symptoms. In fact, in asymptomatic ‘Granny Smith’ fruit an accumulation of a specific class of metabolites, such as flavan-3-ols and unsaturated fatty was observed. These compounds might play a role in preventing scald symptoms by enhancing antioxidant activity and membrane fluidity. Whereas in symptomatic fruit, an increased level of chlorogenic acid, substrate for the polyphenol oxidase (PPO), and very long saturated fatty acids were found, highlighting the possible effect of the different genetic background on scald development.
Additionally, a comparison between ‘Granny Smith’ apples stored at low oxygen regimes for 5 and 7 months was also carried out. This revealed that the length of storage had a pivotal role in determining the transcriptional signature and metabolic re-programming, especially for the accumulation of chlorogenic acid and the increase in expression levels of phenylalanine ammonia-lyase and PPO genes.
These results revisited past concepts and disclosed the role of new mechanisms, such as the protecting role played by specific categories of fatty acids and the involvement of

23 AGROSYSTEMS AND BIOECONOMY
FRANCESCA POPULIN NICOLA BUSATTO LORENZO VITTANI URSKA VRHOVSEK FRANCO BIASIOLI FABRIZIO COSTA*
* Center Agriculture Food Environment, University of Trento, Italy
DIEGO MICHELETTI
LUCA BIANCO
STEFANO PIAZZA
CRISTIANO VERNESI
MICKAEL MALNOY
MICHELA TROGGIO
MIRKO MOSER
LUISA PALMIERI
polyphenol oxidase (PPO) in scald symptoms.
Taking together, these results can be exploited to improve the final quality
of stored fruit or to design novel molecular markers to support breeding in the selection of new varieties distinguished by superior storability.
For more information see the article published on NIR news (2020) 31 (3-4): 5-9. https://doi.org/10.1177/0960336020910056

KEYWORDS: superficial scald, post-harvest SPECIES: Malus domestica
The first European chestnut (C. sativa) genome and development of an Axiom array
Sweet chestnut (Castanea sativa) is a deciduous tree that belongs to the Fagaceae family, which is native to the temperate regions of Eurasia. This tree is known for its edible nuts, which have been an important food source in Europe for centuries, and continue to be a significant economic product, with an annual production of 240,000 tons between 2016 and
2020. The annual chestnut production in Italy is about 40,000 tons. Moreover chestnut plantations are key elements for the landscape and provide important ecosystem services.
To fully understand and enhance the genetic diversity of sweet chestnut, it is essential to conduct a thorough study of the C. sativa genome. How -

24
ever, to date, while there are published genomes of closely related species, C. mollissima, C. crenata, and C. dentata, no genomic data are available for C. sativa. In this study, we present the first chromosome-scale assembly of the sweet chestnut cultivar ‘Marrone di Chiusa Pesio’ together with the genome resequencing of more than 100 accessions of Castanea spp. for SNPs discovery. The assembly was produced using a hybrid sequencing strategy that combined a high coverage (100X) of long (Oxford Nanopore Technology) and short (Illumina) reads, paired with chromosome conformation capture (Dovetail Omni-C). All these latest-technologies have been combined to reconstruct the genomic sequences in continuous fragments called scaffolds. The total size of the assembled genome is 750.8 Mbp for a total of 238 molecules, with an N50 of 25.0 Mbp in 12 scaffolds and an N90 of 2.9 Mbp in 42 scaffolds. These scaffolds have been oriented and anchored to produce
the 12 chromosomes of chestnut using a dense genetic map derived from a cross between ‘Madonna’ and ‘Bouche de Betizac’.
To allow the study of genetic diversity within the Castanea genus 73 accessions of C. sativa, 14 of C. crenata and 19 of C. mollissima were sequenced and aligned to the newly assembled genome to identify the differences. A set of evenly spread and high-quality SNPs were selected to facilitate genetic studies in the Castanea genus. These new genomic resources for sweet chestnut provide valuable insights into its genome structure and diversity, and will be powerful tools for future research on this economically important species. They will facilitate identification of genes associated with important traits such as nut yield and quality, disease resistance, and climate adaptation. They will also aid in the breeding of new varieties with improved agronomic performance, and contribute to the conservation of genetic resources in C. sativa
KEYWORDS: genome, sequencing, chestnut array
SPECIES: Castanea sativa
From the genome to the finding of a new local variety of walnut
Juglans regia (L.) is cultivated worldwide for its nutrient-rich nuts. Due to the beneficial properties of its nutrients, walnut is a highly recommended food in the human daily diet.
Italy is among the top five importing countries of walnuts in shell, due to the strong decline in the Italian walnuts production in the early seventies combined to a constantly growing demand. Most of the imported walnuts in Italy come from the USA (50%), followed by France (20%) and Chile (14%), and a lower part also from Argentina and Australia. Nonetheless, the climate and environmental condi-
tions of the Italian peninsula are well suited to walnut cultivation, and still some local unique Italian varieties have survived.
The current context is therefore favourable to promote the development of a local high-quality Italian walnut production. In this respect, the researchers of the Fondazione Edmund Mach, in collaboration with the University of California (Davis, USA) and the Johns Hopkins University (MD, USA), took part in a project for the re-sequencing and assembly of the walnut genome and to the development of a high-density SNP array
25 AGROSYSTEMS AND BIOECONOMY
ERICA DI PIERRO LUCA BIANCO MICHELA TROGGIO
Dendrogram of 56 Italian and International walnut cultivars/accessions based on genetic distance. Branches are coloured according to the geographical origin: green = USA (most from California); pink = France; blue = China; red = Uzbekistan; black = Japan; purple = Italy, yellow = Bulgaria; violet = Afghanistan (only PI15_8)
(Axiom™ J. regia 700K). These tools can pave the way to new studies aimed at enhancing and characterising the Italian and international walnut germplasm. In particular, FEM researchers devised the project “NoBle” (co-financed by Fondazione CARITRO) for the valorization of walnut cultivation in Trentino and, more generally, in Italy. The Axiom™ J. regia 700K SNP array was used to genetically characterise local Italian accessions and varieties to better understand how they relate to one another and to the international commercial varieties. The defined genetic profiles confirmed the genetic uniqueness of the autochthonous cultivar from Trentino ‘Bleggiana’, be-
More info on Plants (2022) 11 (15): 1986. https://doi.org/10.3390/plants11151986

sides revealing the presence of a new traditional cultivar of the Trentino region, called ‘Blegette’. The information gained by using advanced tools such as the walnut genome and the SNP array could be translated into important improvements and innovations for a modern walnut production with the goal of increasing the quality of the end product. Moreover, the local varieties represent an interesting reservoir of walnut genetic diversity and quality properties, which deserve future investigation on agronomically useful traits (e.g., local adaptation and water needs) for a high-quality and sustainable production.
KEYWORDS: walnuts, genome, varietal identification
SPECIES: Juglans regia

26
Cloning and functional characterization of a major apple-scab- resistant gene
Apple scab, caused by the fungal pathogen Venturia inaequalis Cooke (Wint.), is one of the most endemic and destructive diseases of apple (Malus × domestica Borkh.) worldwide. Currently, the disease is managed by applying up to 15-20 chemical treatments per year in commercial orchards. As V. inaequalis may develop resistance to chemicals, it is important to look for new ways to control the disease. The use of resistance genes present in small-fruited wild species of apple is an attractive alternative. To date, several genomic regions containing major scab resistance genes have been identified in apple cultivars or wild relatives, but very few of them have been thoroughly studied, identifying the actual resistance gene. On linkage group 12 a locus responsible
for scab resistance was found (Rvi12). A former fine mapping analysis identified a strong candidate gene (Rvi12_ Cd5) for the Rvi12-based apple scab resistance. Therefore, Rvi12_Cd5 was used to transform the scab-susceptible apple cultivar ‘Gala’ via Agrobacterium tumefaciens-mediated transformation. Two constructs were used: the first carrying Rvi12_Cd5 under the control of a 35S promoter; the second carrying Rvi12_Cd5 under the control of its native promoter and terminator. All the transgenic lines were tested for T-DNA integration and copy number. The expression level of Rvi12_Cd5 was analysed. All the transgenic lines carrying the 35S promoter showed a high expression level of Rvi12_Cd5. Those carrying Rvi12_Cd5 under the control of its na-

27 AGROSYSTEMS AND BIOECONOMY
PAOLO BALDI AYESHA YOUSAF VALERIA GUALANDRI MATTEO KOMJANC DAVIDE BUSETTI MICHELA TROGGIO MICKAEL MALNOY
tive promoter showed considerably lower levels of expression. An artificial infection of transgenic lines using a mixed inoculum of V. inaequalis was performed in order to test scab resistance. Most of the transformed plants carrying both the 35S and the native promoter showed significant resistance to scab infection. These results indicate that Rvi12_Cd5 is the actual gene controlling scab resistance and that even a low expression level of the gene is enough to enable the recognition of the pathogen and trigger the plant response. The next
step will be to remove the foreign DNA from the transgenic lines carrying Rvi12_Cd5 under the control of its native promoter, in order to obtain scab resistant cisgenic ‘Gala’ lines. Our group is currently studying other major scab resistance genes (Rvi5; Rvi11). Moreover, the analysis of wild apple genotypes belonging to the collection of Fondazione Edmund Mach is in progress, looking for new sources of resistance. In parallel, we are developing new resistant apple cultivars carrying one or more scab resistance genes by classical breeding programs.
More info on Molecular Breeding (2018) 38, 73. https://doi.org/10.1007/s11032-018-0825-y
KEYWORDS: apple scab, resistance genes, genetic transformation

SPECIES: Malus domestica, Venturia inaequalis
Genetic diversity and olive production in the

Garda Trentino groves
The area of Lake Garda in Trentino (GT) is the northernmost part of Europe where olive is traditionally cultivated. We investigated the varietal composition of the olive trees grown
in the area through direct genotype analysis and database searching for similar genetic profiles. Results revealed the strong prevalence of the ‘Casaliva (Frantoio)’ cultivar in both old olive groves and modern orchards. The long historical link of the cultivar with the territory emerged in particular from the genetic identity of more than one hundred centuries-old trees (estimated to be between 204 and 584 years old) and the genetic identification of over-grafting cases. Analyses also revealed the sporadic presence of olive trees with different genetic profiles, some allegedly autochthonous and others matching commercial varieties or unknown. The study was enriched with the comparison of hundred olive tree accessions maintained in local collections. Olive is an anemophilous pollinated species that usually blooms copiously. Nevertheless, the profitability
28
SILVIA LORENZI PAULA MORENO SANZ FRANCO MICHELOTTI* MARIA STELLA GRANDO**
* Technology Transfer Centre, Fondazione Edmund Mach, Italy ** Center Agriculture Food Environment, University of Trento, Italy
of olive growing is limited by some physiological characteristics related to flower biology. Cultivars display various levels of self-incompatibility therefore identification and use of the most suitable pollinizers is a key point in the strategies of modern olive growing.
Given the dominant presence of a single variety in the GT, our study continued by investigating the degree of self-incompatibility of ‘Casaliva’ in order to identify possible limits to fruit set success and yield. Seed embryos were isolated from about 550 olives and through DNA analysis the varietal source of the pollen responsible for fertilisation was deduced.
More info on Genes (2020), 11 (10): 1171. https://doi.org/10.3390/genes11101171
Indeed, by combining the maternal and paternal genetic information, the genetic profile of the embryo makes it possible to discriminate self-fertilisation from outcrossing. This parentage analysis identified a low frequency of self-fertilisation in ‘Casaliva’ and revealed that the formation of olives in the GT can be traced back to pollen from the minor varieties identified in the area as well as from varieties not captured by our previous survey. Further experiments are underway to determine the best varieties to be introduced as pollen donors and whether there are suitable local varieties for this purpose.
KEYWORDS: olive, varietal identification, fertilization
SPECIES: Olea europaea
Grapevine somatic variants provide new insights into the success of a cultivar
The greatness of a grapevine variety is ascribable to its adaptability to a changing environment while warranting a high and constant yield. One of the reasons for such flexibility can be found in the reproductive process. Fruit development usually occurs after ovule fertilisation and is coordinated by hormonal signals; however, in seedless genotypes it is independent from seed formation. This opportunity is clearly favourable under adverse climatic conditions for gamete functionality and fertilisation, such as extreme temperature and humidity, which can seriously compromise viticultural production.
New intriguing insights into berry development in the absence of seeds have recently emerged from a project involving the Fondazione Edmund
Mach, the Center Agriculture Food Environment of the University of Trento and the Institute for Sustainable Plant Protection of the Research Council of Italy. In particular, somatic variants (clones) of renowned varieties like ‘Chasselas’, ‘Gouais’, ‘Moscato Bianco’ and ‘Sangiovese’ have been identified. The genetic comparison of these plant pairs and their multi-year micro- and macroscopic characterization under different pollination treatments have allowed to ascribe a specific mechanism for failed seed development to each mutant. Special emphasis has been put on the pair composed by ‘Sangiovese’ and its seedless variant locally named ‘Corinto Nero’. For this line, functional defects in pollen grains and embryo sacs have been detected, which act
* Center Agriculture Food Environment, University of Trento, Italy

29 AGROSYSTEMS AND BIOECONOMY
LAURA COSTANTINI PAULA MORENO-SANZ SILVIA LORENZI FABIANA CRISTOFOLINI ELENA GOTTARDINI MARIA STELLA GRANDO*
together in causing seedlessness. In parallel, an intrinsic tendency to develop fruits without pollen contribution has been clearly shown for both ‘Sangiovese’ and ‘Corinto Nero’. Finally, in the genetic sequences of ‘Sangiovese’ and ‘Corinto Nero’ a few single nucleotide polymorphisms have been found, which are suitable for distinguishing these clones and
for developing hypotheses on genetic functions that might be altered in the seedless line. The knowledge acquired through this project paves the way towards identifying or developing new seedless genotypes, controlling fruit formation, optimising management techniques, or elaborating treatments to make plants better adapted to climatic conditions.
More info on BMC Plant Biology (2021) 21: 135. https://doi.org/10.1186/s12870-021-02865-2

KEYWORDS: seedlessness, fruit development, clone comparison SPECIES: Vitis vinifera
Extensive investigation of grapevine susceptibility genes to obtain resistance to pathogens
One of the main purposes of modern viticulture is to reduce the amount of fungicides used each year by making use of genetic resources such as resistance genes and, more recently discovered, susceptibility genes. The
“switching off” of the latter can induce in the plant a broad-spectrum and more durable resistance than that conferred by the resistance genes. The new, and increasingly used, genome-editing techniques

30
Pollen grains subjected to the germination in vitro test, as observed at the microscope (630x)
CARLOTTA PIRRELLO LUCA BIANCO LISA GIACOMELLI CLAUDIO MOSER SILVIA VEZZULLI
can cause a mutation in specific sites of these genes, inducing their inactivation or a reduction of activity. An alternative way is to investigate naturally occurring mutations in the genes of interest, making use of the germplasm preserved in institutes around the world. Following this second investigation path, the genomic DNA of 190 individuals belonging to cultivated grapevine, wild and hybrid species was analysed for important mutations in the susceptibility genes to downy mildew: VvDMR6.1, VvDMR6.2, VvDLO1 and VvDLO2. The interest in these genes is due to their involvement in the catabolism of salicylic acid, an important phytohormone able to mediate the defence response in plants. DNA sequencing was performed with the most modern technologies that have high levels of coverage and depth, the sequences obtained were mapped on the reference genome and a bottleneck bioinformatic analysis was carried out on the observed point mutations, with the aim to identify those with the greatest impact on protein structure and function. Of the four
More info on Biomolecules (2021) 11(2): 181.

https://doi.org/10.3390/biom11020181
genes examined, in each one was observed the presence of four to six mutations capable of inhibiting the function of the protein. In particular, a predicted mutation in the VvDMR6.2 gene was associated with the downy mildew resistance trait. The study of genetic diversity has provided a large and significant amount of data that can be considered valid resources exploitable in programs for grapevine assisted genetic breeding, as integrative elements to the use of resistance genes and, in the context of a “tailored” genome editing, through the induction of the point mutations identified in the study in the target genes.
KEYWORDS: susceptibility genes, downy mildew, natural mutations
SPECIES: Vitis spp., Plasmopara viticola
Black rot resistance of leaves and bunches is based on different mechanisms
Viticulture is a multibillion-dollar market based on grapes, one of the most valuable fruits in agriculture, but it is also characterised by the highest uses of fungicides per hectare for disease management. In Europe in the last two decades the new regulations have allowed a strong reduction of fungicides, but the coincidence
with climate change, which is causing hot-rainy summers, has led to the appearance of previously controlled diseases such as black rot of grapevine, which can lead to the complete loss of the crop.
The Edmund Mach Foundation, in collaboration with the JKI-Geilweilerhof Institute, is engaged in a
Protein structure model with detected impacting variants. In blue are residues located inside the protein while in red are those more exposed on the surface

31 AGROSYSTEMS AND BIOECONOMY
PAOLA BETTINELLI DANIELA NICOLINI LAURA COSTANTINI OSCAR GIOVANNINI MARCO STEFANINI SILVIA VEZZULLI
research project, part of the cOMBi-GRApe agreement, for the fight against black rot through the introduction of genetic resistance into mildew tolerant varieties. In fact, although there are varieties derived from wild species that carry resistance to the most widespread fungal pathogens, 80% of the world’s vine area is represented by susceptible Vitis vinifera varieties. Therefore, exploiting resistance traits is a valid strategy for fungicide reduction.
First, the pedigree of resistant donors was reconstructed based on the collection of historical phenotypic data, which led to the identification of a large unexplored pool of 148 varieties belonging to 14 different species. The isolation and characterization of two strains of the pathogen present in Valsugana and the development of new, more efficient controlled infection protocols based on the production of spores from fresh infected leaves then led to the resistance evaluation of a panel of FEM parental lines and selections and the identification of six promising genotypes
readily exploited for new crosses, among which ‘Termantis’ and ‘Charvir’ have already been released. This preliminary work was prodromal to the study of the segregation of the black rot resistance trait both in greenhouse and in the field, which led to the discovery of two regions on chromosome 14 associated respectively with the organ-specific resistance of the leaf and the bunch. Thanks to the construction of a highly dense genetic map, very small genomic regions have been detected, allowing speculation on possible resistance mechanisms as the phloem occlusion, the mitochondrial respiratory activity, and the production of reactive oxygen substances. Moreover, these mechanisms are known to be associated with resistance to broad-spectrum diseases. The research outcomes have been implemented for the development of new molecular tools for the selection of breeding offspring, and the sequencing of the genomic regions is underway for the deepening of the resistance mechanisms.
More info on International Journal of Molecular Sciences (2023) 24, 3568. https://doi.org/10.3390/ijms24043568

KEYWORDS: breeding, resistance genes, black rot SPECIES: Vitis ssp., Guignardia bidwellii

32
Symptoms of black rot on bunch and leaf
Resistant varieties registered in the National Register of Italian Wine Grape Varieties




For the past several years, there has been a focus in crossbreeding activity on the development of varieties that are resistant or tolerant to biotic stresses. The focus has been on the most prevalent diseases in our climates, such as downy mildew (Plasmopara viticola) and powdery mildew (Erysiphe necator). These fungal pathogens are able to attack most plant organs and cause high production losses and decline in grape quality; as a result, winemakers must be vigilant and intervene with different fungicides. In this area of activity, in 2020, 4 varieties were enrolled in the National Register of Italian Wine Grape Varieties, with the contribution of the Grapevine Innovation Consortium: ‘white berry Charvir’ and ‘Valnosia’, ‘black berry Termantis’ and ‘Nermantis’. Below are descriptions of these new varieties.
Charvir: Merzling X FR 440-60 cross. White grape variety with budding in mid-April, ripening time 14 days after Chardonnay, with good productivity and high sugar and acidity contents. Also suitable for production of sparkling wine bases with floral notes related to the terpene fraction of aromas. Locus of good resistance
to downy mildew, powdery mildew and black rot.
Valnosia: Nosiola X Bianca cross. White grape variety with budding around mid-April, harvest time 7-10 days after Chardonnay, with regular productivity, clusters not large but with fertility around 2. Good sugar and acidity contents in the must, suitable for still wines with Nosiola aroma enriched with notes given by the thiol precursors present. Locus of good resistance to downy mildew and powdery mildew. Wasps are attracted to the ripe berries. Termantis: Teroldego X Merzling cross. Black grape variety with budding around mid-April, harvest time 15-20 days after Chardonnay, with regular yields and fertility close to 2 clusters per bud, must with good acidity and rich in polyphenolic substances, including anthocyanins. The use of grapes of this variety is suitable for the production of wine for ageing, furthermore, the grapes also respond well to possible drying. It exhibits levels of anthocyanin diglucosides below legal levels. Resistance is reported to be good to downy mildew, powdery mildew and black rot. Nermantis: Teroldego X Merzling
33 AGROSYSTEMS AND BIOECONOMY
From left to right: bunch of Charvir, Valnosia, Termantis e Nermantis
LUCA ZULINI MARCO STEFANINI
cross. Black grape variety with budding around mid-April, harvest time 15-20 days after Chardonnay, with regular yields and fertility around 1.7, must with good acidity and rich in polyphenolic substances, including anthocyanins. The use of grapes
of this variety is suitable to produce ready-made wine with fruity and floral notes. It exhibits levels of anthocyanin diglucosides below legal levels. Resistance is reported to be good to downy mildew, powdery mildew and medium to black rot.
KEYWORDS: resistant varieties, grape, breeding, downy mildew, powdery mildew, black rot SPECIES: Vitis vinifera, Plasmopara viticola, Erysiphe necator, Guignardia bidwellii
Micropropagation of Vaccinium for breeding and germplasm conservation purposes at FEM

Micropropagation is a key instrument for propagation, conservation and exchange of blueberry germplasm. It therefore represents an indispensable technique and process, both in the maintenance of the germplasm and its biodiversity, and in the process of pre-breeding and breeding. New releases of woody and semi-
woody cuttings by means of conventional methods of vegetative propagation are slow and labor intensive. For this reason, micropropagation is a relevant tool in the process of genetic improvement of plants. The methods used in micropropagation allow for the simultaneous propagation and conservation of the accessions in vit-
34
KAREN ELIZABETH WELLS MONICA CATTANI LARA GIONGO
ro, thus improving the safety of the selected germplasm which are the source of new characters. Micropropagation techniques for the regeneration of axillary and adventitious shoots have been developed with variable success in Vaccinium spp. They have focused particularly on V. corymbosum but, when the complexity of hybridization and introgression of new Vaccinium species made the new varieties generally more complex, a greater knowledge of the protocols and interaction of the genotype with the relative factors of the technique became necessary. These factors, the culture medium, the physiological state of the donor plant and the plant organ used as an explant are highly dependent on the plant growth regulators. This genotype specific dependence makes it essential to know their interactions in order to obtain propagation yields appropriate to various processes. For the Berry Genetics and Breeding
Unit, micropropagation applied to the diversity of genotypes is an activity functional both to the maintenance of the germplasm (in particular of those accessions that do not adapt well to the collection environment and therefore need more care of regeneration) and to breeding (in particular in the reproduction of “Elite Lines” and advanced selections) to guarantee the first stage of reproduction and to safeguard the lines in terms of genetic correspondence. The priority choice to use this technique is further supported by the fact that it allows to obtain safer plant materials, in terms of phytosanitary health and it is far superior to other methods. Further, it is particularly useful in reference to the potential presence of viruses.
Between 2020 and 2022, 329 total accessions were introduced in vitro, 483 total accessions were multiplied in vitro and about 16,000 vitro plants were produced.
More info on ISHS Acta Horticulturae (2012) 946: 129-134. https://doi.org/10.17660/ActaHortic.2012.946.18

KEYWORDS: in vitro culture, propagation, blueberry SPECIES: Vaccinium spp.
Improving blueberry quality and shelf life by precise post-harvest management
Blueberries are highly perishable fruits especially during the post-harvest stage. Decay and dehydration, caused by abiotic and biotic stresses, cause softening and wilting of the berry and, consequently, reduce its shelf life and organoleptic quality. Therefore, there is a need for the development of innovative strategies to increase fruit shelf life without neglecting the organoleptic quality. Increased knowledge of genetic variability within blueberry germplasm
and genetic relationships among materials to be used in breeding activities can be an important support to optimise storage strategies. Our research activity is aimed at optimising blueberry conservation techniques considering the high variability of the main fruit quality traits found within the germplasm. For this purpose, a large collection of blueberry germplasm, including different species and interspecific hybrids, was evaluated by applying different
35 AGROSYSTEMS AND BIOECONOMY
BRIAN FARNETI MATTEO AJELLI MONICA CATTANI LARA GIONGO
advanced quality phenotyping methodologies (e.g., PTR-ToF-MS, Texture analyzer). The heritability of these storage-related quality traits was subsequently evaluated on a segregating population.
The variability observed at harvest for both texture and aroma profile was significantly increased during fruit storage, especially under controlled atmosphere conditions. For most of the blueberry accessions, the reduction of atmospheric oxygen during storage allowed for less texture decay and water loss and, at the same time, significantly altered the fruit’s aroma profile by increasing the concentration of fruity esters such as ethyl acetate or ethyl isovalerate. In our opinion, the synthesis of these compounds may be the result of

genotype-specific processes aimed at preventing the excessive accumulation of ethanol and acetaldehyde caused by anoxic stress. In addition, the results of these trials revealed high variability in ethylene production among genotypes. These differences in ethylene production might be related to the shelf life of blueberry fruits and based on alterations in aroma and texture. In particular, blueberry accessions characterised by the highest ethylene production also showed greater berry texture decay during storage. Our results support the possibility of tailoring ad hoc pre-harvest and post-harvest strategies to prolong blueberry shelf life and quality based also on the level of endogenous ethylene production of each cultivar.
More info on Frontiers in Plant Science (2022) 13. https://doi.org/10.3389/fpls.2022.813863
KEYWORDS: post-harvest, quality, blueberry SPECIES: Vaccinium spp.

36
Blueberry and raspberry breeding: new varieties at FEM

The FEM blueberry and raspberry breeding programs are recent, but they have already started to produce innovative materials for growers in different environments and cultivation systems. Speed and shuttle breeding are the approaches for both programs: they allow to shorten the generation cycles as well as to make the process highly sustainable, choosing the most suitable plant manipulation procedures to accelerate the phases to seedling production as well as multiple trial.
In addition, robust biomarkers, in the sense of specific texture and flavour parameters, have been developed and used as the best options, till as robust molecular markers associated with key traits will be available, to target and assist the selection.
Over the last three years, the rasp-
berry breeding program has been largely overcome by the one of blueberry. The latter is now run with a turnover of 20,000 seedlings per year in different European areas and with trials over several environments and cultivation systems. The genetic gain we see in blueberries includes certainly the genetic variation available, the selection intensity, but also the time to complete a breeding cycle. Relating to genetic variation, the Vaccinium genus offers a huge potential to introgress genes and develop new phenotypes. In 2022, the genetic gain within the blueberry breeding program was enhanced more than expected for those specific subcomponents we believe are at the moment a reasonable representation of blueberry fruit quality. Single berry weight, sugar content, maximal force,
37 AGROSYSTEMS AND BIOECONOMY
LARA GIONGO
ELISA
GIULIA VALENTINA MIOLLI
KATHLEEN WEIGL*
MAGDA-VIOLA HANKE*
HENRYK FLACHOWSKY*
AZEDDINE SI AMMOUR
elasticity of the skin and also a new measurement we defined for crisp phenotypes, increased significantly. Also for weight loss and texture subcomponents during postharvest the genetic gain was significantly improved in the same pool.
Blueberry breeding is a long term process, and we believe that only an integrated approach to breeding, strongly science based but tightly connected with the industry, can substantially improve or change blueberry fruit quality into new products for growers and consumers. This integration includes for FEM breeding program also a strong and mutual connection with the program’s stakeholders, that with their high growing expertise effectively contribute, in
particular, to confirm the GxE (genetic x environment) interactions that need to be trialled before a cultivar is released and set the threshold of their specific requirements.
The seven cultivar releases of FEM namely the raspberry ‘Janis’ a primocane of high fruit quality, and the blueberries ‘Gaia’ for northern early production, ‘Abundia’ for southern early yielding potential, ‘Creativa’ that is a jumbo variety, ‘Maia’ particularly flavoured and early, ‘Musa’ early in southern conditions and ‘Perla’ very consistent, have followed in the 2 years after registration an intense evaluation of gene - environment (“GXE”) interactions, both during their growth and in postharvest, in order to maximise the information for growers.
More info on Postharvest Biology and Technology (2022) 183, 111696. https://doi.org/10.1016/j.postharvbio.2021.111696

KEYWORDS: breeding, blueberry, raspberry
SPECIES:
Apple and the sleeping beauty fairytale: identified the gene controlling bud dormancy
The gene controlling bud dormancy in apple during the winter season was identified and characterised during a research activity carried out by Plant Epigenetics unit of the Edmund Mach Foundation, in collaboration with the Julius Kühn-Institut (JKI, Germany). This gene encodes a MADS-box transcription factor known to be a master regulator of gene expression in plants. The work started with the observation that some apple cultivars such as the widely cultivated ‘Golden Delicious’ require thousands of hours of exposure to chilling temperatures to be able to flower in spring. In contrast, genetically close cultivars grown in warmer climates such as ‘Dorsett golden’ require only
a few hundred hours, clearly indicating that the dormancy in apple is under genetic control. Using sophisticated functional genomics tools it was possible to identify the apple gene MdDAM1 (for Malus domestica Dormancy-Associated MADS-box 1) and to demonstrate that it is the key genetic regulator of bud dormancy. Furthermore, the results indicates that MdDAM1 also controls bud break in spring. This gene is very responsive to environmental parameters, especially cold, to ensure that growth of the apple tree is completely arrested in autumn. The bud break process at spring correlates perfectly with a complete silencing of MdDAM1. This work shows that apple cultivars in
38
Vaccinium corymbosum, Vaccinium spp., Rubus idaeus
MIRKO MOSER
ASQUINI
* Julius Kühn-Institut (JKI), Germany
which MdDAM1 is very low, or not present at all, either flower very early in the season or stay green all year around, even during harsh winter season. Besides the use of MdDAM1 as a genetic marker to produce apple trees with a low chilling requirement this finding can be leveraged to slow down the bud break in order to

avoid frost destroying flowers in early spring and jeopardise the apple production. This knowledge is extremely important to start producing apple varieties that will withstand the climate change since elevated temperatures in winter can inhibit bud dormancy and impair bud break process when spring arrives.


More information can be found in the article published in Frontiers in Plant Sciences (2020) 11. https://doi.org/10.3389/fpls.2020.01003
KEYWORDS: apple, dormancy, MADS-box gene SPECIES: Malus domestica
Right:
39 AGROSYSTEMS AND BIOECONOMY
Left: evergreen apple (silenced MdDAM1) stays green in winter.
evergreen apple tree flowering earlier in spring
MAURIZIO MASCARELLO ELISA ASQUINI MIRKO MOSER AZEDDINE SI AMMOUR

SIRNACIDE project: a novel RNAi-based pesticide against grapevine downy mildew

As declared in the United Nations millennium goals, one of the greatest challenges for humanity is the reduction of hunger by 2030 and the guarantee of food for the expected 8.3 billion people in the world. As a result, a significant increase in the use of synthetic pesticides is expected to optimise crop yields. However, these pesticides have serious adverse effects on the environment and human health.
Fruit and in particular grapes are among the crops that will require the most abundant use of fungicides, especially against downy mildew caused by the oomycete pathogen Plasmopara viticola. It is estimated that two thirds of all synthetic fungi-
cides currently used in agriculture in the European Union are used to control grapevine downy mildew. As a result P. viticola has recently become resistant to many fungicides. Therefore, the research and development of alternative strategies to control P. viticola infections is urgently needed. As an alternative to the use of toxic chemicals, a new type of plant protection product is proposed based on RNAi against P. viticola. This new type of fungicide is composed of organic, biodegradable vesicles that will be synthesised from algae-based material and which contain small interfering RNAs (siRNAs) that specifically target P. viticola without harming any other living organism. The siRNA-containing vesicles will be applied directly in the field using a technology called Spray Inducible Gene Silencing (SIGS). This new type of product acts by contact by binding directly to the pathogen and stops its growth by blocking the infection. The mode-of-action is similar to contact fungicides without the toxicity and harmfulness to the environment known for currently used chemicals. The project SIRNACIDE is funded by EUREGIO (IPN178, GECT Euregio science fund - 4th call).
More information can be found in the article published in Frontiers in Plant Sciences (2021) 12. https://doi.org/10.3389/fpls.2021.714116
KEYWORDS: downy mildew, grapevine, RNA interference
SPECIES: Plasmopara viticola, Vitis vinifera
40
Applied biotremology: eco-friendly solutions for agricultural pest control
In agriculture, the application of pest control strategies mostly relies on the massive use of chemicals that can negatively impact the environment, human health, and biodiversity. A sustainable alternative to pesticides is the behavioural manipulation of insects: species-specific signals are used to selectively decrease populations’ density and thus crop damage. An example of manipulation is mating disruption with pheromones, a technique largely used to control moths and other crop pests. However, many noxious species use vibrations to communicate and perceive the environment. Vibrational signals are transmitted through the substrate on which the insects live (e.g., plants) to mediate key behaviours, such as reproduction. For this reason, the development of new techniques of insect behavioural manipulation based on vibrational signals could open new perspectives in the field of pest control. Biotremology is the discipline that investigates animal vibrational communication. Applied biotremology requires a multidisciplinary approach, in which entomolo-
gists collaborate with mechanical and electronic engineers to develop and optimise vibration transducers. Such devices are then used for the transmission of vibrations to interfere with pests’ behaviour.
The first example of applied biotremology is the “vibrational mating disruption” technique to control the leafhopper, Scaphoideus titanus, the main vector of flavescence doreée, a grapevine disease. In 2017, for the first time ever, this technique was applied in an experimental vineyard of 1.5 Ha at San Michele all’Adige. A set of mini-shaker devices screwed into the trellis poles transmitted disruptive vibrations to all the plants of the vineyard. The result was a reduction of about 50% of the S. titanus populations since the second year of application.
A second example is the application to tomato and zucchini plants of disruptive vibrations with special vibrating platforms (‘vibroplates’) in synergy with the spray of plant extracts to reduce the infestation of the greenhouse whitefly Trialeurodes vaporariorum.

RACHELE NIERI* IMANE AKASSOU* SABINA AVOSANI
VALENTINA ZAFFARONI CAORSI VALERIA FATTORUSO*
ALICE BERARDO
VALERIO MAZZONI
* Center Agriculture Food Environment, University of Trento, Italy
Experimental set up for the study of vibrational communication of insects. The laboratory of applied biotremology with a laser Doppler vibrometer, a high precision instrument that allows the recording of vibrational signals, focused on the leaf of a plant. A mini-shaker is in contact with the leaf of the plant to playback artificial vibrations
41 AGROSYSTEMS AND BIOECONOMY
VALERIO ROSSI STACCONI
LIVIA ZAPPONI
CLAUDIO IORIATTI
OMAR ROTA STABELLI*
VALERIO MAZZONI
GIANFRANCO ANFORA*
* Center Agriculture Food Environment, University of Trento, Italy
IAS natural enemies.
Left: Ganaspis brasiliensis on a SWDinfested blueberry.
Right: Trissolcus japonicus on a BMSB eggmass
A third example of a vibrational technique is the emission of signals specifically synthesized to attract the brown-marmorated stink bug, Halyomorpha halys in bimodal traps (pheromones + vibrations). These traps resulted in a significant increase of capture efficiency in comparison with commercial products, so that
they were soon made available for the market.
In conclusion, biotremology has a huge potential for applications in crop protection, both in terms of new technologies and of improvement of the existing ones. Hence, new sets of sustainable solutions for the farmers are expected in the future.
More info on Entomologia Generalis (2022) 42, 2: 167-183. https://doi.org/10.1127/entomologia/2021/1236

KEYWORDS: crop protection, vibrational signals, behavioural manipulation, American grapevine leafhopper, greenhouse whitefly, brown marmorated stink bug SPECIES: Scaphoideus titanus, Trialeurodes vaporariorum, Halyomorpha halys
Invasive alien species and biocontrol
Invasive alien species (IAS) are a major threat for agriculture, the environment and biodiversity. IAS proliferate in the invaded regions due to the absence of specialised natural enemies. Re-establishing the natural balance through classical biological control, by releasing specific antagonists imported from the pest’s native area, would limit IAS harmfulness in a sustainable way.
As part of the national control campaigns against these IAS, classical biological control programs against the brown marmorated stink bug (BMSB, Halyomorpha halys) and the spotted-wing drosophila (SWD, Drosoph-
ila suzukii) are underway in Trentino since 2020 and 2021, respectively. Two “micro-wasps” were selected as biocontrol agents: Trissolcus japonicus, which parasitizes BMSB’s eggs, and Ganaspis brasiliensis, which attacks young larvae of the SWD. Mass rearing of these two natural enemies were established in the Fondazione Mach quarantine facility, to support inoculative releases in all the major fruit-growing areas of the province. The monitoring campaign conducted during the first three years of T. japonicus releases (2020-2022) confirmed the establishment of the wasp in the release areas with an increas-


42
ing trend of its dispersion throughout the territory and of its impact on BMSB eggs. In fact, in 2022 T. japonicus was found in 53% of the release sites where at the end of the season the BMSB egg parasitization rate was 29%. Along with this parasitization growth, there has been a reduction in the sprayed apple-growing area and in the number of specific insecticide treatments used against BMSB. The field monitoring recorded the presence and the range expansion of another BMSB exotic parasitoid, Trissolcus mitsukurii. In parallel with the biocontrol activities, the genome of T. japonicus individuals sampled in Trentino was sequenced thanks to which it will be possible to reconstruct the demography of the parasitoid in the field and lay the foundations for future studies to optimize the parasi-
More info on BioControl (2023) 68, 1-12. https://doi.org/10.1007/s10526-022-10174-2
toid efficacy through breeding and crossbreeding assisted by genomics. Regarding the D. suzukii biocontrol, the releases of G. brasiliensis started from August 2021 at 12 sites, subsequently increased to 20 in the 2022 campaign. The monitoring activity carried out in the first two years confirmed the ability of the parasitoid to overwinter, suggesting its establishment in progress in various sites of the province. Another remarkable result concerns the impact of a second exotic antagonist of SWD, Leptopilina japonica, whose presence had been reported in Trentino since 2019. Altogether, the field monitoring conducted at the release sites showed an increased rate of the attack on D. suzukii larvae by the two exotic parasitoids, from 6.06% in 2021 to 15.12% in 2022.
KEYWORDS: brown marmorated stink bug, spotted-wing drosophila, samurai wasp
SPECIES: Halyomorpha halys, Drosophila suzukii, Trissolcus japonicus, Ganaspis brasiliensis, Trissolcus mitsukurii, Leptopilina japonica
Sustainable crop protection strategies
In view of the new European Regulation on the sustainable use of pesticides, sustainable crop protection strategies are extremely topical. The challenge is to progressively reduce the use of chemically synthesised plant protection products and fertilisers, while increasing crop production, safeguarding natural resources, such as water and soil, and reducing the use of fossil energy sources. Four substances alternative to copper (three plant extracts and a rare sugar) were developed and evaluated. Copper is still a mainstay fungicide in organic and conventional agriculture, but also a candidate for substitution. The four products of natural origin
were developed by three European market-leading companies. Starting from evaluations of compatibility with commercial plant protection products and efficacy under controlled conditions, low-dose copper strategies were optimised in combination with the new products in three growing seasons in commercial-like vineyards. Some of these strategies showed high efficacy against grapevine downy mildew infections on bunches and leaves without any negative effect on the grape quality and the winemaking process. The low protection stability over time still remains a limiting factor, which however can be improved with the formulation. The research
* Center Agriculture Food Environment, University of Trento, Italy

43 AGROSYSTEMS AND BIOECONOMY
OSCAR GIOVANNINI CARMELA SICHER MICHELE PERAZZOLLI* ILARIA PERTOT* GERARDO PUOPOLO*
activities also allowed to determine the best dosage and application time of various plant extracts under controlled conditions that showed an efficacy similar to copper when applied the day before the infection. Stability tests showed that most of the evaluated formulations are particularly sensitive to rain washoff, which is one of the main limitations of biofungicides. Furthermore, their combination with low doses of copper did not always show a synergistic effect. The mechanism of action of the active ingredients of the most effective formulations was also studied, demonstrating their antimicrobial activity against Plasmopara viticola sporangia and their ability to induce in the plant resistance mechanisms, such as the production of callose and reactive oxygen species.
Overall, the results showed that the new active substances are able to protect grapevine plants against downy mildew through direct activity against sporangia and the activation of resistance mechanisms in grapevine leaves. The reduction of plant protection products in agriculture is not based only on their replacement with natural molecules, but it can also take advantage of tools that allow the correct and effective timing of application, which can be obtained with the use of models that can support farmer’s decision-making. Models are accurate when the information used to feed them is detailed. To this aim, a study is underway to determine the dynamics of maturation of the oospores of P. viticola in the vineyard for a more accurate modelling of the risk of primary infections.
More info on Biocontrol Science and Technology (2022) 32 (8): 930-951. https://doi.org/10.1080/09583157.2022.2064431

KEYWORDS: crop protection, biofungicides, disease control, downy mildew
SPECIES: Vitis vinifera, Plasmopara viticola

44
Plant-microbe interactions and plant bio-stimulation
Plant-associated microbial communities interact with their host and can directly affect the plant health and crop production. Results of metataxonomic studies, that were carried out to characterise microorganisms associated with apple trees, highlighted the different composition of fungal and bacterial communities according to the plant organ (bark, leaf, flower, and fruit), demonstrating that different parts of the plant can harbour a specific microbiota. This work indicated the specificity of the microbiota associated with apple aboveground tissues and the progressive changes of the microbiota during orchard plant development, from planting to establishment. These studies also revealed that agronomic practices can influence the composition of microbial communities associated with
apple trees and that the reduction of fungicide applications can negatively influence the abundance of some taxa possibly responsible for secondary diseases. Moreover, protein- and sugar-based products can be applied to modify the composition of indigenous plant-associated microorganisms and to improve the proportion of biocontrol bacteria against plant pathogens, indicating that a new frontier of biological control can be obtained by applications of plant pre-biotic products that are tailored for plant microbiota engineering. The understanding of plant-microbe interactions allowed the characterization of sustainable approaches to stimulate plant growth and plant protection against biotic and abiotic stresses. The mechanisms of action of bacterial endophytes were charac-

45 AGROSYSTEMS AND BIOECONOMY
CLAUDIA MARIA LONGA OSCAR GIOVANNINI CARMELA SICHER ILARIA PERTOT* GERARDO PUOPOLO* MICHELE PERAZZOLLI*
* Center Agriculture Food Environment, University of Trento, Italy
terised to identify key processes (e.g., genes, metabolites, and pathways) responsible for plant growth promotion and tolerance against abiotic stresses derived from climate changes. Moreover, prototypes of bacterial formulation with humic substances were developed for crop biofertilization to reduce the use of chemical fertilisers and improve soil microbial fertility. Likewise, new delivery strategies of plant beneficial bacteria were tested, and the use of beneficial insects was found as a promising approach to efficiently inoculate crop plants with plant-growth-promoting microbial endophytes. In addition, soluble and volatile compounds involved in plant-microbe and plant-plant com-
munications were identified, and new strategies for plant protection were obtained by the application of selected volatile organic compounds (biofumigation) and microbial communication signals (quorum sensing and socio-microbiology). In particular, the application of chemical and/ or biological resistance inducers and their derivatives were found to be stimulators of priming state with broad-spectrum activity against biotic and abiotic stresses. However, the interplay between multiple stimuli and the contribution of plant genotype should be better considered for the efficient induction of plant resistance mechanisms and stress mitigation.
More info on Frontiers in Microbiology (2021) 12.
https://doi.org/10.3389/fmicb.2021.725403
KEYWORDS: plant microbiome, plant resistance induction, stress mitigation
SPECIES: Malus domestica
Smart vineyard and lab
In 2021, an experimental vineyard dedicated to precision agriculture activities was built on the campus of the Fondazione Edmund Mach in San Michele all’Adige, Italy, which will
host most of the innovative digital research and experimentation activities in the coming years.
Vineyard 4.0 was developed to facilitate installation, powering and data


46
ROBERTO ZORER LUCA DELUCCHI
transmission by prototypes developed at FEM or in collaboration with national and international companies and research organisations. It is equipped with electricity connection, low-voltage power lines, WiFi and LoRaWAN coverage for receiving information via long-distance radio signals from soil, plant and environmental data collection and transmission systems. Since there is no need for photovoltaic panels, batteries, modems, the size and consequently the footprint of the acquisition systems can be minimised, leading to a low impact on the day-to-day management of the plots.
The first smart installation was a mini phenological station, a device for automated collection of images, temperature, air humidity and leaf wetness data and sending them to a remote server. Data and images are used to continuously follow the development of vegetation and for modelling the most important events from a viticultural-enological point of view, such as: bud brake and shoot growth, flowering, fruit set (formation of berry buds), veraison (change in berry colour and texture), ripening, and senescence. Knowledge of
vegetation development stages supports both frost risk assessment and crop management activities such as phytosanitary treatments, irrigation, canopy management, and harvest scheduling.
The development of tools to be installed in the field is supported by the presence in FEM of a prototyping laboratory equipped with a 3D printer, laser cutting/engraving plotter, micro milling machine, welding station and various light workshop equipment. The group also relies on the collaboration with the Agrometeorology and Information Systems Unit of the Technology Transfer Center FEM, University of Trento, FBK, as well as the network of companies coordinated by Trentino Sviluppo and Hub Innovazione Trentino, and finally the international free and open software/ hardware community, such as Arduino project.
Some FEM devices are already undergoing field trials, both at the smart vineyard and in collaboration with local companies. In addition, FEM’s demonstration vineyard is available for testing and validation activities of systems developed by other innovative manufacturing companies.
KEYWORDS: digital agriculture, Internet of Things, smart vineyard
A mini-phenological station
The knowledge of the developmental stages of field crops is crucial for proper management, but also for the assessment of climatic anomalies and phenological interannual variability. For example, frost risk, pest management, irrigation requirements, ripening models, and harvest scheduling are related to the plant development stage. Nowadays there are several tools that can assist in surveying activities, such as apps for smartphones, digital field notebooks, and innovative surveying stations. Based on the results of the EIT Climate-KIC
project “PhenoPiCam” (in collaboration with CNR-Ibe of Florence and YetiSystems of Pineta di Laives), a new prototype was developed, based on the Raspberry Pi zero W computer board for collecting and sending images via WiFi and the Arduino MKR WAN micro-controller for detecting temperature and relative air humidity, acquired by a digital thermo-hygrometer and finally leaf wetness, detected by a capacitive sensor. The Arduino MKR 1300 and 1310 models use the LoRaWAN (Long Range and Wide Area Network) protocol
47 AGROSYSTEMS AND BIOECONOMY
ROBERTO ZORER LUCA DELUCCHI
for sending data over a free ISM (Industrial, Scientific and Medical) radio band.
LoRaWAN is designed to enable long range, low bit rate communications between electronic devices. The various components are mounted on a printed circuit board (PCB) designed and manufactured by FEM, called ‘Raspberrino’ for the property of housing both Raspberry Pi and Arduino on the same board and allowing serial communication between the two devices. The station is powered at low voltage through voltage
KEYWORDS: phenology, Raspberry Pi, Arduino
regulators and a clock and power management board for scheduled powering of the system. Some customized components were both 3D designed and printed. The first field implementation of the prototype has been installed at the Fondazione Edmund Mach’s “smart vineyard” in San Michele all’Adige.
The new prototype allowed the acquisition of a series of daily images, which documented the whole vegetative period of the vine, and temperature data used for phenology modelling activities.

DigiAgriApp, a digital solution for field monitoring
After the establishment of the Smart Vineyard on the campus of the Edmund Mach Foundation in San Michele all’Adige, we felt the need for a system that could save and display field data. Therefore, one of the first goals of the new Digital Agriculture Unit, was DigiAgriApp, a software solution that can be easily adapted to different situations, from the home
garden to an experimental field, up to a commercial one.
The software consists of a relational database, based on the PostgreSQL DataBase Management System, where all data are stored back: main field and plot features, but also of individual plants, the planted crops varieties, both soil and canopy management, irrigation, production, images
48
LUCA DELUCCHI ROBERTO ZORER ANDREA PAOLI
collected by mobile devices, but also data received from on-site weather stations and remote sensors (such as drones or satellites).
The main user interface is a multi-platform application, both for mobile devices and pc/laptops, but it is also possible to access and manage data through a website, or to add or modify the geometries of fields, plots, rows and plants using QGIS software and interacting with the database through an ad hoc developed plugin.

One of the special features of the application is its scalarity, i.e. the possibility of integrating point data,
KEYWORDS: digital agriculture, data, App
proximal (drones or gps-equipped instruments) and remote (satellite) sensing data linked to plots down to individual plants, in order to feed future decision support models (DSS).
The project was selected and funded as part of the 10th VRT Mountain Innovators Foundation Call for Proposals, which will improve the DigiAgriApp platform, by making all components related to data storage more stable, and adding new features to the user interface.
The source code of the application will be released under a Free and Open Source licence, not a common feature for similar software.
A new approach for calculating thermal indices of water stress
The assessment of water status and irrigation requirements of major crops on a landscape scale is of increasing interest and relevance due to the high variability of rainfall in both frequency of events and intensity. Since early 1980s, crop water stress indices based on leaf temperature
have been introduced, which nowadays, thanks to the advent of new technologies both in terms of sensors (infrared thermometers, thermal and multispectral cameras), proximal (Unmanned Aerial Vehicles - UAV, remotely operated vehicles - ROV) and, remote sensing (NASA MODIS Land
49 AGROSYSTEMS AND BIOECONOMY
ROBERTO ZORER LUCA DELUCCHI
Surface Temperature, Copernicus Sentinel-3) products are finding new fields of application and renewed interest.
Starting from the detection of leaf and canopy temperature and through the calculation of stomatal conductance indices, it is indeed possible to detect early and noninvasively, situations of thermal and physiological variability within crops, which in the long run can lead to the onset of differences in vigour and productivity.
The ability to detect early situations of water deficit and/or stress can be crucial for proper irrigation scheduling, reducing the risk of loss of quantity or quality of the production, while preserving the water resource.

One of the most widely used index is the Crop Water Stress Index - CWSI, codified by Idso et al. in 1981, which includes leaf temperatures among the variables, both under stress and
non-limiting hydration conditions. Such values are traditionally derived empirically, based on temperatures observed in the field or by treating some leaves with transpiration inhibitors (pinolene), others with water. Following an innovative agro-meteorological approach and Internet of Things - IoT devices, a low-cost CWSI measurement station prototype was built.
The device can be used for thermal mapping of vegetation water status either through point surveys, conversion of drone-acquired images to assess the variability within plots, or on a landscape scale through thermal satellite image processing. The use of an agrometeorological approach coupled with new low-cost air temperature and moisture sensors open new application scenarios to the assessment of stomatal-conductance indices based on vegetation temperature sensing.
More info on Agricultural Meteorology (1981) 24, 45-55. https://doi.org/10.1016/0002-1571(81)90032-7
KEYWORDS: crop water stress index, thermal imaging, Internet of Things

50
Interaction between organic matter and fertilizers to improve soil fertility
The soil is a non-renewable resource. Recently, more than onethird of the world’s soil has been defined as moderate to highly degraded (FAO, 2015). The sustainable management of soil from both agronomic and environmental points of view is strongly recommended. The European Commission promoted a dedicated Mission (Mission Soil and Health) to improve soil quality and reduce pollution, desertification and sealing. Moreover, In the New Green Deal, the Farm to Fork strategy aims to reduce by at least 20% the mineral fertilisers and by 50% the loss of nutrients, by 2030.
The HYDRORG Project (founded by Fondazione VRT, 2021) has developed an analytical approach to monitor soil organic matter and nutrient dynamics (N, P, K, Mg, and

micronutrients), after soil improvers application to find valuable solutions for soil fertility management and at the same time for carbon storage in soil, by using mesocosms (incubations of soil amended with different organic products at controlled conditions).
The carbon analysis of both amendment and relative soil amended has been analysed considering the dissolved organic matter (DOM) after extraction and following measures with 1HNMR. The recalcitrant fraction has been quantified after alkaline extraction and analysis by 13C NMR (both analyses have been made in collaboration with UNIMI).
The first data highlighted significant differences among the amendments used (considering DOM, aliphatic, and aromatic carbon fractions), while the
51 AGROSYSTEMS AND BIOECONOMY
DANIELA BONA ANDREA CRISTOFORETTI SILVIA SILVESTRI
analyses of incubated soils are currently in progress. Moreover, the measurements of GHG emissions (CO2, and in some tests also CH4 and N20, in collaboration with UNIBZ) provide useful information regarding the dynamics of soil organic carbon and its management. In recent years, the long-term monitoring of soils (of both orchards and meadows) could improve the knowledge about the effects after manure, digestate, and biochar application, in the open field. The first data demonstrated the crucial role of the specific knowledge of soil and soil improvers used to obtain the expected fertilising and amendment effects, highlighting
the relevance of different factors on nutrients and SOM, such as soil tillage, soil management, and the kind of soil improvers used. Moreover, the work suggests the possibility to reduce mineral fertilisation, with proper management of SOM, and the consequent environmental impact generated (loss of nutrients and carbon storage).
A similar approach will be tried in the SMS Green project, which was approved and started in 2022; the chemical analysis of soil organic matter and nutrients will be combined with data about soil microbial communities, after hydrochar, compost, and digestate application.
More info on Waste Management (2023) 159, 75-83. http://doi.org/10.1016/j.wasman.2023.01.024

KEYWORDS: soil organic matter, organic fertilisers, soil fertility
Hydrochar and Co-Compost from biomass exploitation: new strategies for enhancing agronomic properties
Hydrothermal Carbonization (HTC) is a technology suitable to efficiently treat wet biomasses - such as digestate, sludge, and agro-industrial waste - via thermochemical reaction. This technology can be a convenient solution to avoid the disposal of these residues and, at the same time, to provide organic matter and nutrients for agriculture. Hydrochar (HC) is a solid fraction obtained after this thermochemical reaction, and is a carbonaceous product which could have an interesting use in the soil as an amendment. Now, some works deal with understanding its agro-environmental properties.
The C2LAND project (co-founded by EIT Climate-KIC; 2020, in collaboration
with UNITN) and the HTC-Upfield project (founded by Law PAT 6/99; 20202021, Carborem Srl) have provided data on HCs obtained from different wastes, i.e., OFMSW (organic fraction of municipal solid waste) digestate and agro-industrial digestate, respectively.
The results revealed HC phytotoxicity due to both chemical compounds deriving from feedstock used (as salinity and heavy metals content) and organic compounds arising from the thermochemical process. When the HC did not contain toxic compounds (heavy metals and polycyclic aromatic compounds), as is the HC from OFMSW digestate, the dose-response analysis highlighted the hormesis at
52
DANIELA BONA DONATO SCRINZI* LUCA GRANDI SILVIA SILVESTRI
* Department of Civil, Environmental and Mechanical Engineering, University of Trento, Italy
low doses while resulting in phytotoxicity at higher doses. The hormesis seems related to a good content of nutrients and to humic-like molecules produced after the HTC reaction, which could enhance the germination and growth of plants. At higher doses, the easily degradable organic carbon, probably, determined an increase in soil microbial activity resulting in nutrient immobilization and the occurrence of anoxic conditions due to CO2 accumulation.
The C2LAND project demonstrated
the suitability of HC co-composting to overcome the phytotoxicity due to organic compounds. The co-compost obtained after aerobic post-treatment is a good-quality amendment with specific properties, also different from compost.
The experimental approach adopted in these studies effectively enlarged the knowledge about the agro-environmental properties of organic fertilisers by combining chemical analysis and plant and soil effects from a circular bio-economy point of view.

More info on Journal of Environmental Management (2022) 312, 114894. https://doi.org/10.1016/j.jenvman.2022.114894
KEYWORDS: hydrochar, co-composting, agro-environmental properties

53 AGROSYSTEMS AND BIOECONOMY
LUCA TOMASI ANDREA CRISTOFORETTI MATTIA VOLTOLINI DANIELA BONA LUCA GRANDI SILVIA SILVESTRI
waste to resources: quantification of Trentino agri-food residues to produce renewable energy
The 2021-2030 Environmental Energy Plan (PEAP) that the Autonomous Province of Trento (PAT) has planned for the next decade includes ambitious actions for climate change mitigation. The Bioeconomy unit of Edmund Mach Foundation contributed to this plan by quantifying the contribution from energy exploitation of local organic wastes. Firstly, they quantified the main residual matrices – i.e.: livestock manure, agri-food waste, sludge from water treatment and industrial processes, wet fraction from separate waste collection – through the available data and archives and, subsequently, by calculating the theoretical biogas potential obtainable. Hence, they elaborated scenarios of energy exploitation for the individual Valley Communities, theorising the construction of territorial plants to convert biogas into electrical and thermal energy in a cogeneration set-up or to obtain biomethane to be injected into the distribution network of the natural gas. Following the enactment of PEAP, in concert with the involved PAT Services and Agencies, it was deemed appropriate to carry out a further
study, resorting to a survey for the entire provincial territory directly at a wide selection of agro-industrial and zootechnical companies. This survey carried out in 2022 collected detailed information about wastes disposed of or sent to other destinations (e.g., animal feed, nutraceuticals, energy conversion), often outside the province. Thus, the quantification of the biogas potential has achieved a better correspondence to reality, identifying a potential of over 6.5 million Nm3/year of biogas obtainable only from the considered agro-food matrices, corresponding to about 3.5 million Nm3/year of biomethane. During 2023, FEM will take a further step towards obtaining a more realistic estimate: the main identified matrices will be subjected to a chemical-physical characterization, and laboratory-scale tests will analyse the biogas production of the mix of matrices deemed most appropriate in a real scenario.
These studies intersect with the insights that the same FEM group is carrying out in a Working Table engaged in identifying actions to improve water quality in certain ar-
Position of the main theoretical potentials of biogas/biomethane identified in the province (the height of the histograms is proportional to the potential expressed in Nm3/year)

54
From
eas found non-compliant with the mandatory legislation. Anaerobic digestion can contribute to a shift into sustainable management of live -
stock manures; combining wastes from other supply chains could optimise the energy yield with increased benefits.

Consult the PEAP 2021-2030 (in Annex 8 the contribution of the Bioeconomy Unit) at the link https://www.provincia.tn.it/Documenti-e-dati/Documenti-diprogrammazione/Piano-Energetico-Ambientale-Provinciale-2021-2030
PAROLE CHIAVE: bioeconomy, agrifood, energy

55 AGROSYSTEMS AND BIOECONOMY
Brewery residual


FOOD AND NUTRITION
Elucidation of biosynthesis and physiological function of dihydrochalcones using apple chemodiversity
Dihydrochalcones (DHCs) are bioactive polyphenols found in different tissues of apple trees. They have only recently come into focus for researchers in a range of fields. DHCs might act as UV filters in leaves, potent cellular antioxidants or play a role in pathogen resistance. However conclusive evidence for the precise in planta functions is still elusive and still controversial among scientists. The biosynthetic pathways leading to DHC formation is still only partially elucidated but has provided the basis for genetic engineering of key steps of the pathway which has resulted in creation of a number of transgenic apple lines with altered DHC levels.

Phloridzin (Pz) is the most abundant
DHC compound in apple, which results from the action of a key phloretin-specific UDP-2′-O-glucosyltransferase (MdPGT1). The simultaneous assessment of the effects of targeting MdPGT1 by conventional transgenesis and CRISPR/Cas9-mediated genome editing was conducted. Knockdown lines exhibited characteristic impairment of plant growth and leaf morphology, whilst genome-edited lines exhibited normal growth despite also reduced foliar Pz. We identified genes and processes differentially modulated in stunted and genome-edited lines, including genes involved in phytohormone signalling. Phytohormone profiling revealed that salicylic and jasmonic acid were
58
SIMON MIRANDA MICKAEL MALNOY STEFAN MARTENS
increased in dwarf lines, whilst auxin and abscisic acid showed no correlation with the growth phenotype. Furthermore, bioactive brassinosteroids were commonly upregulated, whereas gibberellin GA4 was distinctively altered, showing a sharp decrease in RNAi knockdown lines. These findings suggest that a differential modulation of phytohormones may be involved in the contrasting effects on growth following Pz reduction and illustrates how CRISPR/Cas9 genome editing can be applied to dissect the contribution of genes involved in Pz biosynthesis in apple.
Sieboldin (Sb) is a DHC found in high concentrations in some wild Malus species. The first committed step towards the biosynthesis of Sb were elucidated by combined transcrip -
tomic analysis and a de novo transcriptome assembly to identify two putative 3-hydroxylases in two wild Malus whose DHC profile is dominated by Sb. We assessed the in vivo activity of putative candidates to produce 3-hydroxyphloretin and Sb by de novo production in yeast. We found that CYP98A proteins of wild Malus accessions were able to produce 3-hydroxyphloretin, ultimately leading to Sb accumulation by co-expression with PGT2. CYP98A197-198 genes of M. domestica, however, were unable to hydroxylate phloretin in vivo. Taken together, we provide the first evidence of an enzyme producing Sb in vivo that could be involved in the key hydroxylation step towards the synthesis of Sb in Malus species.
KEYWORDS: dihydrochalcones, biosynthesis, apple SPECIES: Malus spp.
The Trentingrana as a case of winning biodiversity
The production of traditional and artisanal cheeses is often based on fermentation processes carried out
by defined bacterial cultures, used to obtain typical flavours and/or textures. The bacteria naturally present
 ELENA FRANCIOSI ANDREA MANCINI
ELENA FRANCIOSI ANDREA MANCINI
59 FOOD AND NUTRITION
in the whey are traditionally used in the production of Trentingrana, as well as other Italian hard cheeses (Parmigiano Reggiano and Grana Padano).
Bacteriophages or phages can negatively affect the performance of dairy whey bacteria. Phages are viruses able to infect bacteria and are present in all environments including dairies. As in other ecosystems, phages play an ecological role, inhibiting faster growing bacterial strains. The presence of phages balances the excessive bacterial growth, preserving the overall biodiversity and technological performance of the whey. Therefore, the comprehension of the dynamics between bacterial and phage biodiversity in dairy whey is of primary importance for good management of whey production.
With the collaboration of Gruppo Formaggi Trentini, we started a robust study on the dynamics and biodiversity of bacteria and phages in whey using a massive sampling system at six Trentingrana dairies over a year of production, for a total of 216 samples of dairy whey.
A combined approach, using classical microbiology and meta-taxonomic analysis allowed to find Lactobacillus helveticus as dominant species in serum cultures and Lactobacillus brevis as co-dominant. We have set up a Trentingrana whey bio-bank made up of more than 1,200 bacteria and 120 phages. The presence of phages was detected in most of the dairy whey samples tested but, despite the large number of phages found, the microbial quality of the dairy whey cultures was very high.
This study is a case of natural resistance of L. helveticus to phages contamination, which persists over time. It is evident the presence of a microbiological balance between phages and bacteria in which the use of natural whey cultures creates an ideal environment for the proliferation of many different strains of L. helveticus able to balance the presence of phages avoiding dairy quality problems. We have also selected a pool of the best strains of L. helveticus to be used as a dairy whey “backup” in the event of an accidental loss of bacterial biodiversity.
For a better understanding of the experimental plan, please see the paper published in Frontiers in Microbiology (2021) 12.
https://doi.org/10.3389/fmicb.2021.678012

KEYWORDS: Trentingrana, natural whey starter, bacteriophage SPECIES: Lactobacillus helveticus, Lactobacillus brevis
Metabolomic and sensorial biodiversity of Italian red and white wines
Italy is one of the most important countries in the world with regard to viticulture and oenology, having the highest worldwide wine production (54.8 million hL) and one of the richest ampelographic platforms (over 500 cultivars). This is the result of a long term multi-oenological culture, where each region produces its own wine based on local cultivars, terri-
tory characteristics, culinary habits, tradition, and human needs.
D:Wines consortium, composed by six Italian institutions, was formed to study the Italian oenological biodiversity and was supported by national fundings winning two competitive PRIN projects in the field of Life Sciences.The first project was focused on 11 single-cultivar, single-vintage
60
SILVIA CARLIN PANAGIOTIS ARAPITSAS DANIELE PERENZONI DOMENICO MASUERO CESARE LOTTI URSKA VRHOVSEK
FULVIO MATTIVI*
* Center Agriculture Food Environment, University of Trento, Italy
Italian red origin wines (Aglianico, Cannonau, Corvina, Montepulciano, Nebbiolo, Nerello, Primitivo, Raboso, Sagrantino, Sangiovese, and Teroldego) from 12 regions across Italy, while the second project was focused on 18 single-cultivar, single-vintage Italian white origin wines (Albana, Arneis, Cortese, Erbaluce, Falanghina, Fiano, Garganega, Greco di Tufo, Gewürztraminer, Lugana, Müller-Thurgau, Nosiola, Pallagrello, Pinot Grigio, Ribolla, Vermentino, Vernaccia, and Verdicchio) from 9 regions across Italy, each one produced in their terroirs under ad hoc legal frameworks to guarantee their quality and origin. The multi-platform analytical survey based on almost 3000 wine bottles, included an enriched list of basic oenological analysis, sensorial characterization, protein and polysaccharides quantification, and metabolomics analysis. Between 2020 and 2022, the consortium published more than 10 scientific papers. The major outcomes included were:
1. The registration of the metabolomic fingerprint of each wine, which included several unique putative biomarkers of origin wines characterising each individual cultivar–terroir combination (e.g. Primitivo was dis-
KEYWORDS: wine, metabolomics

tinguished by its amino acids and N-contained metabolites; Cannonau was marked by its hydroxycinnamates; and Sangiovese, together with Nebbiolo, had a flavonol profile stamped by quercetin).
2. The systematic sensorial and chemical characterization of the astringent profile of each red wine (eg. Tergoldego wines had less dynamic and more soft astringent sensory character, and were among the richest in B-ring trihydroxylated flavan-3-ols).
3. The sensory sorting analysis allowed the grouping of the wines according to their thiolic characteristics. The chemical variables and the odour descriptors attributable to the thiol notes are important for Müller-Thurgau and Lugana wines, while the contribution of thiol notes was sensorially negligible for the other wines.
This systematic and comprehensive study could help us to understand and communicate the Italian oenological biodiversity and heritage, to improve chemical traceability based on a much larger number of cultivar-specific biomarkers, and provide new scientific insights and precision winemaking tools.
61 FOOD AND NUTRITION
INES DELGADO*
SOFIA CUSSOTTO*
ANDREA ANESI
SANDRA DEXPERT*
AGNES AUBERT*
BRUNO AOUIZERATE*
CEDRIC BEAU**
DAMIEN FORESTIER**
PATRICK LEDAGUENEL**
ERIC MAGNE**
FULVIO MATTIVI***
LUCILE CAPURON*
Association between the indole pathway of tryptophan metabolism and subclinical depressive symptoms in obesity: a preliminary study
Depressive symptoms are frequently reported in subjects with obesity and converging data support the role of chronic low-grade inflammation in this effect. One mechanism likely to be involved relies on the effects of inflammation on tryptophan metabolism, an essential amino acid precursor of neurotransmitter serotonin, which is highly involved in the regulation of mood. While recent data document alterations in the indole pathway of tryptophan metabolism in obesity, the relevance of this mechanism to obesity-related depressive symptoms has not been investigated.

The aim of a preliminary study carried out by the Metabolomics Unit in collaboration with University of Bordeaux and Clinique Jean Villar di Bruges (France) was to assess the association between plasma levels of tryptophan and indole metabolites and depressive symptoms in 44 subjects with severe or morbid obesity, free of clinically relevant neuropsychiatric disorders. Plasma samples
were extracted and analysed by mass spectrometry LC-MS/MS by using a protocol validated by our laboratory for the targeted quantification of essential amino acid metabolism and their catabolites produced by human and gut-microbiota metabolism in human biofluids. The interaction effect of inflammation, reflected in serum high-sensitive C-reactive protein levels, and indoles on depressive symptoms was also determined. Higher serum levels of high-sensitive C-reactive protein and lower concentrations of tryptophan and indoles, particularly those derived from gut-microbiota metabolism as indole-3-carboxaldehyde, correlated with more severe depressive symptoms. Interestingly, the effect of high high-sensitive C-reactive protein levels in predicting greater depressive symptoms was potentiated by low indole-3-carboxaldehyde concentrations. These results comfort the link between inflammation, the indole pathway of tryptophan
62
* University of Bordeaux, INRAE, France
** Clinique Jean Villar Bruges, France
*** Center Agriculture Food Environment, University of Trento, Italy
metabolism, and obesity-related depressive symptoms. Although the mechanisms underlying these interactions could not be disentangled at this stage, it can be proposed that
dysregulation of gut-brain axis communication, mediated by tryptophan metabolites, might be involved in the effect of obesity-related inflammation in mood.

More information is available in the article published on International Journal of Obesity (2022) 46: 885-888. https://doi.org/10.1038/s41366-021-01049-0
KEYWORDS: nutrition, tryptophan metabolism, gut microbiota, inflammation, obesity
Quantification of urinary phenyl- -valerolactones and related valeric acids in human urine on consumption of apples

In the context of healthy lifestyles and disease prevention, flavan-3-ols are considered as dietary bioactive molecules, food constituents that are not essential for humans but which may contribute in reducing the risk of various diseases and promoting healthy aging. Flavan-3-ols are a class of phytochemicals widely found in nuts, fruits and vegetables.
Monomeric flavan-3-ols,as catechin and epicatechin, are rapidly absorbed in the small intestine and released in the blood stream as phase
II conjugates. Polymeric flavan-3ols are extensively metabolized by colonic gut microbiota into phenyl-gamma-valerolactones and their related phenylvaleric acids. These molecules are the main circulating metabolites in humans after the ingestion of flavan-3-ol rich-products; nevertheless, they have received less attention and their role is not understood yet.
Here, we describe the quantification of 8 phenyl-gamma-valerolactones and 3 phenylvaleric acids in the
* Department of Food & Drug, University of Parma, Italy
** Max Rubner-Institut, Germany
*** Center Agriculture Food Environment, University of Trento, Italy
63 FOOD AND NUTRITION
ANDREA ANESI PEDRO MENA* ACHIM BUB** MARYNKA ULASZEWSKA DANIELE DEL RIO** SABINE E. KULLING** FULVIO MATTIVI***
urine of 11 subjects on consumption of apples by using LC-MS/MS with pure reference compounds. Phenyl-gamma-valerolactones, mainly as sulfate and glucuronic acid conjugates, reached maximum excretion between 6 and 12 after apple consumption, with a decline thereafter, and are still persistent 24 hours after apple consumption.
Significant differences were detected in the cumulative excretion rates within subjects and in the ratio of dihydroxyphenyl-gamma-valerolactone sulfate to glucuronide conjugates. This work observed for the first time the presence of two distinct metabotypes with regards to the excretion of phenyl-gamma-valerolactone phase II conjugates.
These metabolites could be the real determinants of health effects connected to apple consumption; our results demonstrate that these molecules, chemically equivalent to those produced by gut microbiota after consumption of cocoa, grape and green tea, are persistent at high concentrations up to 24 hours after apple ingestion.

In 2012, the European Community Regulation 1924/2006 authorised a health claim related to consumption of 200 mg of cocoa flavan-3-ols. From a bioequivalence point of view, it is estimated that the consumption of two apples per day provides the same amount of flavonoids and, therefore, it is possible to obtain the same health effects.
More information is available in the article published on Metabolites (2019) 9 (11): 254.
https://doi.org/10.3390/metabo9110254

KEYWORDS: nutrition, apples, gut microbiota SPECIES: Malus domestica

64
The wine is naked: flint glass bottle causes wine aroma identity degradation

Glass bottles played a key role in the wine industry, since it represented an icon packaging for wine and helped the winemakers to deliver to the consumers wines of quality and recognizable aroma identity. That is why the wines in glass bottles became so popular. Traditionally, the color of the wine bottle was green or amber. However, lately, there are commercial demands on the wine industry to use lighter/thinner and flint glass bottles. According to the marketing rules: “the consumers want to see the wine that they are purchasing and directly assess the color.” But is this a good idea?
For the scientists it is undoubted that light exposure can damage the quality of foodstuffs, shorten their lifetime, harm their nutritional value, and cause serious and irreversible sensorial problems. Already in the 70s, it has been proven that the lightstrike off-odor in wine is caused by chemical reactions induced by the light that passes through bottle glass. FEM’ metabolomic unit, together with other partners, ran 3 realistic supermarket shelf life experiments with white wines stored in flint and colored glass. In total about 1150 wine bottles were used, and were registered data in concern to the light and temperature exposure, the lightstrike sensory evaluation, the color, the oxygen, all the basic enological analysis, and of course the volatile profile using a modern GCxGC-Tof-MS instrument. The major output was that several important wine aroma compounds, so far considered stable, are quickly degraded already after one or two weeks of shelf life in flint glass bot-
tles. Dozens of volatile compounds, those bearing one or more double bonds in their chemical structure, are prone to photodegradation. Including several terpenes and norisoprenoids, key molecules modulating the flowery and fruity aroma of white wines. Therefore, losing such important aroma compounds, wine loses its identity and its ability to mask wine faults. Moreover, it was shown that the lightstrike wine fault might have more than one cause, that green glass bottles can provide a good protection for up to 50 days, and that temperature or position in the shelf (top or bottom) are not so critical factors. Winemakers do their best to deliver wines of high quality and recognizable identity. Till now they believed that temperature and oxygen are the main enemies of wine quality during its shelf life, but this study provided scientific evidence that the biggest wine quality enemy is light, when the bottle does not provide any protection. The discovery that light damages wine composition in such a dramatic way, will have a great impact on foodstuff, packaging and marketing research and production.
SILVIA CARLIN PANAGIOTIS ARAPITSAS URSKA VRHOVSEK FULVIO MATTIVI*
* Center Agriculture Food Environment, University of Trento, Italy
More info on PNAS (2022) 119 (29), e2121940119. https://doi.org/10.1073/pnas.2121940119
KEYWORDS: wine, shelf life, varietal compounds, lightstrike

65 FOOD AND NUTRITION
IULIIA KHOMENKO
EMANUELA BETTA
ANTONIA CORVINO
ANDREA DELL'OLIO*
REBECCA ROBERTS
PATRICK SILCOCK**
VINCENZO FOGLIANO*
VITTORIO CAPOZZI***
FRANCO BIASIOLI
Direct Injection Mass Spectrometry as a Green and High-Throughput Tool for the Monitoring of Fermentation and Bio-processes
The Sensory Quality unit of Edmund Mach Foundation is internationally recognized as a leading laboratory for the agro-industrial applications of Direct Injection Mass Spectrometry (DIMS), which is a green analytical approach that provides high sensitivity and allows for fast on-line monitoring of volatile organic compounds (VOCs). FEM now offers a complete facility for VOC monitoring based on DIMS, which includes sampling, analysis and data mining. Recent experiments demonstrated the usefulness of this facility for both on-line and off-line monitoring of bioprocesses, in particular of fermentation. Fermentation has been used for millennia to produce almost one-third of

all food products, contributing to the variety of the world’s enogastronomic heritage, assuming considerable economic, social, and environmental importance. Nowadays, fermentation is being repurposed as a sustainable strategy to improve food quality and safety.
During fermentation, microorganisms produce VOCs which can affect the sensory quality of the products. Therefore, VOCs monitoring in these matrices enables an improved understanding and control of i) the bioprocess dynamics of scientific and industrial relevance, ii) the quality/safety of the fermented foods and beverages, and iii) the flavour of final products. It can also support new product devel-
66
* Wageningen University & Research, Netherlands ** Department of Food Science, University of Otago, New Zealand *** Institute of Sciences of Food Production (ISPA - CNR), Italy
opment and the design of meat and dairy analogues, promoting innovation in this dynamic sector.
Ongoing researches, including work under the PNRR initiatives, aims to improve our understanding of fermentation processes and VOC generation pathways, that is to study i) the impact of different starter cultures and diverse microorganism/food matrix combinations, ii) the flavouring potential of new microbial strains, iii) the volatilome of bacteria, yeasts, filamentous fungi, also as a strategy to monitor microbial interactions. For instance, recent results include a) the demonstration of the possibility of real-time monitoring of the biotransformation of terpenes by yeasts during beer fermentation, b) high-throughput detection of VOCs production by different combinations of Saccharomyces and non-Saccharomyces strains in wine, and c) of microbial resources in the production of kefir-like plant-based vegetables. Lately, in collaboration with WUR
(Wageningen University and Research), we demonstrated the ability to use DIMS for the investigation of gut microbial fermentation, paving the way for efficient real-time ex vivo studies of anaerobic gut microbiota. By tracking the release of small molecules when bacteria are exposed to various dietary fibres, we were able to better understand microbial consortia behaviour.
Microbial-based processes are key technologies for sustainable future food production. DIMS approaches, offering a time-saving and low-impact analytical approach, can promote innovation in this field of food biotechnologies, supporting green transition of agrifood systems. The DIMS facility at FEM is well-equipped to efficiently support both investigation on fundamental aspects and industrial exploitation of new bioprocesses. Together, these efforts can help ensure that food production meets the needs of a growing population and of future generations.
KEYWORDS: fermentation, microbial communities, food biotechnologies
Systematic Innovations for a SusTainable reduction of the EuRopean food waStage
Food loss and waste (FLW) is one of the great paradoxes of the XXI century: around 931 million tonnes of food waste (FW) were generated in 2019 which is about 17% of the global food production. If we add food losses (around 14% of produced food) during post-harvest stages up to retail stage (excluded) we reach a frightening result: one-third of produced food is lost and/or wasted. This food would be sufficient to feed twice the number of undernourished people across the globe. Even worse, the average FLW per capita has almost doubled since 1960. In the EU, nearly 57 million tonnes of FW are generated
annually with consumers being the major responsible with an average of 73 kg per capita. This waste has a huge economic, social and environmental impact: when food is wasted the resources and the emissions used to produce, transform, store and transport it, are also lost.
SISTERS (“Systematic Innovations for a SusTainable reduction of the EuRopean food wastage”) is a 5-year EU project which includes 18 partners from 8 different countries and aims at reducing FLW along the whole European supply chain of fresh produce. It proposes new tools for farmers to promote direct and short
67 FOOD AND NUTRITION
MICHELE PEDROTTI ISABELLA ENDRIZZI EMANUELA BETTA JESSICA ZAMBANINI DANNY CLICERI* EUGENIO APREA*
IULIIA KHOMENKO FLAVIA GASPERI* FRANCO BIASIOLI
* Center Agriculture Food Environment, University of Trento, Italy
chain sales, new technological innovations in packaging for producers and retailers and awareness campaigns for retailers and consumers. Edmund Mach Foundation, in collaboration with Trento University, put all the skills of the Sensory Quality unit into play, from sensory to instrumental analysis, to validate the performance of smart logistic solutions. These solutions combine innovative packaging (the “BulkBox” and the “Storebox”) with cutting edge-sensors, to produce and control passive modified atmosphere to extend shelf life of perishable products such as vegetables and fruits.
FEM is also investigating the performance of a new bio-based food packaging to support the development of a transparent, flexible and home-compostable polylactic acid matrix which will better maintain
freshness, sensory quality and safety of perishable products than petroleum-based conventional packaging. Finally, an online survey for more than 1200 participants from 6 European countries (Belgium, France, Germany, Italy, Spain, and Sweden) will identify the intrinsic and extrinsic factors that drive environmentally friendly food packaging adoption in European consumers, with a specific focus on bioplastics.

Reducing FLW is critical to achieve more sustainable food systems and to reach different Sustainable Development Goals (SDGs) including the SDG Target 12.3 (halving food wastes). The SISTERS project is a key EU project in this direction, aiming at reducing FLW by 27.4% and CO2 emissions by around 20% in the case studies. The SISTERS community will contribute to the fight against FLW.
KEYWORDS: food loss and waste, food quality, sustainability
68
Linking food preferences of Italians to physiological and psychological factors: evidence from populationbased studies
Shedding light on the determinants of food choices is critical to promote healthier diets and countering the worldwide spread of diseases linked to poor nutrition. To this end, the Sensory Quality unit of Edmund Mach Foundation has contributed in recent years to various large-scale studies aimed at elucidating the physiological and psychological basis of the interpersonal variations that exist in the perception and acceptance of odours and tastes.
Notably, within the framework of the Italian Taste project, the research focussed on exploring the relationship between liking and sensory perception in 4 food models, each proposed at 4 intensity levels for a target sensation in more than 2000 participants (59% women, 18-60 y/o). The data indicated how liking varies as the perceived intensity increases with different trends depending on the product and the target sensation considered. Furthermore, it was possible to identify, for each product, groups of consumers presenting different sensory-hedonic patterns which have proved to be effective in predicting the level of satisfaction for a variety of food products.
The research activities also focused on selective eating behaviours linked to negative health outcomes, which lead individuals to be unwilling to try unfamiliar (food neophobia; FN) and familiar (picky eating; PE) foods. To make up for the scarcity of data on the incidence of PE in Italy, we validated the first psychometric tool measuring the endorsement of PE behaviours within the Italian adult population by involving a large cohort of more than 1000 individuals (69.9% women, 18-75 y/o). Besides confirming previously known psychosocial correlates of PE, we here also provided the first empirical evidence of a positive link between PE and adherence to the Mediterranean diet. We also explored the associations between FN, trait anxiety, olfactory functions and retronasal aroma release from a reference food in 83 adult volunteers (57.8% female, 22-68 y/o) with different degree of FN (low, medium, high). The results evidenced that FN positively associated with anxiety-related physiological responses but negatively with global olfactory performances and the extent of retronasal aroma release, thus supporting the hypothesis that neophobics’

69 FOOD AND NUTRITION
ISABELLA ENDRIZZI LEONARDO MENGHI* DANNY CLICERI* EUGENIO APREA* FLAVIA GASPERI*
* Center Agriculture Food Environment, University of Trento, Italy
EUGENIO APREA*
DANNY CLICERI*
IULIIA KHOMENKO
ISABELLA ENDRIZZI
FRANCO BIASIOLI
FLAVIA GASPERI*
conflictual relationship with food is driven by higher levels of negative emotional activation elicited by the sensory qualities of foods rather than by different chemosensory abilities.
Altogether, these results represent the scientific contribution of the FEM Sensory Quality unit in understanding food choices to promote healthier eating behaviours.
In the upper panels the tasting and evaluation phases by a panelist who wears the cannulas for sampling the air exhaled from the nose. Below the three spectra of the trans-2-hexenal recorded for the oil as it is and in combination with bread or chickpeas and the average sensory profile for the herbaceous aroma of the three food matrices
More info on Foods (2022) 11(15), 2174. https://doi.org/10.3390/foods11152174

KEYWORDS: food choices, liking, food neophobia
Dynamic methods to study the evolution of sensory perception during the tasting of extra virgin olive oil in combination with other food


A high quality extra virgin olive oil is distinguishable by its characteristic intense fruity aroma, resulting from the composition in volatile organic compounds, and by the bitter and pungent sensations, given by the high content in polyphenols. Olive oil is commonly consumed as a condiment or in combination with other food products, therefore it is important, in
order to fully appreciate its culinary potential, to describe its sensory characteristics in combination with other food matrices. Furthermore, it must be considered that tasting, as well as the experience of consuming a food, is a dynamic process which, in order to be correctly described, needs methods that capture the temporal evolution of sensations.
70
* Center Agriculture Food Environment, University of Trento, Italy
The approach proposed within the Ager2 VIOLIN project was to combine sensory evaluation with a dynamic descriptive method and the analysis of volatile compounds released during the tasting of 2 oils, previously characterised and selected to be different from a sensory point of view. The evaluations were conducted both with the oils as they are and in combination with chickpeas or bread. A panel of trained judges evaluated each sample using the “Temporal Check-All-That-Apply” (TCATA) method, providing a temporal description of the sensations that alternate during tasting. At the same time, the concentrations of volatile compounds present in the exhaled air (nosespace) were monitored through a cannula inside the nasal cavity of the panellists by means of a direct injection mass spectrometer, in our case a PTR-ToF-MS. This approach has allowed us to understand how the different food matrices can influence the sensory description of oils. For
example, it has been observed that bread enhances the pungency of the oil while chickpeas dampen it, however, due to bitterness and astringency, no obvious effects were seen. The combination with the analysis of the nose space has also allowed us to understand the role of some volatile compounds in the perception of some descriptors. For example, we observed that the herbaceous aroma of the oils that increases in the presence of bread and decreases in combination with chickpeas is evident in parallel with the evolution of the intensity of the signal attributable to the trans-2-hexenal in the nasal cavity of panellists.
The combined approach of sensory and instrumental dynamic techniques allows us to investigate the complex process underlying perception and to study the mechanism responsible for the sensory characteristics of oils in situations close to those of normal consumption.
More info on the official website project: https://olivoeolio.progettoager.it/index.php/i-progetti- olio-e-olivo/ violin-valorization-of-italian-olive-products-through-innovativeanalytical-tools/violin-il-progetto

KEYWORDS: olive oil, sensory analysis, volatile compounds
Multidimensional natal isotope niche reflects migratory patterns in birds
Measuring natural stable isotope ratios in animal tissues allow estimation of species ecological and trophic niche. In migratory species such as birds, stable isotopes can carry information at continental scales. In a study carried out in the labs of Traceability unit of Fondazione Edmund Mach, it has been measured natural stable isotopes of hydrogen (δ2H), oxygen (δ18O), carbon (δ13C), and nitrogen (δ15N) in juvenile feathers of 21 bird species collected at a
migratory stopover in the Italian Alps. It was examined if trends in individual isotopes reflected known migratory strategies and whether the breadth of dietary (δ13C–δ15N) and geographic (δ2H–δ18O) niches differed among long-distance (trans-Saharan) and short-distance (intra-Palearctic) migrants.
In both long- and short-distance migrants, δ2H declined with capture date, indicating that northern populations reached the southern stopo-
ALESSANDRO FRANZOI
PIETRO FRANCESCHI
KEITH A HOBSON*
PAOLO PEDRINI**
FEDERICA CAMIN***
LUANA BONTEMPO
* Environment and Climate Change Canada, Innovation Blvd., Canada
** MUSE – Science Museum, Trento, Italy
*** Center Agriculture Food Environment, University of Trento, Italy
71 FOOD AND NUTRITION
STEFANO LARSEN
ver site later in the season. This kind of migratory behaviour is known as a Type-I migration strategy. Values of δ2H indicated that the breeding range of trans-Saharan migrants extended farther north than short-distance migrants. Overall, species dietary niche breadth did not differ among
migratory groups, but trans-Saharan migrants displayed wider geographic niches, suggesting that long-distance migration is linked to broader ecological niches. Finally, it was found no relationship between the amplitude of isotope species niches and population temporal trends in Europe, suggesting that conditions in the breeding grounds, as inferred by stable isotopes, are not the only determinant of species’ long-term persistence.
This research activity demonstrates that ringing activities and isotopic measurements of migratory passerines represent a unique opportunity to investigate large-scale life-history phenomena relevant to conservation.
More information is available in the article published in Scientific Reports (2021) 11, 20800. https://doi.org/10.1038/s41598-021-00373-9
KEYWORDS: passerine birds, fall migration, isotopes


Cheese and superfoods: enrichment of caciotta-like cheeses with cornelian cherries and black currants to obtain cheeses enriched in polyphenols
The development of dairy products supplemented with plant-based ingredients has achieved particular appeal among consumers. These types of ingredients/supplements, have to be generally recognized as safe, must impart flavour and/ or colour and better if they are superfoods able to have benefits for human health. Blackcurrants (Ribes nigrum) and cornelian cherries (Cornus mas) have a distinctive flavour, deep blue and red colour, and have high bioactive polyphenols amounts. For these characteristics they could be excellent candidates for enrichment of dairy products. In particular, polyphenols are one of the few nu-
tritional compounds that dairy products are missing. Our idea was to add different amounts of blackcurrant or cornelian cherries (0.3 and 0.6% dry weight / weight of vat milk) to some caciotta-like cheeses, at the extraction of the curdle before shaping in cheese-wheels in order to have a new, more “attractive” product good for human health.
However, the change in a consolidated recipe of a traditional product such as the caciotta can always involve risks because nothing is known about the impact that blackcurrants and cornelian cherries can have on the final product. Therefore, after a month ripening, we evaluated not
72
ELENA FRANCIOSI TIZIANA NARDIN* ROBERTO LARCHER* JONAS ANDERSEN ANDREA MANCINI PAVEL SOLOVYEV LUANA BONTEMPO
* Technology Transfer Centre, Fondazione Edmund Mach, Italy
only the polyphenol amounts, but also the microbial composition, to understand if the blackcurrant and the cornelian cherries could interfere with the correct fermentation of the caciotta, and the organoleptic aspects to evaluate any influences on taste and smell.
Polyphenols were determined using the Folin-Ciocalteu spectrometric method; the microbial community was determined by plate count and the composition was determined by nuclear magnetic resonance (NMR) spectroscopy. The caciotta-like cheeses were also tasted by an untrained panel.

The caciotta-like cheeses enriched with blackcurrant and cornelian cherries showed an increased content of polyphenols and furthermore, with our surprise, when blackcurrant was used as supplement, it was able to promote the growth and develop-
More info: Frontiers in Nutrition (2022), 9. https://doi.org/10.3389/fnut.2022.1023490

KEYWORDS: caciotta-like cheese, polyphenols, lactic acid bacteria
SPECIES: Ribes nigrum, Cornus mas
ment of lactic acid bacteria and of all the products deriving from the bacterial metabolism (organic acids, amino acids, gamma-aminobutyric acid). Furthermore, the enrichments did not affect the taste and smell of the caciotta-like cheeses and their correct maturing.
In progress are work of caciotta-like cheeses modelling, to test higher amounts of blackcurrant and cornelian cherries and other local berries as ingredients.
Extra virgin olive oil isotopic fingerprint
Extra virgin olive oil is a key product in the European Union (EU) market, since Europe is the main olive oil exporter and consumer worldwide and around 98% of the world’s olive trees are concentrated in the Mediterranean Basin. This product enjoys global recognition due to its nutritional value and beneficial effects on health, however due to increasing fraud scandals, consumers have lost confidence in the authenticity of olive oil. To protect ethical producers and consumers, European rules require that the origin of extra virgin and virgin olive oils must be declared on the
label. Specifically, it must be stated whether the oil originates in a specific European Member State or a non-EU country and whether it is a blend of European Community and/or non-EU olive oils, as appropriate.
Official olive oil quality control methods are based on quantitative analysis of specific chemical compounds but these parameters do not allow verification of the geographical origin of olive oils. Indeed, at the time no official analytical method could verify whether a sample had been produced in the EU or outside the EU and there is increasing demand for
73 FOOD AND NUTRITION
LUANA BONTEMPO MAURO PAOLINI PIETRO FRANCESCHI LUCA ZILLER FEDERICA CAMIN*
* Center Agriculture Food Environment, University of Trento, Italy
Caciotta-like cheeses added with different amounts of cornelian cherries
the development of an analytical approach capable of effectively verifying claims of origin.

The analysis of stable isotope ratios of light bioelements (hydrogen, carbon and oxygen) using Isotope Mass Spectrometry (IRMS) enable tracing food products of different geographical origin. This differentiation capacity is based on the fact that the isotopic ratios in compounds present in nature have different values depending on the origin (latitude, altitude, distance from the sea), the climate (temperature, humidity, rainfall) and the geological characteristics
of the area of origin, the fertilisation practices adopted (organic/mineral fertilisation). One of the very recent trends in isotopic analysis based food authenticity testing is compound-specific isotope analysis. Indeed it has been observed in several studies that compared to bulk samples, additional isotopic information can be obtained by focusing on isotopic signatures of specific food compounds.
In a study carried out in FEM, the isotopic ratios of carbon, hydrogen and oxygen were analysed in bulk olive oils as well as the isotopic ratios of carbon and, for the first time, also of hydrogen in the four main fatty acids (linoleic, oleic, palmitic and stearic acids). The isotopic composition of olive oils was successfully used to distinguish samples originating from the EU and outside the EU. Specifically, when bulk data were combined with the innovative fatty acid isotopic data the differentiation power of the method improved clearly. This separation is due to the specific isotopic fingerprint of the individual countries making up the EU and non-EU samples.
More information can be found on Food Chemistry (2019) 276, 782-789. https://doi.org/10.1016/j.foodchem.2018.10.077
KEYWORDS: olive oil, geographical origin, isotopes

PROMEDLIFE: Novel food products for the PROmotion of MEDiterranean LIFEstyle and healthy diet
The Mediterranean diet has long been considered a landmark in healthy nutrition, but the younger population lost the connection with traditional foods while older people experience life changes that result in significant swaps in their diet. Both groups could benefit from a diet rich in antioxidants that has been shown
to help prevent disease over the long term. PROMEDLIFE aims to reverse, through a multi-actor approach, the decline in adherence to the Mediterranean diet pattern considering cultural regional specificities and applying validated approaches in different cultural environments. The PROMEDLIFE consortium is coordi-
74
LUANA BONTEMPO ALBERTO RONCONE LARA FONTANA FLAVIA GASPERI* ISABELLA ENDRIZZI
* Center Agriculture Food Environment, University of Trento, Italy
nated by the Research and Innovation Centre of Fondazione Edmund Mach and comprehends 12 partners from the five Mediterranean countries: Italy, Slovenia, Morocco, Tunisia and Greece. Within the project four lines of intervention will be adopted: 1) The project will analyse socio-economic, cultural and personal factors driving consumers in adopting a healthy lifestyle. 2) It will promote tailored and country-specific actions using “learning through play and living labs approaches” targeting primary and high school students and their families/carers. 3) Part of the work will be devoted to creating new healthy snacks targeted at young and older adults, based on traditional Mediterranean premium ingredients (saffron, dates, argan oil, selected vegetables). The products will be tested in each country in terms of acceptability and ability to promote healthy choices as well as characterised chemically and according to their bioactivity. New cultivation technologies and agronomical practices (i.e. soilless culture approaches and selection of local varieties) and innovative
food processing technologies will be applied and tested. 4) PROMEDLIFE will codify and valorize local Mediterranean products through the development of food labelling using innovative tools to increase people’s connection with their cultural and local heritage and improve awareness of food healthy choices. Revisiting the Mediterranean diet proposed in a more modern and appealing way through a transversal approach will guarantee the link between the innovativeness of PROMEDLIFE and the productive sector. PROMEDLIFE will aspire to understand the factors affecting consumers’ healthy choices and turn to education to promote adherence to Mediterranean lifestyle in the young generation and their families. PROMEDLIFE will conserve local biodiversity and exploit its uniqueness for both cultural and regional economic development while improving the value chain and market competitiveness of locally produced sustainable Mediterranean food. This project is part of the PRIMA programme supported by the European Union.
More information on the website https://promedlifeproject.eu

KEYWORDS: Mediterranean diet, education, eating habits

75 FOOD AND NUTRITION

BIODIVERSITY, ECOLOGY AND ENVIRONMENT

Ice is not just ice - quality changes due to climate evolution
Climate change shortens ice thickness and ice duration in lakes and rivers. In addition, not only ice quantity but also ice quality changes. The IceBlitz project, promoted by the GLEON community (Global Lake Ecological Observatory Network), analysed changes in ice quality for 31 lakes from the Northern Hemisphere – including Lake Tovel, a long-term ecological research site – during winter 2020/2021 that was one of the warmest winters since 1880. With winter progressing, black ice, formed by freezing water, diminishes while white ice, formed by melting and freezing of precipitation, increases. This increase in the thickness of white ice is attributed to air temperatures varying around the freezing point, especially during warm win -


ters. While black ice is very stable, white ice is unstable and supports less weight. Considering these differences, it is important to monitor the relationship between both ice types. With increasing thickness of white ice because of climate change, the risk for falling through ice increases for humans and animals walking on ice that has a reduced bearing strength. Furthermore, while black ice is transparent to light, white ice blocks light. This reduction in light under ice is important for primary producers. Formulas for the calculation of the bearing strength and light transparency do not consider ice quality. The IceBlitz study proposes changes to these formulas to consider the importance of black and white ice.
KEYWORDS
78
ULRIKE OBERTEGGER
More info on Nature Communications (2022) 13(1), 4974. https://doi.org/10.1038/s41467-022-32633-1
Winter 2017, Lake Tovel with black ice and ice scratches from ice skating
change,
: ice cover, climate
LTER site Lake Tovel
White-clawed crayfish management in Trentino: an integrated ecological approach
The crayfish Austropotamobius pallipes complex is the largest native invertebrate in Italian freshwaters, classified by the IUCN Red List as endangered (EN) because the species has suffered an reduction of more than 50% of its global distribution over ten years. To reduce the risk of extinction in the medium- to shortterm, the European Habitats Directive requires the implementation of management measures, and the designation of special areas of conservation for this species.
The first three-year period of application of the “White-clawed crayfish Management Plan in Trentino” (document prepared within the framework of the European Life+T.E.N. Project) was implemented by FEM in the summer-autumn of 2019-2021
by monitoring the populations of A. pallipes and its preferred habitats to determine the conservation status of the species, identify threats, and define conservation actions. Following the procedures outlined in the Plan, the presence/absence of the species and environmental characteristics of the habitats were surveyed in 145 water bodies potentially suitable for the presence of A. pallipes. Subsequently, for 38 of the 42 recorded populations, abundance was measured with one or two annual replicates, and biometric data were collected. In addition, tissue samples were taken and analysed for the genetic characterisation of the populations, essential for planning the restocking and reintroduction activities forecasted for the 2023-2025,

79 BIODIVERSITY, ECOLOGY AND ENVIRONMENT
MARIA CRISTINA BRUNO ANDREA GANDOLFI MATTEO GIRARDI IRENE LO PRESTI LUCIA ZANOVELLO STEFANO CASARI HEIDI C. HAUFFE
An adult male of Austropotambius pallipes (photo of Marco Omodei Salè)
since these actions will be based on genetic congruence between source and recipient populations.
To identify the presence and intensity of threats to the current populations of A. pallipes, detecting the spread and transmission of pathogens is paramount. Of particular concern is the oomycete Aphanomyces astaci, the aetiological agent of the crayfish plague, the most important infectious disease of freshwater crustaceans and cause of mortality among indigenous White-clawed crayfish populations. This pathogen is carried by the introduction of two allochthonous species of North American origin, Procambarus clarkii
and Faxonius limosus, both of which are present in Trentino, but currently confined to a small number of lakes. The early detection of the presence of A. astaci is fundamental for the control and management of the impacts caused by this pathogen. An experimental protocol based on environmental DNA (eDNA) barcoding techniques (which require the field collection and filtering of water samples potentially containing A. astaci spores) to detect the presence of this pathogen has been optimised here at FEM, with positive preliminary results. This methodology will be perfected during the second three-year monitoring period.
KEYWORDS: Habitats Directive, White-clawed freshwater crayfish, invasive species, in situ conservation
SPECIES: Austropotamobius pallipes, Procambarus clarkii, Faxonius limosus
A new alien species in the waters of Lake Garda: first report of Dreissena bugensis (quagga mussel) in Italy

The invasion of new organisms in aquatic ecosystems, often from distant geographical areas, is one of the factors that can contribute to the loss of biodiversity.
Recently, a new species of bivalve mollusc arrived in Lake Garda, where researchers of the Edmund Mach Foundation, first detected its DNA in the water and, a few months later, found several specimens in the littoral zone. The name of the species is Dreissena bugensis Andrusov, 1897 (quagga mussel) and this is the first occurrence south of the Alps. The specimens col-
lected were classified both by observation of shell morphology and by genetic and phylogenetic analysis, using the mitochondrial COI gene. This species joined the congener Dreissena polymorpha Phallas, 1771 (zebra mussel), which was first collected in Lake Garda in the 1970s. The two species, native to the Pontic-Caspian region, share similar habitat requirements, but the quagga mussel quickly replaced the zebra mussel in most colonised regions, as happened in Lake Constance. This greater competitiveness has been attributed to physiolog-
80
ADRIANO
MASSIMO PINDO NICO SALMASO
BOSCAINI
Dreissena specimens
ical differences that allow the quagga mussel to reproduce in winter and to reach greater depths.

Dreissenids are considered aquatic ecosystem engineers, because of their strong impact on benthic habitats and resource availability for other species, also causing damage to human infrastructures, e.g., by clogging pipes. The main features of the quagga mussel are the rounded shape of its shell, the surface of which is decorated with alternating light and dark bands. In contrast, the zebra mussel’s shell has a more angular shape, with alternating light and dark stripes forming a zigzag pattern, and with the two valves joining
in the ventral side to form a straight line. Both species reproduce by releasing eggs, which give rise to planktonic larvae (veligers) that live freely in the water until they settle on the bottom and attach themselves to the substrate with a byssus secreted by special glands. Veligers can be accidentally transported inside the hulls of boats, while adults can attach themselves to the outside, facilitating their spread to other non-colonized watersheds when boats are moved from one lake to another. Specific measures such as information campaigns for boat owners and mandatory boat cleaning are therefore urgently needed.
More information can be found in the article published in BioInvasions Records (2022) 11(4): 1031-1044. https://doi.org/10.3391/bir.2022.11.4.21
KEYWORDS: invasive species, mitochondrial COI, Lake Garda
SPECIES: Dreissena bugensis, Dreissena polymorpha

81 BIODIVERSITY, ECOLOGY AND ENVIRONMENT
Ponar grab sampler
Potentials and challenges of permafrost dependent Alpine water resources

The Alps represent a hot-spot of climate change, the most striking effect of which is represented by the progressive thawing of glaciers, exacerbated in recent years by decreasing atmospheric precipitation. While, at present, glaciers represent the main hydrological driver at the Alpine level, it is predicted that after 2050 their thawing will be so advanced that the equivalent volume of water contained in permafrost (soil that remains frozen for at least two consecutive years) will exceed that of glaciers. In the coming decades, therefore, the water contained in the form of ice in the dominant type of alpine permafrost, i.e., “rock glaciers,” could represent a non-negligible reserve due to the lower thawing rate of this sub-surface ice compared to that of glaciers. Nonetheless, processes associated with permafrost degradation affect the physical, chemical and biological quality of meltwater. Recent research, also conducted by Edmund Mach Foundation, has shown that rock glacier melt waters have high concentrations of solutes, ions, and numerous trace elements, which can affect the aquatic biodiversity (e.g. of
bacteria and microalgae) and sometimes preclude the use of local water resources for drinking purposes.
The study of the seasonal dynamics of solute and trace element quantities and their effects on the biodiversity and functionality of permafrost-influenced high-altitude water communities is the main objective of the Euregio project “ROCK-ME” (https://rock-glaciers-euregio.fmach. it), designed and coordinated by the University of Bolzano and the FEM Hydrobiology Unit, with the participation of the Austrian Academy of Sciences in Innsbruck. The project, which started in April 2022, is based on a space-by-time substitution approach, in which the three alpine catchments under study (Jamtal in North Tyrol, Schnalstal/Val Senales, and Martelltal/Val Martello in South Tyrol), characterised by a decreasing gradient of glacier occurrence and the presence of intact and relict rock glaciers, are a proxy for future alpine deglaciation conditions. The project combines high-frequency hydrological and chemical investigations with biological investigation based on both the classical and the metagenomic approach to study aquatic biodiver-
82
DAVIDE ALBANESE LUANA BONTEMPO LEONARDO CERASINO CLAUDIO DONATI ALFREDO MAULE
PINDO MARIA CRISTINA BRUNO
MONICA TOLOTTI
MASSIMO
Picture of the Lazaun active del rock glacier, Schnalstal/Val Senales (photo by M.C. Bruno)
sity and the molecular mechanisms of heavy metal resistance in aquatic microbial communities.
The results of the first study year confirm the chemical and biological peculiarities of rock glacier melt waters

in the three study catchments and suggest a negative effect of the exceptional weather conditions of 2022 (high temperatures and drought) on both the abundance and diversity of alpine aquatic microorganisms.
Further information available in the papers published in Science of the Total Environment (2020) 717, 137101. https://doi.org/10.1016/j.scitotenv.2020.137101
KEYWORDS: permafrost, rock glaciers, water resources
The aerobiological monitoring for the survey of invasive species: the case study of mugwort


The composition in plant species, known as plant biodiversity, in an area is changing due to land use or habitat variations often, directly or indirectly, human-induced. A useful means to estimate plant biodiversity and its variations is through the analysis of airborne pollen and its quantities, which allow to identify the plants that grow in the catchment area, and that produced it. An effective example for the use of aerobiological data to evaluate biodiversity changes and to monitor the occurrence of invasive species is the
study, focused on mugwort pollen, carried out by the Environmental Botany research unit. Mugwort herbaceous plants comprehend different aromatic species, in the daisy family Asteraceae, alternatively Compositae. Mugwort produces allergenic pollen, which can cause rhinitis in sensitive individuals. Ten different Artemisia species are growing in the Trento province, some of them native, some from other countries, mostly colonising wasteland and anthropized areas. The Artemisia species mainly relevant for the pollen production
83 BIODIVERSITY, ECOLOGY AND ENVIRONMENT
ANTONELLA CRISTOFORI FABIANA CRISTOFOLINI MARIA CRISTINA VIOLA ELENA GOTTARDINI
are the common mugwort ( Artemisia vulgaris) and two Asian exotic species, the annual mugwort ( Artemisia annua) and the Chinese mugwort ( Artemisia verlotiorum). In the Trento province, the common mugwort is the earliest flowering species, during August, while annual and Chinese mugwort flower during September and October. The quantities of airborne pollen from these species have shown a seasonal trend characterised by two concentration peaks, which have changed considerably in terms of reciprocal proportions during the past years.
While in the 90’s a strong prevalence of mugwort pollen was evident during August, in recent years a reversal of the situation happened. As highlighted by the aerobiological analyses, in 1993 the peak of artemisia pollen concentration was happening
in August, while in 2019 a drastic change is evident, with a higher mugwort pollen concentration during late September and October. This relevant variation in the presence of mugwort pollen in the air can be linked to different factors: it is possible to speculate that the spread of the two invasive species of Asian origin (annual and Chinese mugwort) has been gradually increasing, or that climatic conditions have favoured their flowering, resulting in greater pollen production. Results may impact on allergic symptomatology, both because of the different specific composition (leading to a potentially different allergenicity) and because of the increasing length of the season with significant amounts of pollen, prolonging discomforting symptoms into the fall season.
More information in the paper published in Aerobiologia (2020)International Journal of Aerobiology 36, 669-682.
https://doi.org/10.1007/s10453-020-09663-7

KEYWORDS: pollen, allergy, mugwort SPECIES: Artemisia vulgaris, Artemisia annua, Artemisia verlotiorum
High-elevation pollen
The study of airborne biological particulate matter is often limited to urban areas at low altitudes, and little information is available for remote and mountainous areas. Knowing how many and which pollen types are present in the air at a certain time of the year allows us to indirectly study the plant biodiversity and its variations over time, including the presence of alien and invasive species. The aerobiological data obtained is also important for allergy sufferers because they allow the most appropriate measures to be taken aimed at limiting the exposure to allergens and the allergy symptoms.
In order to obtain data referring to high-altitude environments and thus
start to fill this knowledge gap, the Fondazione Edmund Mach has undertaken a study aimed at characterising the biological quality of air in the alpine environment. To this end, aerobiological studies are carried out in Val di Rabbi - in agreement and with the support of the Trentino sector of the Stelvio National Park and the collaboration of Provincial Agency for Environmental Protection (APPA) of Trento -, and at four alpine refuges - in collaboration with the Società Alpinisti Tridentini (SAT) and the Mountain Environment Protection Commission (TAM). The study sites are located at an altitude between 1200 and 2600 m a.s.l., and sampling is carried out on a weekly basis, from
84
ELENA GOTTARDINI ANTONELLA CRISTOFORI FABIANA CRISTOFOLINI
June to September, using Sigma-2 passive samplers which are particularly suitable for studies in remote areas. The sample analysis takes place both by optical microscopy, which allows the taxonomic identification and quantification of pollen grains, and by eDNA metabarcoding techniques in order to improve the precision level of pollen identification.
The first results obtained through the optical microscopy show a total of 65 different types of pollen in the airborne samples; the prevalent pollen grains appear to belong to the grasses and nettle family, known for their allergenicity. It has also been observed that the period of presence of pollen in the air at high altitude is distinctly shorter than at
the valley floor, with the highest values concentrated mainly in July and gradually decreasing in the first half of August.
The integration of these data with the results of molecular biology techniques will allow for a more precise characterization of the biodiversity and to provide even more detailed indications on the levels of exposure to pollen at high altitudes for a better management of pollen allergies. This study is carried out within the National Biodiversity Future Centre, NBFC and received funding from the European Union Next-GenerationEU (PIANO NAZIONALE DI RIPRESA E RESILIENZA (PNRR) – MISSIONE 4 COMPONENTE 2, INVESTIMENTO 1.4 –D.D. 1034 17/06/2022, CN00000033).
KEYWORDS: pollen, biodiversity, Alpine environment

85 BIODIVERSITY, ECOLOGY AND ENVIRONMENT
Foresta 4.0
Trees perform multiple fundamental environmental functions including the regulation of biogeochemical cycles and climate, soil and biodiversity conservation, desertification prevention, in addition to the well known productive and cultural functions, such as timber production or the aesthetic enhancement of the landscape. Trees in fact, actively contrast the increase in the greenhouse effect, responsible for global warming, by sequestering atmospheric CO2 and hinder environmental degradation phenomena such as soil erosion, thus representing a natural solution to these problems (nature based solutions).
At the same time their functionality is negatively impacted by the rapidity of the ongoing ecosystem changes and in particular by extreme climatic phenomena associated with a growing mortality rate of trees observed widely in various regions of the world. Monitoring the state of trees means being able to quantify the environmental services provided and understand their response to climatic and environmental factors, possibly catching in advance phenomena of incipient decay. Nowadays this task

is possible thanks to the use of IoT (Internet of Things) sensors applied to individual trees which allow the continuous collection of data on the functional parameters of the plants and on the microclimatic conditions to which they are exposed. The forest observational network of the Edmund Mach Foundation in Trentino is based on the use of TreeTalker devices and currently consists of about 150 trees among beeches, spruces and silver firs located in the mountain vegetation belt and distributed in 6 sites between the Adamello Brenta and Paneveggio Pale di San Martino Natural Parks, the Lavarone plateau and the Val Di Cembra. The TreeTalkers are installed at 1.3 m from the ground and transmit hourly data about the trunk of the trees (sap flow, diameter variations, temperature and water content, oscillations), the spectrum of solar radiation transmitted under the canopy (12 bands), and the temperature and relative humidity of the air, with the possibility of optionally also monitoring the soil microclimate.
The Forest Ecology Unit is actively engaged in verifying and improving the quality of the data also through the development of innovative sensor systems that allow greater accuracy and reliability in the field. In projection, the use of these monitoring devices can also be extended to the detection of images and sounds (Imaging and soundscaping) in forests. The data provided by the TreeTalkers are part of a multiple spatial scale research approach, where the tree scale complements and completes the information that can be obtained from satellite images up to forest genomics in determining the functionality and biodiversity of forests and predicting their future evolution.
KEYWORDS: Internet of Things, biomonitoring , Alpine forests
SPECIES: Abies alba, Fagus sylvatica, Picea abies
86
LUCA BELELLI MARCHESINI LORIS VESCOVO MAURO CAVAGNA ISAAC CHINI ROBERTO ZAMPEDRI DAMIANO GIANELLE
The HIGHLANDER project
Highlander, an EU funded project started in 2019, leveraged on the use of High Performance Computing data processing to provide decision making and planning support for a smart and sustainable management of environmental resources. Through the use of HPC, Highlander generated short and medium term (decadal) climate forecasts including the likelihood of extreme events and related risks for natural assets. Climate data, satellite observations, and automated field data were integrated and analyzed using tools such as numerical models and machine learning algorithms creating a multi-thematic framework of highly detailed and harmonized data and indicators that supports environmental management.
The Forest Ecology Unit at FEM contributed to Highlander by developing and implementing remote sensing based tools for monitoring forests
and grasslands of Trentino. Moreover, tree ecophysiological monitoring in the Paneveggio Natural Park was implemented by IoT sensors and a digital platform for real time data visualization.
Regarding the use of remote sensing to monitor forest areas, first, a study aimed at exploiting remote sensing data to map forest windthrows caused by the VAIA storm was carried out. In particular, both optical satellite (i.e. Planet and Sentinel-2) and synthetic aperture radar (SAR) images (i.e. COSMO-SkyMed and Sentinel-1) were used to identify advantages and disadvantages of the different data. The analysis showed that remote sensing data are effective in detecting windthrows but there are also limitations related to the acquisition season and conditions.
Following the previous study, a novel method that exploits satellite data for

87 BIODIVERSITY, ECOLOGY AND ENVIRONMENT
DAMIANO GIANELLE LORIS VESCOVO MICHELE DALPONTE LUCA BELELLI MARCHESINI DANIELE MARINELLI DAVIDE ANDREATTA LORENZO FRIZZERA
bark beetle detection was developed. Bark beetle is a small insect that burrows into the bark to the point of killing the plant. The infestation affected 8000 hectares at the end of 2022. The tool analyzes the time-series of images searching for changes that can be associated with vegetation stress and in particular with a bark beetle infestation. The result of this analysis is a map that identifies not only past infestations but also new attacks. Moving to grasslands monitoring, a novel algorithm for mowing event
More info on the official website project https://highlanderproject.eu

detection using Sentinel-2 time series was developed and validated. The frequency of cuts is a key driver of floristic composition of meadows and can be used as an indicator of the floristic-faunistic value, the risk of abandonment and nitrate pollution. The developed system opens up new opportunities in the verification of cross-compliance of premiums allocated by the rural development plan and in the definition of policies and subsidies for grasslands.
KEYWORDS: High Performance Computing, Alpine environment, remote sensing, bark beetle SPECIES: Ips typographus
The ongoing climate warming is particularly amplified in the Arctic region where mean atmospheric temperatures have been rising at a double rate than globally and are forecasted to reach +5.3 ± 1.7 °C by 2100 under the RCP4.5 scenario thus triggering the thawing of permafrost, one of the largest stocks of organic carbon in terrestrial environments. Permafrost is defined as permanently frozen soil (at least for two consecutive years) and, in the arctic tundra, vegetation can grow during the short summers only thanks to the thawing of the active layer, a seasonally unfrozen topsoil layer, where plants debris accumulate and decompose slowly and partially. According to the most recent figures, the amount of carbon stocked in permafrost is about twice that found in the atmosphere of our planet in gaseous form. Carbon in arctic permafrost can originate from plant material dating back up to 50
thousand years ago, as in the case of Yedoma deposits, the most ancient yet vulnerable since ice and organic rich (about 2% of carbon by mass), which store about 25% of the whole permafrost carbon reservoir. Rapid climate warming accelerates permafrost thawing, mobilising its organic carbon and making it available for microbial activity, by which it is then partly emitted in the atmosphere as greenhouse gases (GHGs), mainly carbon dioxide (CO2) and methane (CH4), further increasing the radiative load on the atmosphere and generating a positive climate feedback loop. The expected emission of large quantities of CH4, a gas with a high climate warming potential, combined with the availability of more “ancient” carbon has attracted much scientific interest in the last decade and fostered new research efforts. The Siberian Arctic hosts most of the Yedoma deposits and water bodies make up to 50% of
88
Ancient carbon and greenhouse gas emissions from the permafrost of the Siberian tundra
LUCA BELELLI MARCHESINI
the land cover in some areas. These inland water systems (lakes, ponds, rivers) are considered intense GHG sources, especially of CH4, yet to date their role in the carbon balance of the arctic tundra remains very limited. Moreover, how much of the carbon stocked in the permafrost for centuries or even thousands of years is currently fueling the GHG emissions still remains an open question. A recent study, in which FEM took part, was carried out in the north-eastern Siberian tundra and revealed both the age of the carbon in the inland waters

as organic matter, CO2, CH4, and the magnitude of their emissions to the atmosphere. In areas of intense permafrost degradation, GHG emissions were associated to ancient carbon (4,800 and 6,000 years old for CH4 and CO2 respectively), however more than 80% of the emitted carbon was contemporary indicating it derived from the decomposition of biomass recently produced by the tundra vegetation. These results help to better understand the response mechanisms of arctic permafrost environments to climate warming.
More info on Nature Communications (2020)11: 1627. https://doi.org/10.1038/s41467-020-15511-6

KEYWORDS: climate change, permafrost, greenhouse gases
G-BiKE and COP-15
As part of the G-BiKE’s 4-years activity, FEM was present at the COP15 -Conference of the Parties to the Convention on Biological Diversity (United Nations Environment Program), Montreal (Canada), 6-19 December 2022. Hundreds of persons visited the G-Bike’s stand to learn about genetic diversity conservation: we had the chance to talk with policy makers, NGOs, representatives of indigenous groups and researchers from Canada, Switzerland, USA, Italy,
the EU, Norway, Costa Rica, Guatemala, Mexico, South Africa, Dominican Republic, Argentina, Botswana, and other countries. The main objective was to ensure that parties would adopt strong wording in Goals, Targets and Indicators related to genetic diversity in the final version of Global Biodiversity Framework. Moreover, a specific side event was organised, held on December 10 th , 2022. About 115 people attended in person and 100+ people attended
89 BIODIVERSITY, ECOLOGY AND ENVIRONMENT
A creative interpretation of the Siberian tundra as seen from space (original image: Landast/Copernicus)
CRISTIANO VERNESI
online, with translations in French, Spanish, Arabic and Mandarin. The side event presentations provided advice on how the genetic wording of CBD commitments can be scientifically accurate and measurable, with simple and affordable indicators developed by the international group. These indicators are meant to reflect genetic diversity change; one of their main features is that they can be calculated even in absence of DNA-based data by using some approximation offered by the census size of a population.
We provided support to the CBD parties during the negotiations, hence helping delegates adopt ambitious Goals, Targets, and Indicators. The results of G-Bike’s efforts are astonishingly reflected in the final inclusion of the following items in the approved
final document, officially known as the Kunming-Montreal Global Biodiversity Framework:
Goal A […] The genetic diversity within populations of wild and domesticated species is maintained, safeguarding their adaptive potential.
Target 4: […] to maintain and restore the genetic diversity within and between populations of native, wild and domesticated species to maintain their adaptive potential, including through in situ and ex situ conservation and sustainable management practices […].
Headline indicator A.5 for Goal A and Target 4: The proportion of populations within species with an effective population size > 500.
It is worth noting that before no explicit mention of genetic diversity of wild species was present, and no indicator was available for measuring

90
genetic diversity change. In its final year, G-BiKE’s team will keep working on deploying the headline indicator and other simple indicators and
More info on https://www.g-bikegenetics.eu

metrics for the conservation of populations and their adaptive potential through webinars, training, and publications.
KEYWORDS: genetic diversity, Wild species, COP-15, biodiversity
An eDNA-based protocol for monitoring amphibian species and genetic diversity
Wetlands host a wealth of natural biodiversity, and thanks to recent technological developments in the field of conservation genetics, the water itself can provide indispensable information for the management of the animal species that rely on these habitats for survival. It is now possible to extract DNA from a sample of water taken from a wetland, and identify which species live in or use the sampled habitat. In fact, ecological studies for conservation have been greatly enhanced by the recent development of these ‘non-invasive’ molecular techniques, i.e. the analysis of genetic material extracted from organic remains rather than taken from the tissues of whole organisms. This environmental DNA (eDNA) is naturally released by animals into their environment in cells dispersed in feces, urine, hair, feathers, skin fragments, body fluids, gametes and eggshells.
The project ‘WATER AND LIFE - innovative monitoring of the biodiversity in aquatic environments’, is the result of a collaboration between the Edmund Mach Foundation, the Science Museum of Trento - MUSE, and the UNESCO Biosphere Reserve Alpi Ledrensi and Giudicaria, with the aim of optimizing an eDNA protocol for the rapid and cost-effective
monitoring of aquatic organisms, including amphibians, in the Province of Trento.
During the spring and summer of 2019, water samples were collected from twenty sites in Trentino, including alpine lakes, peat bogs and livestock watering holes in mountain pastures. Each sample of 1-2 L was filtered through specialised filters (0.22 μm pore diameter) to allow the collection of DNA fragments dispersed in the water. The samples were then transferred to FEM laboratories, where the genetic material was extracted from the filters and sequenced. These sequences were then compared with those in the research unit’s database, allowing the identification of the species of amphibian present in each lake, wetland and pond.
Another aim of the study was to test whether the same eDNA approach could also provide data on the genetic diversity of amphibians. The European common frog, Rana temporaria, was chosen as the case study species. Even in this case, the protocol showed exceptional results: the number of genetic variants obtained from the new approach was closely correlated with that recorded during previous tissue-based studies from the same sample sites. There -
91 BIODIVERSITY, ECOLOGY AND ENVIRONMENT
LUCIA ZANOVELLO MATTEO GIRARDI GIULIO GALLA STEFANO CASARI DIEGO MICHELETTI HEIDI C. HAUFFE
ANDREA GANDOLFI
STEFANO CASARI
MATTEO GIRARDI
BARBARA CRESTANELLO
BARBARA SOFIA ILARDO
DIEGO MICHELETTI
HEIDI C. HAUFFE
fore, our research demonstrated for the first time that genetic variability of amphibians can also be estimated from eDNA. These results pave the way for obtaining fundamental

information, easily and rapidly, on the state of ‘genetic health’ of frogs, salamanders and newts, species currently threatened by climate change and human activities.
More info on Scientific Reports (2023) 13: 4346. https://doi.org/10.1038/s41598-023-31410-4
KEYWORDS: environmental DNA, biodiversity, European common frog SPECIES: Rana temporaria
MarmoGen: a scientific collaborative project supporting conservation and management of marble trout

The marble trout, Salmo marmoratus, is an endemic species of the Alpine region, facing crucial – and often conflicting – conservation and socioeconomic issues. According to The Red List of Italian Vertebrates, the species is critically endangered; however, it is also among the most prized game-fish for anglers. Natural populations of the species have suffered a marked demographic decline due to habitat degradation, aggravated
by further anthropogenic impacts. Among these, the long-standing practice of stocking commercial exotic trout lineages to sustain the angling activities has impacted the residual native populations, by introducing the problem of genetic hybridization. If habitat restoration measures are to play a primary role in the recovery of natural populations, restocking efforts through supplemental breeding activities remain a temporary but
92
Searching for amphibians in the Buse Lake, on the Manghen Pass, Province of Trento. The insert shows how water samples are filtered to capture environmental DNA
necessary measure for marble trout conservation. In this regard, genetic tools provide indispensable support for management and conservation planning.
The MarmoGen project (2017-2020) marked the beginning of a radical shift in the management and conservation methods of marble trout in South Tyrol, Italy, shifting from quantitatively oriented production of stocking material (monitored using traditional morphological traits) to a new paradigm, focussing on restoring the natural genetic background of wild populations. To guarantee the continuity of this restoration process, a long-term commitment is necessary; therefore, a new project, MarmoGen2, was also launched for the following three years (2021-2024).
The current project focussed on the assessment of the conservation status of the remnant marble trout populations in the entire South Tyrolean hydrographic network, including the collection and integration of population quantitative data and individual
phenotypic and genetic data. Residual marble trout standing stocks and the success of the restocking activities were quantitatively evaluated. During the supplemental breeding activities, wild spawners were genetically analysed and selected, thus limiting the propagation of hybrids. Overall, more than 5,000 specimens, representing different age classes, were sampled and analysed from 75 sites in South Tyrol, and over 550 breeders were selected among over 2,300 candidates. Protocols were shared with stakeholders, defining breeding pairs and fertilisation steps, aimed at maintaining genetic diversity and regulating management of captive breeding stocks, in order to avoid domestication. The maintenance of captive breeding stocks was oriented towards more natural-like models, including the morphology of the tanks, the maintenance density and the diet; in parallel, integral protection areas in natural habitats were also established.
KEYWORDS: genetic introgression, supplemental breeding, endangered species SPECIES: Salmo marmoratus

93 BIODIVERSITY, ECOLOGY AND ENVIRONMENT
A rare specimen of marble trout not introgressed genetically with the exotic brown trout
The MICROVALU project: evaluating microbiodiversity in alpine pastures
The Alpine pasture ecosystem is a complex, multidimensional habitat in which a multitude of animal and plant species interact with each other and with large numbers of bacteria, fungi and viruses (both commensal and pathogenic), forming a network that extends both above and within the soil.
Although the role of microbial communities (microbiota) of soil, plants and animals is known to contribute to the maintenance of essential ecosystem services for their hosts and the entire ecosystem, microbial biodiversity (microbiodiversity) of alpine pastures is still largely unexplored at both the individual species (plants, arthropods and wildlife) and ecosystem levels. Yet a better understanding of microbiodiversity variation in relation to soil characteristics and
key climatic parameters is of pivotal importance for predicting the effect of climate change on the biodiversity in this ecosystem.
The MICROVALU project, financed by GECT “Euregio Tirol-South Tyrol-Trentino” (2019-2023), led by EURAC Bolzano, and carried out in collaboration with the University of Innsbruck, aims to predict the impact of climate change on Alpine agro-ecosystems by studying the variation in microbiodiversity associated with soil, rhizosphere soil of two plant species (Carex and Festuca spp.), whole invertebrates (nematodes, collembolans, earthworms, beetles), and fecal pellets of vertebrates (hares, wild ungulates and livestock) collected at the LTSER (Long-Term Socio-Ecological Research) Val Mazia research site along an altitudi -

94
GIULIO GALLA HEIDI C. HAUFFE
Fieldwork activities at the 2500 slm sampling area of the long-term socio-ecological research site (LTSER) in Val di Mazia
nal gradient (1000 m - 2500 m asl). The study provides a holistic view of the microbiodiversity associated with this ecosystem and highlights the great diversity and composition of the microbiota associated with these main functional groups, as well as how microbiotas overlap between groups. For example, our diversity estimates show that soil, invertebrates and fecal pellets of wild and farm animals have distinct bacterial and fungal communities that overlap to different degrees depending on altitude. In addition, we also found significant differences in the abundance of multiple bacterial and fungal taxa at different altitudes

in soil samples and, to a lesser extent, in microbial communities associated with the other functional groups. Since different altitudes can be considered proxies of a range of climate scenarios, our data suggest that climate change may affect the composition of microbial communities across functional groups associated with the alpine pasture ecosystem. We are currently analysing the effects of various biotic and abiotic factors on the microbiodiversity of these pastures to understand in detail how and why these communities are interconnected, so that the results can be applied to the future management of this agroecosystem.

For a detailed description, see Scientific Reports (2023) 13: 4056. https://doi.org/10.1038/s41598-023-30916-1
KEYWORDS: metataxonomy, microbial ecology, wildlife
Left panel: The long-term socio-ecological research site (LTSER) in Val di Mazia. Right panel: PCoA generated from preliminary diversity estimates on LTSER fungal communities highlighting the differentiation of the soil (brown), rhizosphere (green) and bovine faecal (red) microbial communities along the elevation gradient (represented with different shapes). The fungal microbiota of other vertebrates and invertebrates (shown in orange, blue, purple, etc), show less marked change over the same gradient

95 BIODIVERSITY, ECOLOGY AND ENVIRONMENT
Wolbachia evolution: exploring the bacterial infection most widespread across the insect world

The Wolbachia bacterium is one of the most abundant intracellular symbionts of nematodes, insects and other arthropods. In fact, it is estimated that about 40–60% of insect species are already infected with Wolbachia Nevertheless, the interactions with its insect hosts are mainly mutualistic rather than parasitic. Even though this bacterium has strong impacts on host biology, ecology and evolution, including manipulation of host reproduction in order to increase its own spreading, some host species cannot reproduce, or even survive, without Wolbachia infestation. For example, for many insects, Wolbachia is an essential bacterial symbiont that acts as a nutritional mutualist, providing vitamins and nutrients that are important for host survival and strengthening the host immune system. Our research at FEM focuses on expanding the number of available Wolbachia genomes, to create a detailed picture of the Wolbachia strain diversity and evolution, and how Wolbachia is spreading across different insect hosts. Together with scientists from the University of Trento we ex-
panded the number of known Wolbachia genomes by screening over 30,000 publicly available shotgun sequencing datasets from more than 500 host species with a main focus on insect hosts. By assembling over 1000 high quality genomes, we provided a large-scale collection of Wolbachia genomes that substantially increased host representation. We assembled many bacteria genomes for unrepresented species, including butterflies, bees, parasitoid wasps, and mites. Based on our large genome collection we created a huge phylogenetic tree that ultimately clarified some open questions concerning Wolbachia strain diversity and bacteria-host co-evolution. We showed that each insect species is represented by its own branch of bacteria strains in the Wolbachia tree, confirming a strong functional adaptation of the bacterium to a new host. Each host species carries its own specific Wolbachia strain, well adapted to the host insect. Our genome comparison revealed several bacterial gene functions that are required for infecting certain insect
96
MATTHIAS SCHOLZ
Phylogenetic tree of our large genome collection of Wolbachia bacteria originating from different insect host species
hosts and for inducing specific phenotypes. Understanding Wolbachia diversity, host switch and functional adaptation to new insect hosts is not only interesting from the evolutionary point of view, it also has strong practical relevance; for example,
infecting Anopheles mosquitoes permanently with a well adapted Wolbachia strain is promoted as a promising strategy for blocking the transmission of mosquito-borne diseases including malaria and dengue fever.
For a more detailed description, see: Nature Communications (2020) 11(1):5235. http://dx.doi.org/10.1038/s41467-020-19016-0

KEYWORDS: bacterial evolution, host-microbe interaction, bacterial host-switch
SPECIES: Wolbachia spp., Anopheles spp
Drought tolerance is a key topic in plant-environment interaction studies. The Arundo genus includes several grass species that are largely present in the European basin. Arundo donax is originally from Asia and widely distributed in Europe as an alien species or biomass crop. Conversely, Arundo donaciformis and Arundo plinii are autochthonous species in Europe and they can produce seed. However, their presence in Europe is significantly lower when compared to the alien Arundo donax
The objective of this study was to assess whether the degree of drought tolerance was associated with the different presence of these species in natural ecosystems and evaluate the degree of intraspecific variation for several drought-related traits.
Natural populations were sampled and they were subsequently grown under controlled-environment conditions. Different types of stresses, including water stress, were applied in several experiments. The phenotyping platform at the National Plant Phenomics Centre (UK) was used to
assess non-destructively key physiological traits for drought adaptation such as transpiration sensitivity to reduced water availability, biomass reduction under water stress via RGB imaging and estimation of the onset of senescence.
A significant conservative behaviour was observed in Arundo donax and Arundo donaciformis, potentially associated with an elevated sensitivity of stomata, early reduction in leaf area and limited senescence rate. Conversely, Arundo plinii displayed an overall non-conservative response to developing water stress. A significant intraspecific variation was observed in Arundo donax with a few ecotypes showing enhanced water stress tolerance.
Our work suggests that quick and marked responses to environmental changes (in particular developing water stress) may be beneficial under natural conditions where periods of intermittent showers require a careful use of the stored water available in the soil. Nevertheless, the intraspecific variation present in Arundo donax suggests the possibil-
97 BIODIVERSITY, ECOLOGY AND ENVIRONMENT
High throughput phenotyping highlights inter- and intra- specific variation in Arundo for water stress tolerance
MICHELE FARALLI MINGAI LI CLAUDIO VAROTTO
ity of selecting natural ecotypes for agronomic use with superior combinations of preferable traits for different environments. In conclusion,
our work stresses the importance of non-destructive phenotyping approaches for plant-environment interaction studies.

More info on Global Change Biology Bioenergy (2021) 13: 753-769. https://doi.org/10.1111/gcbb.12810

KEYWORDS: water limitation, giant cane, fenotyping SPECIES: Arundo donaciformis, Arundo plinii, Arundo donax

A possible mechanism for reducing heavy metal accumulation in crops discovered thanks a remote wild relative
Phytochelatin synthases (PCSs) are enzymes playing essential roles in detoxification of a broad range of heavy metals in plants. Despite the enzyme has been well characterised in angiosperms, its functional role and relevance in heavy metal detoxification in lineages of extant non-vascular land plants (bryophytes) has not been elucidated. As bryophytes diverged from the lineage originating vascular plants about 450 million years ago, the information gained from characterising
bryophyte PCS provides important clues on how the ancestor to all land plants coped with heavy metal toxicity and how this trait evolved. While PCS-like enzymes exist also in cyanobacteria, they are much shorter than land plant PCS, which sport a long C-Terminal domain possibly involved in enzymatic activity regulation. The details of such regulation are however still largely unknown. In an attempt to gain deeper insights into the function of PCS C-Terminal domain we
98
Arundo plants in the National Plant Phenomics Centre (UK) phenotyper
MINGAI LI CLAUDIO VAROTTO
isolated and characterised the PCS gene from the wild plant Marchantia polymorpha, a widely used model bryophyte species. The gene from M. polymorpha could complement by genetic transformation the mutation of the PCS1 gene of Arabidopsis thaliana, demonstrating that the role of PCS as a major player in heavy metal detoxification dates back to the colonisation of land by the plant kingdom. The functional characterization of site-directed mutations in the most conserved motifs of the PCS enzyme of M. polymorpha further uncovered two twin-cysteine motifs that repress enzyme activation by heavy metal exposure. This mechanism limits ex-
cessive activation of the enzyme by heavy metal exposure, which could otherwise cause a run-off production of phytochelatins with consequent depletion of glutathione, a fundamental reducing agent necessary to maintain redox homeostasis in plant cells. These findings are interesting as they highlight an ancestral function of the elusive PCS C-terminus in the regulation of enzyme activity. Therefore, they may be relevant for obtaining genome-edited crops with decreased root to shoot mobility of cadmium, thus preventing the accumulation of this hazardous heavy metal in the food chain and in food for human consumption.
More info on Journal of experimental Botany (2020) 71(20): 6655-6669. https://doi.org/10.1093/jxb/eraa386

KEYWORDS: heavy metals, phytochelatin synthase, bryophytes
SPECIES: Marchantia polymorpha, Arabidopsis thaliana

99 BIODIVERSITY, ECOLOGY AND ENVIRONMENT
The liverwort Marchantia polymorpha used to study the mechanisms of heavy metal detoxification in plants.
Arabidopsis plants overexpressing IspS from Arundo donax are more tolerant to drought stress and have better stomatal closer response to ABA
New elements towards understanding the role of isoprene emission in plant tolerance to environmental stresses
Isoprene is the most abundant single biogenic volatile organic compound (BVOC) emitted by plants. Despite the relevance of this molecule to plant abiotic resistance and its impact on global atmospheric chemistry, still relatively little is known about how isoprene makes plants more tolerant to heat, oxidative and drought stress.
The Ecogenomics Unit has been focusing on the dissection of different aspects of the molecular mechanisms underlying isoprene ability to confer drought tolerance by using the non isoprene-emitting model species Arabidopsis thaliana as a heterologous system for the overexpression of isoprene synthase (IspS). As IspS is the only gene responsible for isoprene biosynthesis in all natural plant emitters, with this approach we have been able to explore the natural variation in the enzymatic activity of IspS from different monocotyledonous species from the grass family of Poaceae and the tree family of Arecaceae (palms). The development of a high-throughput
screening method for isoprene emission based on PTR-ToF-MS carried out in collaboration with the Volatile Compounds Platform in FEM has been instrumental to the identification of highly emitting Arabidopsis thaliana plants transformed with IspS from different plant species. This, in turn, has allowed us to reliably identify the developmental and stress tolerance differences induced by the emission of isoprene with respect to control wild type Arabidopsis plants with a high level of accuracy. The results of this large-scale comparative effort indicate that isoprene affects abscisic acid (ABA) signalling at different tissue-specific, spatial, and temporal scales by enhancing stomatal sensitivity to ABA through upregulation of RD29B drought-related signalling gene. By contrast, in germinating seeds and roots isoprene decreased sensitivity to ABA, suggesting tissue-specific mechanisms of action. In leaves, isoprene caused enhanced tolerance to water-deprivation stress by downregulation of COR15A and P5CS

100
MINGAI LI ENRICO BARBARO CLAUDIO VAROTTO
genes, thus enhancing membrane integrity and tolerance to osmotic stress. By comparing isoprene emitting lines transformed with WT Arundo donax IspS to those transformed with a single amino acid IspS mutant causing the emission of ocimene we could demonstrate that water-stressed isoprene emitters had a water conservative behaviour and closed the stomata earlier than ocimene emitters, that displayed a

water non-conservative behaviour. These results suggest that isoprene mechanisms of action differ from those of other BVOCs in terms of water conservation and stress adaptation and that the development of genome edited and potentially more environmental friendly non-emitting crops like poplar, oil and date palms and eucalyptus may be associated with adaptive and productive tradeoffs.
More info on International Journal of Molecular Sciences 2020, 21(12), 4276. https://doi.org/10.3390/ijms21124276

KEYWORDS: biological isoprene, volatile compounds, drought stress, abiotic stress
SPECIE: Arundo donax, Arabidopsis thaliana
Metals and metalloids are natural components of the Earth’s crust, so the ability of plants to detoxify metals and metalloids resulting from natural processes of rock weathering is an ancient and widespread trait. Different species of land plants have evolved various degrees of the ability to tolerate potentially toxic elements to survive and grow in contaminated areas. In this research field, until now the study of metal and metalloid tolerance has mainly focused on angiosperms, whereas other plant clades
have been somewhat overlooked. Furthermore, recent studies have revealed the potential of bryophytes, pteridophytes and gymnosperms in environmental sciences, either as suitable indicators of habitat health and elemental pollution or as efficient tools for the reclamation of degraded soils and waters. However, very little is known about the bryophyte genes responsible for metal(loid) detoxification, a knowledge that could potentially provide novel tools for environmental monitoring applications.
The phytochelatin synthase knockout mutant in M. polymorpha may be applicable as a biondicator of Cd2+ pollution
101 BIODIVERSITY, ECOLOGY AND ENVIRONMENT
Bryophytes as emerging models of heavy metal accumulation, tolerance and detoxification mechanisms in plants
MINGAI LI CLAUDIO VAROTTO
The enzyme phytochelatin synthase (PCS) is responsible for the biosynthesis of phytochelatins (PCn), which are natural metal and metalloid chelators that play essential roles in heavy metal detoxification across the whole plant kingdom. By genetic transformation and genome editing with CRISPR/Cas9 (acronym for short palindromic repeats (CRISPR)/CRISPR 9-associated proteins), we obtained lines of the model bryophyte Marchantia polymorpha with de-regulated MpPCS gene activity. Additionally, MpPCS was also overexpressed in M. polymorpha to study its function in even more detail. The detailed genetic, biochemical
and physiological characterization of both loss- and gain-of-function lines provided evidence that MpPCS plays an essential role in the detoxification of cadmium (Cd2+), but not of arsenic (As3+) or other divalent metal cations in M. polymorpha. This indicates that the ability to detoxify Cd2+ is a plesiomorphic (that is, ancestral) and major function of PCS in all land plants. Hypersensitivity to cadmium further suggests that the Mppcs mutants could be potentially used as a highly specific, low-cost, bioindicator of Cd2+ pollution in the environment through direct visual assessment of plant growth and pigmentation.
More info on Journal of Hazardous Materials (2022) 440: 129844. https://doi.org/10.1016/j.jhazmat.2022.129844

KEYWORDS: phytochelatin synthase, breeding, bioindicator
SPECIES: Marcantia polymorpha

102
Memory drives the foraging behaviour of large wild mammals
The foraging decisions of roe deer are guided primarily by previous experience, not sensory perception alone, the researchers discovered. The cognitive processes underlying the foraging decisions of large mammals in nature are not well understood, in part because it has been difficult to disentangle the effects of sensory perception and memory on the animals’ movements. This question was examined by attaching GPSbased telemetry collars to 18 roe deer and tracking their movements during food manipulation, through a unique field experiment. More than 50 feeding sites, typically consisting of trays filled with corn, had been traditionally used by hunters throughout the study area. The authors placed wooden boards on top of the trays at popular feeding sites,
restricting access to the corn for two weeks, while the food and associated sensory cues such as smell were still present. The deer spent only 5% of the time at these manipulated sites during the closure period, compared to 31% of the time during the prior two weeks. The findings support a memory-based mathematical model of foraging behaviour, but not a perception-based model, which predicted no decrease in site visitation. Roe deer foraging decisions were based on recent experience of food location and accessibility enabling them to adapt to sudden changes in resource availability, effectively combining long term and short term spatial memory. Another study based on the same theoretical framework utilised the data from 17 roe deer reintroduced in Southern

103 BIODIVERSITY, ECOLOGY AND ENVIRONMENT
FRANCESCA CAGNACCI NATHAN RANC FEDERICO OSSI PAUL MOORCROFT*
* Harvard University, Cambridge, USA
Italy (Aspromonte National Park), where roe deer had been extirpated a century ago. Roe deer established “home ranges”, one of the most common space use patterns observed in the animal kingdom, by combining resource preference and spatial memory, fitting the predictions of a mathematical model developed by the researchers.
Understanding how animals respond to changing environmental conditions such as resource availability and how and why they choose the space to live in is critical to design effective wildlife conservation and management strategies. The studies are the result of a collaboration between Fondazione Edmund Mach and Harvard University.
More info on Proceedings of the National Academy of Sciences (2021) 118(15), e2014856118. https://doi.org/10.1073/pnas.2014856118
KEYWORDS: spatial memory, animal cognition, supplemental feeding sites

SPECIES: Capreolus capreolus
Ecological connectivity in the Alpine anthropic matrix. Natural reserves and corridors for the conservation of brown bear in the Alps
The Alps are one of the mountain areas with the highest human presence in the world. While some areas have experienced demographic decline due to depopulation, in recent years there has been a growth in visitors, particularly for outdoor recreation (e.g., sports activities and hiking), throughout the Alps. With an increasingly rich and widespread infrastructure network, accessibility to exurban natural areas has also increased in parallel. As a result of this increased frequentation of the mountains, several animal species, including bears, are adapting to coexist with humans. The AlpBearConnect project, a scientific collaboration with the University of Trento and Stelvio National Park, with support from MUSE and Settore Grandi Carnivori of the Autonomous Province of Trento, has shown that bears select, within their home ranges, areas where outdoor recreation is less intense. Although bears have a clear cognitive map of the territory in which they live and generally avoid
humans whenever possible, there are moments when individuals are particularly vulnerable to anthropogenic disturbance, particularly while resting or feeding. Quantifying the behavioural response of bears at these moments is important both to minimise human-bear encounters and to ensure animal welfare. Using GPS telemetry of 12 bears, it was possible to identify more than 500 daily resting sites scattered throughout the Province. Local intensity of recreational activities and environmental characteristics were measured for each site. It was observed that most resting sites were used during daylight hours, which is when disturbance is greatest. In addition, bears selected resting sites in areas with less human disturbance, more forest cover and less accessibility. Space use selection of bears was also examined in relation to areas with fruit richness (natural foraging areas) and human use of the trail network. It was observed that access to these
104
ANDREA CORRADINI LUCA PEDROTTI* CLARA TATTONI** MARCO CIOLLI*** FRANCESCA CAGNACCI
* Stelvio National Park, Bormio and Settore Grandi Carnivori, Autonomous Province of Trento, Italy
** Department of Theoretical and Applied Sciences, University of Insubria, Varese, Italy
*** Department of Civil, Environmental and Mechanical Engineering, University of Trento, Italy
is modulated by human presence, as bears avoid areas with high fruit richness if these are located in areas with high human use. Although this behaviour occurs throughout the year, it is particularly evident in the autumn period, when animals

require the greatest amount of calories (autumn hyperphagia phase). These results demonstrate how the spatio-temporal distribution and intensity of human disturbance influence the behaviour and space use of alpine bears.
More info on Biological Conservation (2021) 253, 108818. https://doi.org/10.1016/j.biocon.2020.108818

KEYWORDS: cumulative outdoor activity Index, human mobility, spatio-temporal risk avoidance
SPECIES: Ursus arctos
UNGULALPS project - An analysis of trophic relationships in an Alpine Ecosystem
In recent decades, anthropogenic modifications and climate change have profoundly reshaped the Alpine landscape. Mass tourism and increasing transportation threaten habitat connectivity, several nature protection laws were implemented, and open prairies and pastures for classical husbandry practices were largely replaced by forest cover. Consequently, the mammal communities inhabiting this changing landscape have also been affected. In particular, red deer (Cervus ela -
phus) populations have expanded substantially, potentially influencing the vegetation community and the interspecific relationships with other – often more specialised – ungulates like roe deer (Capreolus capreolus) or chamois (Rupicapra rupicapra). In addition, the concurrent wolf (Canis lupus) recolonisation of the Alps has the potential to trigger top-down effects throughout the entire ecosystem. In this dynamic context, the interactions between Alpine large herbivores, and between herbi -
LAURA LIMONCIELLO
NOEMI SQUILLACI
BENJAMIN ROBIRA
LUCA PEDROTTI*
LUANA BONTEMPO
HEIDI
FRANCESCA CAGNACCI
105 BIODIVERSITY, ECOLOGY AND ENVIRONMENT
CHARLOTTE VANDERLOCHT FEDERICO OSSI
ANDREA CORRADINI
SIMONE DAL FARRA
C. HAUFFE
* Stelvio National Park, Bormio and Settore Grandi Carnivori, Autonomous Province of Trento, Italy
vores and other trophic levels, e.g., carnivores, plants or microbiota, are still largely unexplored. The objective of this study is to understand the horizontal and vertical relationships of mountain ungulates, and to disentangle their drivers under different biotic, climatic and management contexts. Applying a multidisciplinary approach, the project aims to understand these functional relationships at the ecosystem and landscape levels (e.g. trophic cascades, microbiota, connectivity), at the community level (e.g. predation, herbivory), at the guild level (e.g. competition, niche partitioning) and at the population level (e.g. demography, movement behaviour). This is done through the acquisition of data from camera-traps, vegetation surveys, collection of soil, vegetation,
mammal faeces and hair samples. Camera-trap data are used to assess community composition, spatiotemporal activity and spatially explicit population demography. Faecal samples are used for molecular species identification, as well as characterization of diet (metabarcoding), and gut microbiota composition (metataxonomics); soil, vegetation and hair samples are used to track energy flow throughout the ecosystem using stable isotope analyses. Furthermore, GPS-collared red deer provide movement and connectivity data. This project will permit fundamental advances in community and movement ecology of Alpine large mammals, and serve as a benchmark methodological framework for other fragile systems across the Alpine range and beyond.
KEYWORDS: trophic cascades, mammal community, Alpine environment SPECIES: Cervus elaphus, Capreolus capreolus, Rupicapra rupicapra, Canis lupus

106
The tiger mosquito in Trentino: climate is no longer an obstacle!
In recent decades, several mosquito species from Asia have successfully colonised new regions far from their area of origin. This is the case, for example, of Aedes albopictus (the tiger mosquito) which has been present in the Province of Trento since the early 2000s, where it has permanently colonised the urban centres of all the valleys below 600 m a.s.l. The spread of the tiger mosquito, favoured by climate change, is the cause of serious social concerns due to the ectoparasitic activity of female mosquitoes searching for blood for the production of eggs. In fact, the biting intensity of this species often forces people to abandon their outdoor activities to seek shelter indoors. It also represents a potentially serious public health issue since this species has the capacity to transmit various pathogens when biting humans.
It is well known that temperature is a crucial factor influencing mosquito biology. Therefore, we conducted experiments to understand whether the tiger mosquito has adapted to the climatic conditions of this prov-
ince (colder than its country of origin), and compared obtained results with known data for mosquitoes present in sub-tropical areas. The experiments were conducted at Fondazione Edmund Mach in the climate-controlled cabinets of the new insectarium using specimens raised in the colony established in 2018 from eggs collected in Trentino. We found that immature stages such as eggs and larvae were well adapted to cold conditions, similar to those typically experienced in spring. For example, we have seen that even at 10°C the larvae from Trentino are able to survive, unlike the sub-tropical ones. At 15°C, 73% of the larvae of our local population reached the adult stage against 50% of the sub-tropical population. Adult longevity and fecundity are substantially greater in mild conditions, characterising typical Trentino summers. This thermal adaptation could increase the length of the breeding season in Trentino and allow the colonisation of areas at higher altitude, resulting in an increased overall risk of potential pathogen transmission.
More info on Insects (2020) 11(11), 808. https://doi.org/10.3390/insects11110808

KEYWORDS: mosquitoes, invasive species, climate change SPECIES: Aedes albopictus

107 BIODIVERSITY, ECOLOGY AND ENVIRONMENT
GIOVANNI MARINI DANIELE ARNOLDI ENRICO INAMA FRANCESCA DAGOSTIN FAUSTA ROSSO VALENTINA TAGLIAPIETRA MATTIA MANICA ROBERTO ROSÀ* ANNAPAOLA RIZZOLI
* Center Agriculture Food Environment, University of Trento, Italy
Aedes albopictus
The gut microbiota of invasive species may indicate invasion capabilities and identify new biological control methods
This innovative research focused on the analysis of the intestinal microbiota of the invasive mosquitoes
Aedes albopictus (the tiger mosquito) and Aedes koreicus. The microbiota, or the community of bacteria that inhabits the intestinal tract, is particularly studied in insects for its proven influence on the physiological mechanisms of metabolism, reproduction and digestion. In addition, pathogens (such as viruses), ingested with the blood meal of insect vectors, interact with the intestinal wall and, consequently, with gut bacteria. Thus, bacterial microbiota could hinder or favour the replication of the pathogen and subsequent transmission.
Knowing more about this microbial community, how they colonise the insect and their role in insect biology

could suggest how the vector and/ or pathogens could be controlled. In addition, gut microbiota diversity can be considered an index of the insect’s fitness and its adaptation to a new environment.
This pilot study used a limited number of both mosquito species taken from various sites in Trentino. Using the DNA extracted from the middle intestine to perform next generation sequencing analysis (NGS), it was possible to identify the main taxa of bacteria present. We found that at least 60% of the bacterial community was composed of Pseudomonas (ubiquitous gram-negative bacteria) followed by less common families of bacteria (such as Rickettsiacee and Enterobatteraceae). However, the microbiota of the tiger mosquito was richer in genera than that of the Ko -
108
FAUSTA ROSSO
DAVIDE
DANIELE
CLAUDIO DONATI MASSIMO PINDO ANNAPAOLA RIZZOLI
VALENTINA TAGLIAPIETRA NICCOLÒ
ALFANO
ALBANESE
ARNOLDI
Ae. koreicus midgut after dissection (24x)
(photo: Daniele Arnoldi)
rean mosquito, possibly demonstrating a greater difficulty of the latter in adapting to Trentino.
A more detailed investigation of A. koreicus at various stages of development (larvae, pupae and adults)
highlighted the predominance of a bacterium (Asaia spp.), indicated in the literature as a promising candidate for the development of new biological control methods of these mosquitoes.
More info on Scientific reports (2018), 8(1), 16091. https://doi.org/10.1038/s41598-018-34640-z
KEYWORDS: microbiota, mosquitoes

SPECIES: Aedes albopictus, Aedes koreicus
Small mammals in a changing world

Species communities and demography are governed by both intrinsic and extrinsic factors, as well as interspecific interactions; however, these processes have rarely been investigated simultaneously in natural systems within an eco-epidemiological framework.
By implementing a multi-factorial approach, we assessed the responses
of small mammals to environmental, climatic and anthropic factors, and the cascading implications on parasitic load and circulation of common and emergent pathogens. For this research, live-trapping of small mammals (rodents and insectivores) was performed across a wide latitudinal (Norway and Italy) and altitudinal (500-2500 m a.s.l.) gradient, through
DANIELE ARNOLDI
ENRICO INAMA
FEDERICO OSSI
ANNAPAOLA RIZZOLI FRANCESCA CAGNACCI
VALENTINA TAGLIAPIETRA
109 BIODIVERSITY, ECOLOGY AND ENVIRONMENT
GIULIA FERRARI OLIVIER DEVINEAU* FAUSTA ROSSO MATTEO GIRARDI
* Inland Norway University of Applied Sciences, Norway
C. nivalis in Val Calamento (photo: Simone Dal Farra)
VALENTINA TAGLIAPIETRA
FRANCESCA DAGOSTIN
GIULIA FERRARI
DANIELE ARNOLDI
ENRICO INAMA
FAUSTA ROSSO
GIOVANNI MARINI
ANTONELLA CRISTOFORI
FABIANA CRISTOFOLINI
ELENA GOTTARDINI
ANNAPAOLA RIZZOLI
experimental food manipulation (at roe deer artificial feeding sites) and longitudinal transects across heterogeneous habitats. We found that small mammal survival depended on intrinsic seasonal cycles and was enhanced by food availability only under harsh climate conditions, while population size was mainly constrained by climate and food availability. When woodland mice and voles were sympatric, they showed opposite demographic trends in presence of food, with subordinate voles having decreased survival and population size. Additionally, when explicitly considering spatial components of these patterns, we found that at supplemental feeding sites, which are selected by roe deer more than other sites, rodents decreased their space-use, while the local density of mice, but not voles, increased. Although tick burden was not affected by feeding sites, the spatial pattern of rodentand vector-borne pathogens occur-
rence varied with roe deer feeding sites. Beyond this, the community composition and altitudinal distribution of hosts and vectors could be also affected by climate. Accordingly, we also detected the occurrence of generalist bank vole at high altitudes, in sympatry with the climate-specialist snow vole. This upward distributional shift of generalist species might have consequences for the spread of ticks and pathogens. Indeed, we found an altitudinal segregation of tick species, also reflected in rodentand vector-borne pathogens. Among these, we also recorded for the first time in Alpine rodents some protozoans that may play an important epidemiological role along the food web. In conclusion, in this study we showed the impacts of climate and anthropic disturbance on host populations and communities, and parasite load and distribution, highlighting the possible consequences on human and ecosystem health.
More info at https://hdl.handle.net/11250/3013610

KEYWORDS: small mammals, host-vector-pathogen dynamics, One Health
SPECIES: Chionomys nivalis, Myodes glareolus, Apodemus spp., Ixodes ricinus, Ixodes trianguliceps, Capreolus capreolus
Climate changes and emerging diseases: the case of tick-borne encephalitis (TBE) in Europe
Current changes of anthropic origin, such as climate change, play a pivotal role in the emergence of tick-borne diseases, affecting the spread and demographic patterns of ticks and their pathogens. In Europe, one of the most common tick species of both medical and veterinary importance is Ixodes ricinus, a competent vector of several zoonotic agents including protozoa, bacteria and viruses. Among viruses, the most relevant is the agent of tick-borne encephalitis
(TBE), which is transmitted to humans through the bite of infected ticks or unpasteurized milk and milk products, and can cause severe neurological symptoms with long-term consequences, including death. TBE incidence in Europe is rising in both endemic and new regions, posing an increasing threat to public health. In Trentino, the number of cases has risen despite the vaccination, and new foci of viral circulation have been identified. The geolocation of the ar-
110
eas with the highest risk of TBE is a challenge, as the ecological factors involved in the TBE transmission cycle interact in a complex way. Our research aimed at disentangling some of these aspects in order to better predict the hazard and provide public health authorities with early warning indicators in the current context of global changes.
We found that climatic factors, such as the precipitation of the driest months and the mean temperature in winter, have a strong impact on the variation of TBE across Europe. From an ecological perspective, regions with low levels of biodiversity were associated with higher TBE risk. These patterns were confirmed also through other empirical studies. Specifically, a study focused on a long-term study site in Trento province found that TBEv maintenance was related with the number of co-feeding ticks carried by rodents, which in turn was negatively correlated with the autumnal
cooling rate and increased with tick burden on rodents, as well as deer and rodent abundance. Therefore, a specific combination of climatic conditions and certain rodent and deer densities resulted in the principal determinants of TBEv circulation. Similarly, another study highlighted the relationship between TBE cases in the Province of Trento and air pollen abundance measured at FEM, as a proxy for seed production. We confirmed the pivotal role of rodent densities as amplifying hosts, driven by availability of seeds and thus, by pollen quantities. Overall, our findings shed light on the complex ecological factors driving microbial hazard. These results will be used to inform a high-resolution predictive model aimed at assessing the risk of TBEv infections across Europe, which is currently under development and will help decision-makers to implement surveillance and prevention campaigns in potential risk areas, Trentino included.
More info on International Journal for Parasitology (2019) 49 (10), 779-787. https://doi.org/10.1016/j.ijpara.2019.05.006

KEYWORDS: tick-borne encephalitis, One Health, climate change SPECIES: Ixodes ricinus

111 BIODIVERSITY, ECOLOGY AND ENVIRONMENT
Ticks (Ixodes ricinus) feeding on a bank vole (Myodes glareolus)


COMPUTATIONAL BIOLOGY
Metagenomics identifies previously unknown ancient bacterial lineages

Every environment on Earth, even the ones presenting the harshest conditions, is colonised by complex microbial communities. Microbes - bacteria, archaea and fungi - are by far the most diverse and widespread form of life. Thanks to new and powerful sequencing technologies, it is now possible to characterise the composition of microbial communities and recover complete genomes from the sequencing of the microbiota. We have used metagenomic sequencing to characterise the bacterial species that form Cryptoendolithic communities, microbial ecosystems dwelling inside porous rocks that are able to persist at the edge of the biological potential for life in the ice-free areas of the Antarctic desert. These regions include the McMurdo Dry Valleys, often accounted as the closest terres-
trial counterpart of the Martian environment and thought to be devoid of life until the discovery of these cryptic life-forms. We generated the first metagenomes from rocks collected in Continental Antarctica over a distance of about 350 km along an altitudinal transect from 834 up to 3100 m above sea level. A total of 497 draft bacterial genome sequences were assembled and clustered into 269 candidate new species. The majority of these species belong to monophyletic bacterial clades that diverged from related taxa in a range from 1.2 billion to 410 Ma and are functionally distinct from known related taxa. Our findings significantly increase the repertoire of genomic data for several taxa and, to date, represent the first example of bacterial genomes recovered from endolithic commu-
114
DAVIDE ALBANESE CLAUDIO DONATI
nities. Their ancient origin seems to not be related to the geological history of the continent, rather they may represent evolutionary remnants of pristine clades that evolved across
the Tonian glaciation. These unique genomic resources will underpin future studies on the structure, evolution, and function of the ecosystems at the edge of life.

More information on Microbiome (2021) 9, 63. https://doi.org/10.1186/s40168-021-01021-0
KEYWORDS: sequencing, microbiome

115 COMPUTATIONAL BIOLOGY
an ever-expanding transcriptomic resource for grapevine

The problem of data integration concerns merging data coming from several sources while providing the user with a unique way to access and retrieve them. With the advent of high-throughput technologies, there has been a considerable expansion in the production of gene expression datasets for many studied organisms. Grapevine is no exception, with an escalating number of experiments being conducted over the past decade. Such a wealth of public information poses a challenging task when it comes to data integration since the end goal is analysing gene expression data in the broader context of all available measurements, all from a single point of access.
In its second major release, VESPUCCI, the integrated database of gene
expression data for grapevine, has been updated to be FAIR-compliant, employing standards and created with open-source technologies. It includes all public grapevine gene expression experiments from both microarray and RNA-seq platforms. Expression values are normalised using different methodologies to flexibly satisfy different analysis requirements. Sample annotations are manually curated and use standard formats and ontologies. The updated version of VESPUCCI provides a newly developed application programming interface, called COMPASS, to analyse and query the database through the GraphQL query language. Moreover, several tools have been developed to allow the seamless integration of VESPUCCI datasets in any analysis workflow.
116
VESPUCCI:
MARCO MORETTO PAOLO SONEGO STEFANIA PILATI LAURA COSTANTINI GIULIA MALACARNE
VESPUCCI offers the opportunity to explore the entire transcriptomic landscape in grapevine, showing the major Vitis species and cultivar of interest as well as all of the growing conditions, biotic and abiotic stresses

studied during the years and present in literature. It also highlights the peculiarities and limitations of different normalisation techniques, providing clear indications on whether one technique is to be preferred to the others.
More info on Frontiers in Plant Science (2022) 13. https://doi.org/10.3389%2Ffpls.2022.815443
KEYWORDS: gene expression, grapevine, transcriptomics, FAIR
SPECIES: Vitis vinifera
Microbial communities in agricultural soils are fundamental for plant growth and in vineyard ecosystems contribute to defining regional wine quality. A better understanding of the ecological processes that regulate soil microbiome across taxo -
nomic groups, spatial scales, and through time can help manage soil microbes towards beneficial outcomes. Here, we used statistical modelling and molecular techniques (16S and ITS sequencing) in the soil of an emblematic wine-growing re -
STEFANO LARSEN
DAVIDE ALBANESE
JAMES STEGEN*
PIETRO FRANCESCHI
EMANUELA COLLER**
ROBERTO ZANZOTTI**
CLAUDIO IORIATTI**
ERIKA STEFANI
MASSIMO PINDO
ALESSANDRO CESTARO
CLAUDIO DONATI
* Pacific Northwest National Laboratory, USA
** Technology Transfer Centre, Fondazione Edmund Mach, Italy

117 COMPUTATIONAL BIOLOGY
Bacterial and fungal communities in the soil are regulated by distinct ecological processes that are stable through time
gion of Trentino (Italy) to quantify how fungal and bacterial biodiversity is shaped by differences in the ecological niche of the species and by processes related to the stochastic dispersal of microbial cells across locations.
We found that the two taxonomic groups were regulated by distinct ecological mechanisms. In particular, bacterial communities appeared more strongly regulated by so-called selection processes linked to the niche of the species and the effect of the environment; conversely, the
distribution fungi was more stochastic and reflected the limited ability of larger fungal cells to freely disperse across spatially separated locations. Indeed, the estimated dispersal rate was almost two orders-of-magnitude lower for fungi than bacteria. These patterns were consistent across the two years of observations. Overall, these findings indicate that managing microbes in vineyard soils could thus benefit from strategies that account for dispersal limitation of fungi and the importance of environmental conditions for bacteria.
More information on Microbial Ecology (2022).
https://doi.org/10.1007/s00248-022-02065-x

KEYWORDS: microbiome, beta-diversity, spatial scales
Nanopores at the DNA sequencing facility
The technological equipment of the Sequencing platform of Fondazione Edmund Mach has been enriched with a new tool for DNA sequencing: the nanopore sequencer from Oxford Nanopore Technology (ONT).
The operating principle of this instrument is conceptually very simple. There are two solutions with different concentrations of salt ions separated by a membrane; the ions, due to the different concentration, pass through

118
ALESSANDRO CESTARO
the membrane at special channel proteins called ‘nanopores’. When DNA passes through the pores, the flow of ions is interrupted with different speeds and intensities depending on the nucleotide sequence that passes through the pore. By measuring how the ion current varies, it is possible to identify which DNA sequence is passing through the nanopore.
The process of deducing the sequence based on the potential difference over time is called ‘basecalling’, an operation that requires special hardware, the same type of hardware
KEYWORDS: nanopore, sequencing, genomics
used in cryptocurrency mining. Physically, however, ONT sequencers are very small and can be used directly in the field, representing a true revolution in the field of molecular biology. Researchers at FEM have already successfully used these tools by participating in the international project to sequence the lemon tree genome, the all-Italian project to sequence the chestnut genome, and also contributing to a project on exobiology conducted on the International Space Station (ISS) on the photosynthetic bacteria Chroococcidiopsis

119 COMPUTATIONAL BIOLOGY
120 KEYWORDS abiotic stress 21, 100 agrifood 54 agro-environmental properties 52 allergy 83 Alpine environment 84, 87, 105 Apine forests 86 American grapevine leafhopper 41 animal cognition 103 App 48 apple scab 27 apple 20, 38, 58 apples (fruit) 63 Arduino 47 bacterial evolution 96 bacterial host-switch 96 bacteriophage 59 bark beetle 87 behavioural manipulation 41 beta-diversity 117 biodiversity 84, 89, 91 bioeconomy 54 biofungicides 43 bioindicator 101 biological isoprene 100 biomonitoring 86 biosynthesis 58 black rot 31, 33 blueberry 34, 35, 37 breeding 31, 33, 37, 101 brown marmorated stink bug 41, 42 bryophytes 98 caciotta-like cheese 72 chestnut array 24 climate change 78, 88, 107, 110 clone comparison 29 co-composting 52 COP-15 89 crop protection 41, 43 crop water stress index 49 cumulative outdoor activity Index 104 data 48 defence genes 16 digital agriculture 46, 48 dihydrochalcones 58 disease control 43 dormancy 38 downy mildew 30, 33, 40 drought stress 100 eating habits 74 education 74 endangered species 92 energy 54 environmental DNA 91 European common frog 91 White-clawed freshwater crayfish 79 FAIR 116 fall migration 71 fenotyping 97 fermentation 65 fertilization 28 fire blight 20 food biotechnologies 65 food choices 69 food loss and waste 67 food neophobia 69 food quality 67 fruit development 29 fungal diseases 16 gene editing 17 gene expression 116 genetic diversity 89 genetic introgression 92 genetic transformation 27 genome 24, 25 genomics 118 geographical origin 73 giant cane 97 grape 33 grapevine 21, 40, 116 greenhouse gases 88 greenhouse whitefly 41 gut microbiota 62, 63 Habitats Directive 79 heavy metals 98 High Performance Computing 87 host-microbe interaction 96 host-vector-pathogen dynamics 109 human mobility 104 hydrochar 52 ice cover 78 in situ conservation 79 in vitro culture 34 inflammation 62 Internet of Things 46, 49, 86 invasive species 79, 80, 107 isotopes 71, 73
121 KEYWORDS lactic acid bacteria 72 Lake Garda 80 lightstrike 65 liking 69 LTER site Lake Tovel 78 MADS-box gene 38 mammal community 105 Mediterranean diet 74 metabolomics 60 metataxonomy 94 microbial communities 65 microbial ecology 94 microbiome 114, 116 microbiota 108 microfluidics 17 mitochondrial COI 80 mosquitoes 107, 108 mugwort 83 nanopore 118 natural mutations 30 natural whey starter 59 nutrition 62, 63 obesity 62 olive oil 70, 73 olive 28 One Health 109, 110 organic fertilisers 51 passerine birds 71 permafrost 82, 88 phenology 47 phytochelatin synthase 98, 101 plant microbiome 45 plant resistance induction 45 pollen 83,84 polyphenols 72 post-harvest 23, 35 powdery mildew 33 propagation 34 quality 35 Raspberry Pi 47 raspberry 37 regulatory gene network 19 remote sensing 87 resistance genes 27, 31 resistance varieties 33 RNA interference 40 rock glaciers 82 samurai wasp 42 seedlessness 29 sensory analysis 70 sequencing 24, 114, 118 shelf life 65 small mammals 109 smart vineyard 46 soil fertility 51 soil organic matter 51 spatial memory 103 spatial scales 117 spatio-temporal risk avoidance 104 spotted-wing drosophila 42 stress mitigation 45 superficial scald 23 supplemental breeding 92 supplemental feeding sites 103 susceptibility genes 30 sustainability 67 system biology 19 TEA 20, 21 thermal imaging 49 tick-borne encephalitis 110 transcriptomics 19, 116 Trentingrana 59 trophic cascades 105 tryptophan metabolism 62 varietal compounds 65 varietal identification 25, 28 vibrational signals 41 volatile compounds 70, 100 walnuts 25 water limitation 97 water resources 82 wild species 89 wildlife 94 wine 60, 65
122
Abies alba 86 Aedes albopictus 107, 108 Aedes koreicus 108 Agrobacterium tumefaciens 20 Anopheles spp. 96 Apodemus spp. 109 Arabidopsis thaliana 98, 100 Artemisia annua 83 Artemisia verlotiorum 83 Artemisia vulgaris 83 Arundo donaciformis 97 Arundo donax 97, 100 Arundo plinii 97 Austropotamobius pallipes 79 Canis lupus 105 Capreolus capreolus 103, 105, 109 Castanea sativa 24 Cervus elaphus 105 Chionomys nivalis 109 Cornus mas 72 Dreissena bugensis 80 Dreissena polymorpha 80 Drosophila suzukii 42 Erwinia amylovora 20 Erysiphe necator 33 Fagus sylvatica 86 Faxonius limosus 79 Ganaspis brasiliensis 42 Guignardia bidwellii 31, 33 Halyomorpha halys 41, 42 Ips typographus 87 Ixodes ricinus 109, 110 Ixodes trianguliceps 109 Juglans regia 25 Lactobacillus brevis 59 Lactobacillus helveticus 59 Leptopilina japonica 42 Malus domestica 20, 23, 27, 38, 45, 63 Malus spp. 58 Marchantia polymorpha 98, 101 Myodes glareolus 109 Olea europaea 28 Picea abies 86 Plasmopara viticola 30, 33, 40, 43 Procambarus clarkii 79 Rana temporaria 91 Ribes nigrum 72 Rubus idaeus 37 Rupicapra rupicapra 105 Salmo marmoratus 92 Scaphoideus titanus 41 Trialeurodes vaporariorum 41 Trissolcus japonicus 42 Trissolcus mitsukurii 42 Ursus arctos 104 Vaccinium corymbosum 37 Vaccinium spp. 34, 35, 37 Venturia inaequalis 27 Vitis spp. 21, 30, 31 Vitis vinifera 16, 29, 33, 40, 43, 116 Wolbachia spp. 96
SPECIES
Printed in May 2023 by La Grafica, Mori (TN)



















































































 ELENA FRANCIOSI ANDREA MANCINI
ELENA FRANCIOSI ANDREA MANCINI